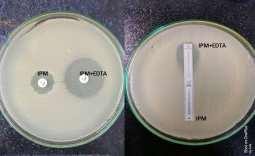

![]()











































Chronic Kidney Disease (CKD) is one of those diseases that may change the present trend in the healthcare system in future not so far. Being a relentlessly progressive disease, there is no cure. Diabetes and hypertension being the two most prevalent contributors, the burden of CKD is rising as a clow epidemic. Presently more than 10% of the world’s population is suffering from CKD. Since 1990, there has been a 23% increase in prevalence and a 45% increase in mortality contributed by this disease.The scenario is worsein lower- and middle-income countries(LMIC). In India, the prevalence reported in various regions are variable ranging from 1% to 13%. Recently, data from the International Society of Nephrology’s Kidney Disease Data Centre Study reported a prevalence of 17% in India.
The treatment of End stage or Stage V kidney disease or Kidney failure is renal replacement therapy. Hemodialysis is the most common modality of renal replacement therapy. However, the situation is dismal in LMICs. In India, over 90% of patients requiring RRT die because of inability to afford care and even in those who do start RRT, 60% stop for financial reasons.
The role of Renal transplantation as a permanent solution to this problem is encouraging. The actual scenario is howeverextremely non assuring. Out of almost 2 lakh new patients started on dialysis only 5,000 to 10,000 people received an organ. The average waiting period for a patient even in USA is three to five years.
To improve the overall outcome in Ens Stage Kidney Disease (ESKD), the concept of an artificial kidney started to be in vogue. This bioartificial kidney was conceptualized as a universal donor, wearable filtration device designed for mass production and use.
Only portability of the dialysis machine was not going solve the question. During covid times many commercially available portable home dialysis machine came into use. They failed to change the dialysis pattern of our society because of limited availability, cost and technical requirements. As compared tothese Portable Artificial Kidneys (PAK), weighing between 8 to 10 kgs, the next generation Wearable Artificial Kidneys (WAK) weighed less, 5 to 6 kgs but had to be worn outside the body in a belt. The problem with WAK was a power source, dialysate regeneration system access and anticoagulation.Most of the WAK devices performed peritoneal dialysis.
In most of these designs the challenge of regeneration of spent dialysate was achieved through a sorbent-based system, the most used being Recirculating Dialysis (REDY) sorbent system. Uremic toxins are removed from dialysate using activated charcoal , cation and anion exchange sorbents. The most difficult part was urea removal. This was achieved by column-fixed urease enzyme.
The next phase of development of an artificial kidney was development of a Renal Assist Device (RAD) which is cultured human proximal tubular epithelial cell coated hollow fibre dialyzers replicating the secretory and absorptive functions of human renal tubules. This model was developed by Humes in US and Saito in Japan developing a extracorporeal artificial kidney.
The latest development in this field was done by the pioneering research from Dr Shuvo Roy of University of California and Dr William H Fissellfrom Vanderbilt university. Their research has led the path towards first implantable Bioartificial Kidney (iBAK) . Developed on the scaffold of silicone nanopore membrane, the used cultured conditionally immortalized proximal tubular epithelial cells. This device would be implanted in the iliac fossa and anastomosed to the iliac vessels for blood flow and to the bladder or ureter.
These devices undergoing animal trials were placed like a renal transplantation without the requirement of immunosuppressive therapy. It used the same dialysate regeneration system of previous models.
Bioengineered living membrane : Human conditionally immortalized PTEC ( ciPTEC) has been
developed which are enriched in influx and efflux transporters. These cells when cultured on hollow tubes in presence of albumin demonstrated clearance of protein bound uremic toxins.
While still a long way, this iBAK device is the closest to what we have gone to an ideal bioartificial kidney. The research is ongoing, the funding still is an issue.We hope that this conceptually correct model will ultimately solve the much sought-after solution of organ crisis.
Summary : Ideal renal replacement therapy must address few issues. First comes the removal of uremic toxins and maintain euvolemia with maintaining acid base balance and physiological electrolyte concentration. Secondly performing metabolic function of kidney by maintaining bonemineral homeostasis and anemia correction. First function can be addressed by in center hemodialysis. But for convenience it was miniatured to PAK and later WAK. All these technologies failed to perform metabolic functions of kidney. This issue will be addressed in BAK and iRAD. All these uses Bioartificial Renal Epithelial Cell System (BRECS). It is Cryopreservable on-demand cell therapy delivery system. Progenitor stem cells are placed on high density porous disks and later seeded on to the fiber of hemofilter. iRAD contains Micro-Electro Mechanical System (MEMS) with Hemofilter with Silicon Nanopore Membrane seeded with renal tubule cell bioreactor (BRECS) with Immune isolation process.
In conclusion with improvement of tissue engineering and material science artificial kidney is ever evolving with promising future.
Hony Editor, JIMA Sanjoy Banerjee
Shanoon Sharaf Ali1 , Shailaja S Patil2
Background : It is estimated that about 40% of the Indian population is infected with TB bacteria, the vast majority of whom have latent TB rather than TB Disease. Indoor Air Pollution is a recognized risk factor for TB Disease. Providing clean air was a treatment used in the pre-antibiotic era. This is now overlooked. Addressing environmental factors in TB treatment is challenging but a major determinant of the Quality of Life and speedy recovery of TB Patients.
Aims and Objectives : Our study aims to assess Indoor Air Pollution exposure among TB Patients. To assess the prevalence of Indoor Air Pollution sources among TB Households.
Materials and Methods : A cross-sectional study among TB patients of Vijayapura District from May, 2023 to July, 2023. In 119 TB Patients were selected by probability proportional to size sampling method from 5 TUs which was selected by Random sampling method. Data was obtained by house-to-house visits using a semi-structured questionnaire, which was subsequently entered into Excel. Data was analysed using SPSS V.26.
Results : More than 80% of the households belonged to BPL Category. 90% of the study households did not have cross-ventilation and it was statistically associated with level of Education. 63% of the houses did not have separate kitchens with smoke vents and it was statistically associated with Economic class. 58.8% of households had overcrowding and 86.6% had any sources of Indoor Air Pollution in the house.
Conclusion : Indoor Air Pollution is common in TB households and has been identified as a risk factor for TB mortality and morbidity As the government has attempted to address nutrition through food baskets and the Nikshay Poshan Yojana, we should endeavour to implement measures that address Indoor Air Pollution. We should stimulate research into realistic practical remedies for Indoor Air Pollution among TB patients.
[J Indian Med Assoc 2024; 122(9): 13-6]
Key words : Indoor Air Pollution, TB Households, Environmental Factors.
Tuberculosis is a leading cause of morbidity and mortality, especially in low-income and middleincome countries. India has the highest burden of Tuberculosis Infection (TBI) globally, with nearly 3540 crore1, of which an estimated 26 lakh are likely to develop active TB. It is estimated that about 40% of the Indian population is infected with TB bacteria, most of whom have latentTB rather than TB Disease2
Many factors are shown to increase the risk of activation from latent TB infection to clinically manifested active TB and its severity, including host immunity, exposure to smear-positive pulmonary TB patients, malnutrition and socio-economic and environmental exposure and risk behaviour (eg, smoking, alcohol consumption, sexual behaviour)3 .
Air pollution is of particular interest among environmental risk factors, not only because air pollutants, such as Particulate Matter (PM), can serve as carriers of airborne Mycobacterium but also
Department of Community Medicine, BLDE, Shri B M Patil Medical College, Karnataka 586103
1MBBS, Junior Resident
2MBBS, MD, Professor and Corresponding Author
Received on : 31/10/2023
Accepted on : 28/11/2023
Editor's Comment :
nn nn n IndoorAir Pollution presents a major health risk in households affected by TB, particularly in rural areas.
nn n This study showed that, 90% of the households lacked proper cross ventilation, 87% regularly used mosquito coils, incense sticks, dhoop/camphor and 70% of these households still used wood for cooking and heating water for bathing.
nn n Raising awareness about these common indoor air pollutants and promoting Ventilation measures need to be focussed as one of the important preventive measure to reduce TB and other airborne diseases transmission.
because it affects lung immunity by inducing oxidative stress and inflammation and impairs the host’s immunity4 Although the mechanism of TB activation from air pollution is not fully understood, it has been proposed that air pollution affects TB activation by altering the lung immunity of the host due to chronic oxidative stress followed by inflammation5. Recent literature also shows that air pollution can cause carbon accumulation in the bronchial tree, which increases the risk of TB by inactivating pulmonary macrophages6
WHO End Tuberculosis Strategy7 recommends combining biomedical interventions with policies on social protection and action on other determinants. Indoor Air Pollution is a recognized risk factor for TB
No 09, September
Disease and can accelerate the progression of latent TB infections to TB Disease. In the pre-antibiotic age, providing clean air was a treatment8 This is now overlooked. Hermann Brehmer was a German physician who opened the first sanatorium specifically dedicated to treating this disease9 Addressing environmental factors in TB treatment is challenging but a major determinant of the Quality of Life and speedy recovery of TB Patients.
In this study, we aimed to assess the exposure of sources for Indoor Air Pollution among TB patients. We also aimed to assess the ventilation and overcrowding status of the TB Households.
MATERIALS AND METHODS
Study Area : Northern Karnataka District.
Study Population: Households of Bacteriologically confirmed Pulmonary TB cases.
Study Period : April, 2023 to July, 2024.
Study Design : Cross-sectional survey
Study Technique :
A cross-sectional survey using a semi-structured questionnaire was conducted through in-person interviews in the households of bacteriologically confirmed pulmonary TB cases after acquiring ethical clearance from the Institutional Ethics Committee.All questionaries were made in English and then translated into the local language (Kannada) and administered after pilot testing. The questionnaire included Socio-demographic variables of the Household (HH) and variables to assess sources of Indoor Air Pollution. The head of the household or any adult male/ female in the household was interviewed after taking informed consent (Table 1).
Sample size :
With the anticipated proportion of burning incense of 76%10 , the study would require a sample size of 110 (Minimum) TB patients with a 95% level of confidence and 8% absolute precision.
Formula used :
n = z2 p*q
d2
Where Z = Z statistic at α level of significance
d2 = Absolute error
P = Proportion rate
q = 100-p
Dropout rate of 5% = 110+6=116
Sampling Technique:
Out of the 10 TB units in the district, five (5) units was selected using a simple random sampling method (lottery method). TB patients (Bacteriologically confirmed Pulmonary TB) was selected from sampled TB units using the probability proportional to size
Table 1 — Socio-demographic Characteristics
sampling method to get a good representation till the estimated sample size is reached.
Inclusion Criteria :
• All Households of Bacteriologically confirmed Pulmonary TB cases registered in the previous six months (Table 2).
Exclusion Criteria :
• All HHCs of MDR TB cases and HHs where no consent is given.
Operational Definition :
Bacteriologically confirmed Pulmonary TB case: TB diagnosed in a biological specimen by smear microscopy, culture, or a WHO-endorsed rapid molecular test and adopted by NTEP such as expert MTB/RIF®/TrueNat®
Statistical Analysis :
(1) The data obtained was entered into a Microsoft Excel sheet and statistical analysis was performed using SPSS V.26.
(2) Association between Categorical variables will be compared using the Chi-square test.
(3) P<0.05 was considered statistically significant. All statistical tests were performed two-tailed.
Table 2 — Household Characteristics
A total of 119 TB Patients were recruited and enrolled in the study. 52 % of the study participants were among the 18-39 age group. 78.2% of them were Hindu by Religion and 63.9% belonged to OBC Caste. More than 50% of the participants belonged to class 3 or less according to modified B G Prasad Scale 2022.
87.4% of TB Patients lived in their own houses and 42% had mixed type of housing. More than 80% of the households belonged to BPL Category. 90% of the study households did not have cross-ventilation and it was statistically associated with level of Education. 63% of the houses did not have separate kitchens with smoke vents and it was statistically associated with Economic class. 58.8% of households had over-crowding.
LPG and Wood were the only types of cooking fuel among 30% and 17.6% respectively All others used wood along with LPG. Kerosene was not at all used among the study households. Only 4 (3.4%) households reported smoking inside the House.
86.6% had a history of daily usage of Mosquito Coils, Incense Sticks, Camphor etc.The presence of any one among them was considered positive. 30.3% of the houses had dampness and 90.8% of them reported that they do not burn waste near their house (Tables 3&4).
Table 3 — Sources of IAP
*Presence of any one of the sources was considered as ‘Yes’
More than 50% of the participants belonging to Socio-economic class 3 or less have shown that India still faces the issue of TB among the Poor Socioeconomic class. Previous studies have shown a higher prevalence of Tuberculosis among the multidimensional poor compared to the multidimensional non-poor in most of the states in India11 . A study done in Pune discovered a link between kerosene use and tuberculosis10. In our study we had not found any households using kerosene as a cooking fuel. They responded by saying we are not getting any kerosene from the public distribution system anymore. The Government’s Ujjwala program has significantly changed the type of cooking fuel. The ‘Pradhan Mantri Ujjwala Yojana’ (PMUY) is a flagship scheme with the objective to make clean
Table 4 — Statistical Association
Vol 122, No 09, September 2024
cooking fuel such as LPG available to the rural and deprived households which were otherwise using traditional cooking fuels such as firewood, coal, cowdung cakes etc12. Most of our study households used wood along with LPG citing high cost of LPG.
Indoor air pollution is common in TB households and has been identified as a risk factor forTB mortality and morbidity13. In 90% of the houses in our survey lacked cross ventilation, and 58.8% of the households were crowded. In addition to this, 86.6% of people reported using a Mosquito coil, an incense stick, camphor or another indoor pollution source on a daily basis. All of them causes Indoor Air Pollution, which is a significant factor in TB mortality and morbidity14
As the Government has attempted to address nutrition through food baskets and the Nikshay Poshan Yojana, we should endeavour to implement measures that address Indoor Air Pollution. We should stimulate research into realistic practical remedies for IndoorAir Pollution among TB Patients. We should also try to bring a discussion on re-instating Sanatoriums which was the Worldwide accepted management technique in the pre-antibiotic era15
Limitations: We could have measured the pm 2.5 levels to assess the Indoor air pollution more precisely.
The poorest populations, who are most at risk, should be the focus of TB control initiatives and significant disease determinant like Indoor Air Pollution should be addressed.
Although the Ujjwala program has indicated a change in the type of cooking fuel used, Government should take action to encourage LPG usage by making more of it available and keeping LPG pricing under control.
Those who have been diagnosed with TB should get Health Education about IndoorAir Pollution, which should include general guidance on optimal ventilation and removing sources of IAP
1 National TB Prevalence Survey in India. Indian Council of Medical Research (ICMR), New Delhi ICMR National Institute for Research in Tuberculosis (NIRT), Chennai Ministry of Health and Family Welfare (MOHFW), Government of India, New Delhi Central TB Division (CTD) and National Tuberculosis Elimination Programme (NTEP), World Health Organisation (WHO), India Office, New Delhi State TB Cells of all States and Union Territories; 2019 - 2021.
2 TB statistics India [Internet]. TBFacts. 2018 [cited 2023 Aug 28]. Available from: https://tbfacts.org/tb-statistics-india/
3 Patel V, Foster A, Salem A, Kumar A, Kumar V, Biswas B, et al — Long-term exposure to indoor air pollution and risk of tuberculosis. Indoor Air [Internet] 2021; 31(3): 628-38. Available from: http://dx.doi.org/10.1111/ina.12756
4 Snow SJ, De Vizcaya-Ruiz A, Osornio-Vargas A, Thomas RF, Schladweiler MC, McGee J, et al — The effect of composition, size, and solubility on acute pulmonary injury in rats following exposure to Mexico city ambient particulate matter samples. Journal of Toxicology and Environmental Health, Part A [Internet] 2014 [cited 2023 Aug 28]; 77(19): 1164-82. Available from: https://pubmed.ncbi.nlm.nih.gov/25119738/
5 Ghio AJ — Particle exposures and infections. Infection [Internet] 2014; 42(3): 459-67.Available from: http://dx.doi.org/ 10.1007/s15010-014-0592-6
6 Ghanei. Bronchial anthracosis: A potent clue for diagnosis of pulmonary tuberculosis. Oman Med J [Internet] 2011 [cited 2023; 26(1): 19-22. Available from: https:// pubmed.ncbi.nlm.nih.gov/22043373/
7 The end TB strategy [Internet]. Who.int. [cited 2023 Aug 28]. Available from: https://www.who.int/teams/global-tuberculosisprogramme/the-end-tb-strategy
8 Murray JF, Schraufnagel DE, Hopewell PC — Treatment of tuberculosis. A historical perspective. Ann Am Thorac Soc [Internet] 2015; 12(12): 1749-59. Available from: http:// dx.doi.org/10.1513/annalsats.201509-632ps Daniel TM.
9 Hermann Brehmer and the origins of tuberculosis sanatoria [Founders of our knowledge]. Int J Tuberc Lung Dis [Internet] 2011; 15(2): 161-2. Available from: https:// www.ingentaconnect.com/content/iuatld/ijtld/2011/00000015/ 00000002/art00004
10 Elf JL, KinikarA, Khadse S, Mave V, Suryavanshi N, Gupte N, et al — The association of household fine particulate matter and kerosene with tuberculosis in women and children in Pune, India. Occup Environ Med [Internet] 2019; 76(1): 40-7. Available from: http://dx.doi.org/10.1136/oemed-2018-105122
11 Pathak D, Vasishtha G, Mohanty SK — Association of multidimensional poverty and tuberculosis in India. BMC Public Health [Internet] 2021; 21(1) Available from: http://dx.doi.org/ 10.1186/s12889-021-12149-x
12 PMUY/ : Home [Internet]. Gov.in. [cited 2023 Aug 29]. Available from: https://www.pmuy.gov.in/
13 Oxlade O, Murray M — Tuberculosis and poverty: Why are the poor at greater risk in India? PLoS One [Internet] 2012; 7(11): e47533. Available from: http://dx.doi.org/10.1371/ journal.pone.0047533
14 Blount RJ, Phan H, Trinh T, Dang H, Merrifield C, Zavala M, et al — Indoor air pollution and susceptibility to tuberculosis infection in urban Vietnamese children. Am J Respir Crit Care Med [Internet] 2021; 204(10): 1211-21. Available from: http:// dx.doi.org/10.1164/rccm.202101-0136oc
15 Warren P — The evolution of the sanatorium: The first halfcentury, 1854-1904. Can Bull Med Hist [Internet] 2006 [cited 2023; 23(2): 457-76. Available from: https:// pubmed.ncbi.nlm.nih.gov/17214126/
Manjari Saha1, Debasis Sarkar1, Soumya Sarathi Mondal2 Antarleena Ray3
Background : Hepatitis B Virus (HBV) infection is a major public health problem worldwide as approximately 350 million have chronic HBV infection of which 15 to 40% may progress to Chronic Liver Disease and may further develop Hepatocellular Carcinoma.
In the registration trial Tenofovir, an oral nucleotide analog, polymerase inhibitor was found to be highly effective and potent with a sustained virological response. However in eastern India there are no landmark studies on Tenofovir.
Aims and Objectives : To evaluate the effect of Tenofovir as first line monotherapy on viral suppression and hepatic function in chronic hepatitis B patients with Chronic Liver Disease.
Materials and Methods : After fulfilling the inclusion criteria, 72 patients with chronic Hepatits B infection, were prescribed Tab Tenofovir (300 mg /day) for 1 year in this hospital based prospective study. Periodic follow-up with clinical, biochemical and virological assessment was done at 6 months and 1 year.
Results : Our study shows loss of HBsAg in 10 (13.88%) patients and HBeAg seroconversion was 81.81%. Biochemical and Child Pugh score improvement was statistically significant. At end of study total 42 (58.33%) achieved HBV DNA below detectable level (<3.8 iu/ml).
Conclusion : There was statistically significant improvement of clinical, biochemical,serological and virological parameters with minimum side effect and well tolerability after 1 year of therapy with Tenofovir in Chronic Liver Disease patients with chronic Hepatitis B infection. HBeAg seroconversion was high and sustained and the achievement of undetectable HBV-DNA was significant and almost similar in both HBeAg reactive & non reactive groups.
[J Indian Med Assoc 2024; 122(9): 17-20]
Key words :Chronic Liver Disease, Chronic Hepatitis B, Tenofovir, Hepatitis B Virus.
Hepatitis B Virus (HBV) infection is a major public health problem World wide. Despite the availability of a highly effective vaccine there are 2 billion cases of HBV infection of which approximately 350 million have chronic HBV infection. The number of HBsAg carrier in India has been estimated to be over 40 million. Chronic HBV remains inactive in 60 to 70% cases; 15 to 40% infection may progress to Chronic Liver Disease (CLD) (cirrhosis) and may also progress to Hepatocellular Carcinoma (HCC).
Tenofovir, an oral nucleotide analog, polymerase inhibitor, appears to be the most potent of the HBV antivirals specially in HBeAg negative patients .In the registration trial tenofovir was found to be highly effective and potent in Treating Hepatitis B with sustained virological response and no resistance was noted in 4 years. In eastern India there are no landmark studies on Tenofovir, thus the purpose of this study is to evaluate the response of Tenofovir in chronic HBV infection and to find out biochemical, virological, serological and histological response of Tenofovir in
Department of General Medicine, Medical College Hospital, Kolkata 700073
1MD, Associate Professor
2MD, Professor
3MD, Postgraduate Trainee and Corresponding Author
Received on : 23/06/2023
Accepted on : 06/09/2023
Editor's Comment :
Hepatitis B infection is a major public health problem with approximately 350 million worldwide cases of chronic HBV infection.
Our study found statistically significant improvement in clinical, biochemical, serological, and virological parameters with minimum side effects after 1 year of therapy with Tenofovir in chronic hepatitis B patients.
chronic HBV infection at 6 months and at 1 year.
MATERIALS AND METHODS
(I) Study Area : Medical College Hospital, Kolkata
(II) Study Population : Chronic Liver Disease patients due to HBV infection attending MOPD or admitted in MCH, Kolkata.
(III) Study Period : 1year
(IV) Sample Size : (n) 72.
(V) Sample Design :
All chronic liver disease patients (Fulfilling the inclusion & exclusion criteria) due to HBV infection attending Medicine Outpatients Department (OPD), admitted in wards who need treatment (according to ASSLD guideline) and gives written informed consent will be made part of this study.
(VI) Inclusion Criteria :
(1) Patients of Chronic Liver Disease (documented
122, No 09, September 2024Journal
by clinical, biochemical and histological criteria) with HBV infection (detected by HBeAg, HBV DNA) who are treatment naive
(2) Age group of 12 to 60
(VII) Exclusion Criteria :
(1) Patients of Chronic Liver Disease due to other causes (Hepatitis C, Alcohol, Autoimmune Hepatitis)
(2) Patients with severe co-morbid illneses.
(3) Patients on any drug that can alter the test drug
(4) Patients with decompensated cirrhosis
(VIII) Study Design : Hospital based prospective study with 72 patients (n=72). In HBeAg positive patients treatment is given only if HBV DNA >20000 IU/ ml and AST, ALT above 2 times normal.
In HBeAg negative patients treatment is given only if HBV DNA >2000 IU/ ml and AST, ALT above 2 times normal (AASLD Guideline).
After inclusion criteria is met and written consent is obtained, patients were given tablet Tenofovir 300 mg daily after meal. All patients were followed on monthly basis at OPD with clinical examinations & routine laboratory tests.
The biochemical response was assessed on the basis of LFT with emphasis on total Bilirubin and liver enzymes. Biochemical breakthrough was considered as increase in ALT above 1.5 times upper limit of normal.
The virological response was assessed at baseline, at 6 month & at 12 month. Virological response was considered as undetectable HBV-DNA by PCR (<3.8 copies/ml), HBeAg seroconversion was considered as loss of HBeAg and appearance of antibody. Disappearance of HBsAg was the ultimate goal of treatment. Virological breakthrough was considered as the reappearance of detectable HBVDNA after an episode of undetectable level or increase of HBV DNA one log from nadir.
(IX) Parameters To Be Studied :
(1) Clinical parameters
(2) Biochemical parameters (a)Liver Function Test (b)PT(in sec), INR (c)Complete haemogram (d)Sugar, Urea, Creatinine (e)ANA (when required)
(f)Serum ceruloplasmin (when required)
(3) Microbiological parameters (a)HBsAg (b)HBeAg (c)HBV - DNA (d)HCV, HIV
(4) Radiological parameter USG whole abdomen (liver echotexture, portal vein diameter, ascites, splenomegaly)
(5) Upper Gastrointestinal Endoscopy
(6) Histology where feasible
(X) Study Tools :
(A) Clinical examination
(i) Symptoms : Anorexia, Nausea, Vomiting, Hematemesis & Melena, Fatigue, Itching, Fever, Bleeding Tendencies, Jaundice, Swelling of Legs, Pain Abdomen, Distension of Abdomen, Skin Rashes, Joint Pain, Impotence.
(
ii) Signs : altered consciousness, Hair Loss, Icterus, Pallor, Fetor Hepaticus, Palmar Erythema, Asterxis, JVP, Spider Angioma, Clubbing, Muscle Weakness, Pedal Edema, Petichae, Palpable Purpura, Ascites, Right Hypochondrial Tenderness, Hepatomegaly, Splenomegaly, Signs of Portal Hypertension.
(B) Biochemical Tests :
(i) Serum total bilirubin (Jendrassik & Grof method)
(ii) ALT [SGPT] (UV Kinetic IFCC Method)
(iii) AST [SGOT] (UV Kinetic IFCC method)
(iv) Serum alkaline phosphatase (PNPP method)
(v) Serum total protein (Biuret method)
(vi) Serum Albumin (BCG Method)
(vii) HBs Ag estimation by ELISA : (viii) HBeAg test: double antibody sandwich immunoassay.
(ix) Anti –HCV antibody by ELISA
(C) Pathological Examination :
Liver biopsy and histological examination :
Liver biopsy is the traditional gold standard for evaluation of Chronic Liver Diseases. A complete physical examination & history, review of medications, and measurement of clotting parameters are essential.
(D) Virological examination :
HBV DNA assay : by Polymerase Chain Reaction (PCR) amplification
(E) Child Pugh Score :
Chronic Liver Disease is classified into Child-Pugh class A to C.
(XI) Study Techniques :
Tests to diagnose Chronic Liver Disease : Clinical examination, LFT, USG whole abdomen (W/ A), PT/INR, Upper GI Endoscopy.
Tests to assess HBV activity: HBsAg, HBeAg, HBV DNA quantitative assay.
Tests to exclude other systemic diseases: Complete Hemogram, Blood Sugar, Urea, Creatinine, Chest X-ray, ECG, ANA in some cases.
Tests to exclude HCV & HIV : Anti HCV antibody, HIV ELISA
(XII) Statistical analysis : paired t test was used and the P-value <0.05 taken as significant.
(XIII) Software used : Graph pad prisom version 6 was used for statistical analysis. Microsoft Office Excel 2007 was used for tabulation, calculation and table & chart preparation. ANALYSIS AND RESULTS
We evaluated,100 patients of which 72 patients
122, No 09, September 2024Journal
fulfilled the inclusion criteria.
Finally 72 (56 male and 16 female) treatment naïve patients of chronic Hepatitis B were included in our study.
Patients who fulfilled the treatment requirement criteria were prescribed tab Tenofovir 300 mg /day O.D dose irrespective of HBeAg status (Table 1).
Table 1 — Baseline Parameters
ParameterAverage (n=72)
Bilirubin(mg/dl)1.545
ALT (IU/L)205.55
AST (IU/L)193.58
ALP (IU/L)266.80
Albumin (g/dl)3.478
Globulin (g/dl)3.347
CP SCORE6.056
At baseline average bilirubin was elevated. Decrease of mean total bilirubin was statistically significant both 6 months and 12 months (p value <0.05)(Table 2, Fig 1).
Table 2 — Change of Total Bilirubin
Time in monthMean ± SEMP value
Baseline 1.545 ± 0.1642 (N=72)
6 months0.9389 ± 0.05275 (N=72)<0.0008
12 months0.7750 ± 0.04205 (N=72)<0.0001

At baseline every patients had ALT above normal range (male 30IU/L and female 19IU/L). At the end of 6 months 6(8.3%) patients ALT became normal and at end of study 46(63.88%) patients ALT became normal. P-value was significant both 6 months and 12 months.
At baseline AST of all patient was above normal (male 30IU/L and female 19IU/L) at 6 months 6 (8.3%) patients achieved normal AST and 12 months 50(69.44%) patients achieved normal AST level. Result was significant (Table 3, Figs 2&3).
Response of Child Pugh Score
CP score of all patients were calculated at baseline, 6 month and 12 months. Improvement of CP score was statistically significant as p value is <0.005 both 6 months and 12 months (Table 4).
Serological Response
At baseline 44 (61.11%)patients were HBeAg positive and 28(38.88%) were HBeAg negative.
Table 3 — Change of ALT and AST In Study Population
Time in monthsMean ± SEMP value
Baseline of ALT205.6 ± 23.43 (N=72)
6months ALT63.50 ± 4.565 (N=72)< 0.0001
12 months ALT30.57 ± 2.025 (N=72)< 0.0001
Baseline of AST193.6 ± 20.31 (N=72)
6 months AST60.39 ± 5.802 (N=72)< 0.0001
12 months AST30.23 ± 2.181 (N=72)< 0.0001

—

Table 4 — Distribution of patients according to Child Pugh score (n=72)
TimeCP class ACP class B
Baseline52(72.22%)20(27.77%)
6 months70(97.22%)2(2.77%)
12 months72(100%)0(0%)
At 6 month 26 (59.09%) patients and at 12 months total 36 (81.81%) out of 44 HBeAg positive patients lost HBeAg status.
At end of study 10 (13.88%) patients lost HBsAg. So there is high percentage of HBeAg and HBsAg loss during 12 months of therapy. No serological breakthrough has been reported.
Virological Response
HBV-DNA became below detectable level (<3.8 iu/ml) in 2 patiens (2.78%) at 6 month and 26(59.09%) patients in HBeAg positive (n=44) patients at 12 month.
16 patients (57.14%) achieved HBV DNA below detectable level (<3.8iu/ml) at 12 month in HBeAg negative patients (n=28). Overall HBV DNA below detectable level (<3.8iu/ml) at 12 month was in 42 patients (58.33%) which is highly significant.
DISCUSSION
Cirrhosis develops as a result of hepatic inflammation and subsequent fibrosis in chronic
122, No 09, September 2024Journal
Hepatitis B infection. Patients with Hepatitis B virus (HBV) cirrhosis and high levels of serum HBV-DNA are more likely to develop liver failure and Hepatocellular Carcinoma (HCC). Spontaneous or drug-induced suppression of serum HBV-DNA is associated with biochemical and histological remission of liver disease. The mainstay of therapy for HBV cirrhosis is the inhibition of the replicative cycle of HBV in hepatocytes. In patients with HBV related cirrhosis, the issues in choosing a drug, such as efficacy, safety, incidence of resistance, method of administration and costs, are of particular concern. A major concern with long-term antiviral treatment are antiviral-resistant mutations. Emergence of antiviral-resistant mutations can lead to negation of the initial response, Hepatitis flares and hepatic decompensation. Use of the most potent agents as first-line remedy lowers the threat of resistance. Potency in suppressing HBV-DNA is the main factor in the choice of first-line therapy; Tenofovir constitute the most potent nucleoside analogues to date with the lowest rates of resistance. The aggregate efficacy and safety data now support the use of Tenofovir as a first line treatment option for nucleoside naive cases with compensated HBV cirrhosis.
There are very few studies of Tenofovir, especially in eastern India. In our study we included 72 chronic Hepatitis B infected, treatment naive patiens after fulfilling all inclusion criteria and written informed consent. They received 300 mg Tenofovir daily orally for 1 year. Periodical follow-up was done at 6 and 12 months.
Total bilirubin dropped significantly from baseline. At baseline bilirubin was elevated in 44 (61.11%) patients and at end of study only 18(25%) patient’s bilirubin was above normal (bil <1 mg /dl)
ALT and AST decrease from baseline 6 months and 12 months were significant. ALT normalization at end of study was 59.09% in HBeAg positive patients and 64.28% in HBeAg negative patients.
There was significant improvement of CP score from baseline. P value was significant both 6 months and 12 months.
Among 44 HBeAg positive patients at baseline, 26 patients ( 59.09%) lost HBeAg at 6 month and 36 patients (81.81%) at 12 month.
HBsAg loss at end of study was in 10 patients (13.89%).
HBV DNA became below detectable level (<3.8iu/ ml) in 2 patients (2.78%) at 6 month and 26(59.09%) patients in HBeAg positive (n=44) patients at 12 month.
16 patients (57.14%) achieved HBV DNA below detectable level (<3.8 iu/ml) at 12 month in HBeAg
negative patients (n=28). Overall HBV DNA below detectable level (<3.8 iu/ml) at 12 month was in 42 patients (58.33%) which is highly significant .
No death occurred during the study period. No severe adverse effect was reported during one year follow up. Only 4(5.55%) patients had mild elevation of Serum Creatinine (<0.5 mg/dl )
Limitations : One of the limitations of this study is lack of histological evaluation as it was very difficult to motivate patients for liver biopsy. This type of study demands more time and number of patients. Resistance profile and mutation analysis are important evolving parameters but due to high cost, we could not perform it. More extensive epidemiological evaluation of patients could have been done.
Thus, further studies with a larger cohort of patients, especially comparison study with another antiviral drug or combination therapy is required.
There was statistically significant improvement of clinical, biochemical, serological and virological parameters with minimum side effects and well tolerability after 1 year of therapy with Tenofovir (300 mg /day) in Chronic Liver Disease patients with chronic hepatitis B infection.
HBeAg seroconversion was high and sustained, and the achievement of undetectable HBV DNA was significant and almost similar in both HBeAg reactive & non reactive groups.
We must say that further long term, multi-centric, multi-arm studies involving larger patient group is necessary in this field.
1World Health Organization — Hepatitis B Fact sheet No 204. 2000 [Last accessedSeptember2006] Available from: http:// www.who.int/ mediacentre/factsheets/fs204/en/print.html
2World Health Organization, Department of Communicable Diseases Surveillance and Response. Hepatitis B; 2002. Report No.:WHO/CDS/CSR/LYO/2002.2
3Bosch FX, Ribes J, Cleries R, Diaz M — Epidemiology of hepatocellular carcinoma. Clin Liver Dis 2005; 9: 191-211. 4Hepatitis B-Home-WHO India www.whoindia.org/en/ section6%5Csection8.htm
5Bahramali G, Sadeghizadeh M, Amini-Bavil-Olyaee S, et al — Clinical, virologic and phylogenetic features of hepatitis B infection in Iranian patients. World J Gastroenterol 2008; 14(35): 5448-53.
6Kuo A, Dienstag JL, Chung RT — Tenofovir disoproxil fumarate for the treatment of lamivudine-resistant hepatitis B. Clin Gastroenterol Hepatol 2004; 2(3): 266-72.
7FDA approval letter(regarding use of tenofovir in treatment of HBV), 2008
8AASLD PRACTICE GUIDELINE UPDATE Chronic Hepatitis B: Update 2009
9Schiff disease of liver, 11th edition, Elsevier.
10Hepatitis B vaccine. Lancet 2 (8206): 1229-1230. 1980. PMID 6108398.
Munish Sharma1
Background : A study to evaluate time delays and management strategy in patients presenting with acute coronary syndrome in a Tertiary Cardiac Care Centre in Eastern India during COVID-19 pandemic.
Material and Methods : This is a retrospective, observational study that included all patients, 18 to 90 years of age, who had a history of recent ACS and presented to our hospital and who were diagnosed with an Acute Coronary Syndrome. A group of ACS patients from a similar time period of last year (1 Junuary, to 31 August, 2019; pre-COVID-19 era group) was used as control. The main outcome was a delay in reaching the intervention cardiology centre and time to coronary angiography from the admission to Tertiary Cardiac Care Centre.
Results : A total of 54 subjects were studied in the study. They were divided into two groups. In group 1, 34 subjects were studied in COVID-19 pandemic time during the initial unlock period in India from 01 Junuary, 2020 to 31 August, 2020. In group 2, 25 subjects from the pre-COVID-19 period during a similar time in 2019 were studied for comparison. The average age of the subjects in Group 1 was 50.4 years and 58 years in Group 2. The average time taken to reach this tertiary care centre was 11.76 days (range 0-30 days) in Group 1 and 3.2 days (range 0-11) days in Group 2. The average time to CAG from the time of admission was 3.4 days (range 1-6 days) in Group 1 when we exclude the subject who was found to be suffering from COVID-19 infection. The average time to CAG from the day of hospital admission was 1.6 days in Group 2. All the patients in both groups were discharged to home.
Conclusion : In the study, we have found a substantial delay in symptom onset to reaching our centre during the COVID-19 era.
[J Indian Med Assoc 2024; 122(9): 21-3]
Key words :COVID-19 Pandemic, Acute Coronary Syndrome, Delay in Hospital Admission, Delay in Treatment.
We are in the middle of an unprecedented global pandemic. CORONAVIRUS 2019 (COVID-19), caused by severe acute respiratory syndrome CORONAVIRUS 2 (SARS-CoV-2 virus) has caused overlap in initial presentation with Acute Coronary Syndrome (ACS)1. Furthermore, symptoms alone are unhelpful, as quite a few screened for COVID-19 test negative and majority of COVID-19 infections are asymptomatic. There are multiple studies in the past which has shown that minimizing delays in reperfusion in patients with ACS is associated with improved outcomes2. Timely primary percutaneus coronary intervention relies heavily on systems of care, and not just the primary operator. There are multiple steps which are time consuming as in the emergency room. Every patient is required to establish contact history, symptomatology, chest X-ray, etc, before transfer to the Cardiac Catheterization Laboratory (CCL). CCL
1MD, DNB, Associate Professor, Department of General Medicine, Command Hospital Western Command, Panchkula, Haryana 134114 and Corresponding Author
Received on : 31/08/2021
Accepted on : 19/01/2022
Editor's Comment :
The COVID-19 pandemic added substantially to already existing delays in patients with Acute Coronary Syndrome presenting to medical facilities. There was also a delay in coronary angiography after admission to the hospital because of various reasons like infrastructure, investigations and shortage of doctors and support staff during the ongoing pandemic.
During a pandemic, the public needs to be sensitized and timely reporting of emergencies other than pandemic-related should be emphasized.
The infrastructure of the hospital should be built and modified in a way so that the treatment of diseases other than the pandemic continues unhindered without any time delay and resource shortage.
staff require time to don personal protective equipment and there may be delay due to this3
Even before the delay in hospital, due to COVID-19 pandemic fear, patients are reluctant to report to medical care facilities, thus delaying the treatment4 Also, due to unavailability of transport, there has been substantial delays in reporting to hospitals.
During a public health emergency, these delays become even more challenging to predict, and there
122, No 09, September 2024Journal
is hardly any literature which provides information about the impact of these emergencies on pre- and in-hospital logistics of ACS care, in particular patientrelated delay.
Current study evaluates the time delay, management strategy and initial outcome while comparing with pre-COVID-19 pandemic times in patients presenting with ACS in the Tertiary Cardiac Care Centre in eastern India.
AIMS AND OBJECTIVES
Aim : To evaluate time delays and management strategy in patients presenting with ACS in the tertiary cardiac care centre in eastern India during COVID19 pandemic.
Objectives :
(1)Time delay between onset of symptoms and admission to this hospital.
(2)Time delay between reporting to hospital to invasive cardiac intervention.
MATERIALS AND METHODS
Methodology :
Inclusion Criteria : All patients presenting to hospital and admitted as ACS.
Exclusion Criteria : Patients with Chronic Kidney Disease stage 2 and above.
No consent was taken as this study is a retrospective observational study.
Study Design :
This is a retrospective, observational study that included all patients, 18 to 90 years of age, who had history of recent ACS and presented to our hospital and who were diagnosed as ACS. ACS was defined according to the fourth universal definition of myocardial infarction Indications for primary PCI followed the current practice guidelines2
A group of ACS patients from a similar time period of last year (1st Junuary to 31st August, 2019; preCOVID-19 era group) were used as control.
Study Outcome :
The main outcome was delay in reaching intervention cardiology centre and time to coronary angiography from the admission to Tertiary Cardiac Care Centre.
A total of 54 subjects were studied in the study. They were divided into two groups. In Group 1, 34 subjects were studied in COVID-19 pandemic time during initial unlock period in India from 1st Junuary, 2020 to 31st August, 2020. In Group 2, 25 subjects
from pre-COVID-19 period during similar time in 2019 were studied for comparison.
Average age of the subjects in Group 1 was 50.4 years and 58 years in Group 2.
Distribution of type of ACS is given in Table 1.
Average time taken to reach this Tertiary Cardiac Care Centre was 11.76 days (range 0-30 days) in Group 1 and 3.2 days (range 0-11) days in Group 2. There was only one subject who was found to be COVID-19 positive and he was taken up for CAG for risk assessment after treatment of COVID-19 infection.
Average time to CAG from time of admission was 3.4 days (range 1-6 days) in Group 1, when we exclude the subject who was found to be suffering from COVID-19 infection.
Average time to CAG from day of hospital admission was 1.6 days in Group 2 (Table 2).
All the patients in both groups were discharged to home.
The current study highlights the impact of COVID19 pandemic on patient presenting with ACS in regard to delay in presenting to intervention cardiology centre and time delay to invasive angiography.
The total ischemic time is a major determinant of outcomes in ACS patients, and early management is critical in reducing morbidity and mortality2.
There has been several steps taken at the organizational level to reduce door-to-balloon time. However, outcomes to reduce patient-related delay has been controversial.
In our study, we have found substantial delay in symptom onset to reaching to our centre during the COVID-19 era. There has been substantial delay in coronary angiography even after admission to our
Table 1 — Types of Acute Coronary Syndrome in two Groups Type of ACSAnteriorLateralInferiorNSTEMIUnstable wallwall wallAngina MIMIMI
Number of subjects : Group 1166666 Group 2122632
Table 2 — Average Delay in reporting to Hospital and Angiography
Group 1Group 2 Average age in years50.458 Days to reach invasive cardiology centre in days11.763.2 Days to CAG from admission time in days3.41.6
122, No 09, September 2024Journal
centre. The significant patient-related delay is likely due to the ongoing COVID-19 pandemic fear, fear of catching COVID-19 infection in hospital and non availability of transport from villages and smaller towns. Delay in seeking medical care due to fear of contracting infection was seen in the Ebola epidemic in West Africa (2013)3. In literature, various other causes for patient-related delay in STEMI have been described4.
However, considering that these causes remained largely unchanged between 2019 and 20205, the COVID-19 pandemic has come out as the major new variable causing this substantial difference in patientrelated delay6-8
In our study, we also have found substantial delay in CAG even after admission to hospital because of various reasons like time taken for RT PCR COVID test as all patients were subjected to CAG only after negative COVID-19 report due to availibilty of only one Cath Lab. Other causes of delay were staff shortage due to utilization in COVID duties, nonavailibilty of sufficient beds in makeshift CCU, delay in getting routine blood reports prior to CAG etc.
Limitations :
The current study has limitations. First, this is a single center observational experience and may not be generalized to other centres. Second, patients were not followed up after hospitalization. Third, the onset of symptom subjective and precise timing may be controversial. Finally, sample size in our study is small and our study is retrospective, hence further analysis to identify independent predictors for delay are difficult to define. It would be better defined with a larger population survey.
Conclusion :
During the current the COVID-19 outbreak, there is need to sensitize public and the message “Stay at Home” should not be misinterpreted in a way that people ignore sinister symptoms of major events. They should be sensitized to seek medical advice in a timely manner.
1Thygesen K, Alpert JS, Jaffe AS — Fourth Universal Definition of Myocardial Infarction (2018). Circulation 2018; 138(20): 617-18.
2De Luca G, Suryapranata H, Ottervanger JP — Time delay to treatment and mortality in primary angioplasty for acute myocardial infarction: every minute of delay counts. Circulation 2004; 109(10): 1223-5.
3McQuilkin PA, Udhayashankar K, Niescierenko M — Healthcare access during the Ebola virus epidemic in Liberia. Am J Trop Med Hyg 2017; 97(3): 931-6.
4Leslie WS, Urie A, Hooper J — Delay in calling for help during myocardial infarction: reasons for the delay and subsequent pattern of accessing care. Heart 2000; 84(2): 137-41.
5Bradley EH, Nallamothu BK, Herrin J — National efforts to improve door-to-balloon time results from the Door-to-Balloon Alliance. J Am Coll Cardiol 2009; 54(25): 2423-9.
6Abdelaziz HK, Abdelrahman A, Nabi A — Impact of COVID19 pandemic on patients with ST-segment elevation myocardial infarction: Insights from a British cardiac center. Am Heart J 2020; 226: 45-8.
7De Luca G, Debel N, Cercek M — Impact of SARS-CoV-2 positivity on clinical outcome among STEMI patients undergoing mechanical reperfusion: insights from the ISACS STEMI COVID 19 Registry. Atherosclerosis 2021; 332: 48-54.
8Kite TA, Ludman PF, Gale CP — International COVID-ACS Registry Investigators. International prospective registry of acute coronary syndromes in patients with COVID-19. J Am Coll Cardiol 2021; 77(20): 2466-76.
Sudipta Bera1, Tapobrata Biswas2, Arijit Majumdar3
Background : Thalassemia and other Haemoglobinopathy can be prevented by population screening, diagnosis of carrier state at younger age and offering genetic counselling.
Materials and Methods : This study was conducted in the department of Pathology of a Tertiary Care Hospital in Purulia in collaboration with Thalassemia clinic over a period of four and a half years from January, 2018 to June, 2022 retrospectively in non-randomized method. All newly registered patients attending Thalassemia clinic along with patients having anaemia referred for screening of Hb disorders and people who came up with premarital check-up as well as antenatal check-up were included in the study. Detailed clinical history was recorded. Blood samples were collected and analyzed with Sysmex, automated cell counter for complete blood counts. Diagnosis of Haemoglobinopathies was done by G8 HPLC (High Performance Liquid Chromatography) Analyzer by TOSOH Bioscience.
Results : Among total 4997 cases, study population having less than 10 years of age group is comprised of 332 which are 7% of total population. Predominant study population is female with male: female ratio 1:3.5. Among them, abnormal Haemoglobinopathy are seen in 1100 patients. Most common cause of Haemoglobinopathy was Beta Thalassemia trait (13.5%) and Beta Thalassemia major (3%) followed by Sickle cell trait (2%). Homozygous and compound heterozygous patients have variable symptoms of moderate to severe anemia. The mean Haemoglobin value was found to be lowest in β-thalassemia major.
Conclusion : Among the hemoglobinopathy, β−thalassemia is prevalent in tribal population of Purulia.
[J Indian Med Assoc 2024; 122(9): 24-7]
Key words :Haemoglobinopathy, Beta Thalassemia, Tribal area, Purulia.
Inherited disorders of Haemoglobin due to structural alteration of the globin polypeptide chain, called as Haemoglobinopathy are the most common monogenic disorder 1,2 . Thalassemia and other Haemoglobino-pathies can be prevented by population screening and offering genetic counseling3 Beta-thalassemia (β-thalassemia), sickle cell anemia, E-beta thalassemia and Haemoglobin D Punjab are the common Haemoglobinopathies seen in India3. It was reported that 7,500-12,000 babies would be born with β-thalassemia major in India each year4. Thalassemia results due to mutation in globin gene results in reduced synthesis of one or more globin chains. Whereas qualitative defects which may cause alteration of amino acid sequence of globin protein may result in Hb variants5. When different Hb variants are inherited in heterozygous state, it can results in serious homozygous or compound
Deben Mahata Government Medical College & Hospital, Purulia, West Bengal 723147
1MBBS, MD, Assistant Professor, Department of Pathology
2MBBS, MD, Assistant Professor, Department of General Medicine and Corresponding Author
3MBBS, MD, Associate Professor, Department of Pathology
Received on : 05/09/2023
Accepted on : 08/09/2023
Editor's Comment : Haemoglobinopathies are preventable diseases. Extensive screening among society and ample public awareness can only free people from this burden.
heterozygous Hb variants in the babies. Such double or compound heterozygous states between certain variants may lead to clinical manifestations3. Although regular and safe blood transfusion based on severity of anaemia along with adequate iron chelation therapy and Bone Marrow Transplantation (BMT) as a definitive management have significantly enhanced the prognosis as well as the survival rates of the patients. Frequent hospital visits, drug intake for long duration, side effects of drugs and disease complications affect compliance towards treatment in great extent 6 . Many Government and Nongovernment institutions are implementing programmes for prevention and control of Thalassemia and other Haemoglobinopathies, develop facilities for prenatal diagnosis and genetic counselling. West Bengal has higher prevalence of Thalassemia; approximately 6-10% of the population are carriers of the disease7-9. Among them, tribal population is one of the most vulnerable population
122, No 09, September 2024Journal
suffers from many health hazards including Haemoglobinopathy due to different Socio-cultural, socio economic and ecological factors10 Very few studies has done till now over these tribal population of Purulia. This present study is intended to know the prevalence of β-thalassemia, HbS, HbD, HbE as well as identification of asymptomatic carriers who have an increased risk of having a child with Thalassemia among these socially disadvantaged populations of Purulia. Along with the information regarding Sociodemographic condition, clinical presentations among the patients will help to formulate and plan awareness programme and prevention strategies for such disease for the district of Purulia with a intention of reducing this health burden.
This study was conducted in the Department of Pathology of a Tertiary Care Hospital in Purulia in collaboration with Thalassemia clinic after getting ethical clearance. The data was collected over a period of four and a half years from January, 2018 to June, 2022 retrospectively in non-randomized method. All newly registered patients attending Thalassemia clinic were included in the study. Along with patients having anaemia referred for screening of Hb disorders, people who came up with premarital check-up as well as preconception check up, antenatal mother referred for screening of Hb disorders and transfusion dependent patients were included in the study. However, patient coming from area other than Purulia and patients with history of blood transfusion within 1 month are excluded from the study. Patients having borderline value of HbA2 ie, 3.6-4% were excluded from the study. An informed consent was taken from all the patients as well as parents of minor age group of children. Detailed clinical history including family history and blood transfusion history wherever present was recorded from the register. Blood samples collected in Ethylene Diamine Tetrachloride Acetate (EDTA) vials were analyzed with Sysmex, automated cell counter for Complete Blood Counts. Peripheral Blood Smear (PBS) examination is done to see red cells morphology for the supporting of diagnosis of Haemoglobinopathies. Diagnosis of Haemoglobinopathies was done by G8 HPLC (High Performance Liquid Chromatography) Analyzer TOSOH Bioscience. Confirmatory tests such as sickling test, 21 solubility test, brilliant cresyl blue test for HbH inclusions etc were performed as and when required. In very few cases, which were not interpreted by HPLC, samples were sent to referral
lab for mutation study.
A total 4997 cases including paediatric age group of patients were studied during the whole study period of 4.5 years. Among them study population having less than 10 years of age group is comprised of 332 which is 7% of total population. Predominant study population is female consists for 3909 (78%) cases with male: female ratio 1:3.5 (Table 1). Among 4997 cases, abnormal haemoglobinopathy are seen in 1100 cases. Most common cause of haemoglobinopathy was Beta Thalassemia trait and Beta Thalassemia major followed by Sickle cell trait (Table 2). The clinical examination and haematological profile of the affected patients were studied. Usually most of the patients of heterozygous carrier do not manifest symptoms unless in stress conditions. But homozygous and compound heterozygous patients have variable symptoms of anaemia like fatigue, anorexia, inability to feed, recurrent episodes of infection (Table 3).
Table 1 — Distribution of patients according to Age groups and Gender
Table 2 — Types of Haemoglobinopathy and their prevalence TypesNumbers (percentage)
Beta Thalassemia trait679 (13.5%)
Beta Thalassemia major158 (3%)
HbS trait99 (2%)
HbE trait95 (1.9%)
HbS disease11 (0.2%)
Hb E disease9 (0.1%)
HbS-β-thalassemia 18 (0.3%)
HbE-β-thalassemia 16 (0.3%)
HbS-D double heterozygous1 (0.02%)
HbD-β-thalassemia2 (0.04%)
HbD trait5 (0.1%)
HbS-E double heterozygous3 (0.06%) HPFH trait4 (0.08%)
Table 3 — Clinical profile of Haemoglobinopathy patients
Jaundice32% Hepatomegaly20% Splenomegaly14% Growth retardation25%
122, No 09, September 2024Journal
Haemoglobin profile of patients of different Haemoglobinopathy was described in Table 4. The mean Haemoglobin value was found to be lowest in β -Thalassemia major and HbE- β -thalassemia patients.
Thalassemia and Haemoglobinopathies are major health burden in India5. But it varies in prevalence in geographical area to area. Due to different Sociocultural practices, people from tribal group are affected in a great extent. So it is very important to know the prevalence of Haemoglobinopathies in those populations so that preventive strategy can be taken. In the present study, 4997 cases were studied. Among them, abnormal Haemoglobinopathies were detected in 1100 cases. So, the prevalence of the Hb disorders was seen to be 22% which is almost equal to the study result (21.9%) conducted by Nigam, et al11 over Tharu tribal community of Uttar Pradesh. Most common abnormality found was Beta Thalassemia trait estimating 13.5% which is in similar to the study done by Mandal, et al 3 (6.61%) over rural population of West Bengal. In contrast, the study in the tribal population of North-east India by Ghosh, et al12 shows Haemoglobin E was the prevalent trait followed by Haemoglobin S. But, the study among the tribals working in the tea gardens of Assam by Teli, et al showed prevalence of Beta Thalassemia trait of 10% and 31% in the Oraon and Munda ethnic groups of tribal populations coming from West Bengal13. Study by Dolai, et al from the district of undivided West Midnapore has shown prevalence of beta Thalassaemia trait in the community with reported detection rate of Beta Thalassaemia trait of 10.38%14
Another study by Majumdar, et al on beta thalassemia in different tribal population in West Bengal reported prevalence of beta thalassemia over HbE trait from the southern part of Bengal15 The third most common Haemoglobinopathy in the present study is Sickle cell trait (HbS trait) estimating 2% of the total population similar to the study done by Mandal, et al (1.18%)10 Whereas Colah RB, et al showed an incidence of HbS trait of <5% in West Bengal in their study16 But another study by Ray et al in school going children from tribal populations of almost all districts of West Bengal reported HbS in only 0.4% of the study population17 The fourth common Haemoglobinopathy in the present study was HbE trait having prevalence of 1.9% of total population. Whereas in a multicentre study covering mostly city based population showed the prevalence of HbE trait as 3.92% in Kolkata
Table 4 — Mean Hb value of different types of Haemoglobinopathy
Types of HaemoglobinopathyMean Hb
Beta Thalassemia trait9.4
Beta Thalassemia major5.8
Sickle cell trait10.5
HbE trait10.4
HbS disease7.2
Hb E disease7.9
HbS-β-thalassemia6.9
HbE-β-thalassemia6.2
HbS-D double heterozygous6.7
HbD-β-thalassemia8.8
Mohanty D, et al18. In this study, among homozygous or compound heterozygous states (Table 2), beta Thalassemia major (3%) was the commonest followed by HbS beta thalassaemia (0.3%), HbE beta thalassaemia and HbEE disease. Mandal, et al reported HbEE disease as the commonest followed by HbS beta thalassaemia, HbE beta thalassaemia and beta thalassemia major in contrast to our study10 Other types detected in very few numbers are Hereditary Persistence of Fetal Hemoglobin (HPFH) trait (0.08%), HbD trait (0.1%), HbS-D double heterozygous (0.02%), HbD-β-thalassemia (0.04%) and HbS-E double heterozygous in this present study. In our study, congenital hemolytic anemia is more prevalent in females in respect to males (78 % versus 22 %) in contrast to the study by Kumar S, et al. Study where male population is more than female (Table 1). In this study, the mean hemoglobin was found to be lowest in patients of β thalassemia major (5.8gm/ gl) and HbE β thalassemia (6.2 gm/dl) (Table 4). This value is quite similar to the study performed by Kumar S, et al19. Most of the patients present with clinical features of chronic anemia like weakness, fatigability, anorexia, and jaundice along with fever, bone pain, recurrent episodes of infection and hepatosplenomegaly (Table 3). Patients with beta thalassemia major were usually presented with clinical features at very young age than beta thalassemia trait patients and became more severe with advancing age. In case of HbE beta thalassemia, clinical severity increases with age and complications like those of Beta Thalassemia gradually develop. These results were also found in previous studies. Being a single centre based study, only a small fraction of population was screened in the present study. So the screening program needs to involve larger population to get more homogenous results.
High cost of treatment, regular blood transfusion therapy and chelation therapy impose a large social
Vol 122, No 09, September 2024Journal of the Indian Medical Association
and financial burden to the community of socially disadvantaged tribal population. So greater public awareness, thorough screening of carrier patients, premarital education along with prenatal diagnosis is urgently needed to create a community with low prevalence of abnormal Haemoglobinopathy and Thalassemia.
1Weatherall DJ — Hemoglobinopathies worldwide: Present and future. Curr Mol Med 2008; 8: 592-9.
2Iolascon A, De Franceschi L, Muckenthaler M, Taher A, Rees D, de Montalembert M, et al — EHA research roadmap on hemoglobinopathies and thalassemia: An update. Hemasphere 2019; 3: e208.
3Mandal PK, Maji SK, Dolai TK — Present scenario of hemoglobinopathies in West Bengal, India: An analysis of a large population. International Journal of Medicine and Public Health 2014; 4(4): 496-9.
4Madan N, Sharma S, Sood SK, Colah R, Bhatia LM — Frequency of â-thalassemia and other hemoglobinopathies in northern and western India. Indian J Hum Genet 2010; 16: 16-25.
5Weatherall DJ, Clegg JB — Inherited haemoglobin disorders: An increasing global health problem. Bull World Health Organ 2001; 79: 704-12.
6Higgs DR, Engel JD, Stamatoyannopoulos G — Thalassaemia. The Lancet 2012; 379(9813): 373-83.
7Demographic Features. Public Health in West Bengal- Current Status and Ongoing Interventions. Available at: https:// web.archive.org/web/20120107060612/http:/ censusindia.gov.in/2011- prov-results/prov_data_products_ wb.html. Accessed on 24 August 2020.
8Colah R, Italia K, Gorakshakar A — Burden of thalassemia in India: The road map for control. Pediatr Hematol Oncol J 2017; 2: 79-84.
9Public Health in West Bengal–Current Status and Ongoing Interventions. Available at: http://atiwb.gov.in/index_htm_files/ Public%20Health %20in% 20West%20Bengal.pdf. Accessed on 24.
10Mandal PK, Maji SK, Dolai TK, Mandal S, Mondal T — Screening for hemoglobinopathies in a socially disadvantaged population from a rural district of West Bengal, India. International Journal of Research in Medical Sciences 2020; 8 (12): 443035.
11Nigam N, Kushwaha R, Yadav G, Singh PK, Gupta N, Singh B, Agrawal M, et al — A demographic prevalence of â Thalassemia carrier and other hemoglobinopathies in adolescent of Tharu population.
12Ghosh K, Colah RB, Mukherjee MB — Haemoglobinopathies in tribal populations of India. Indian J Med Res 2015; 141(5): 505-8.
13Teli AB, Deori R, Saikia SP — Haemoglobinopathies and βthalassaemia among the tribals working in the tea gardens of Assam, India. J Clin Diagn Res 2016; 10(12): LC19-22.
14Dolai TK, Dutta S, Bhattacharyya M, Ghosh MK — Prevalence of hemoglobinopathies in rural Bengal, India. Hemoglobin 2012; 36(1): 57-63.
15Majumdar D, Basak J, Chakraborty A, Mukhopadhyay S, Pal N, Mukhopadhyay A — Beta thalassemia in different tribal population in West Bengal, India. Blood 2010; 116: 5170.
16Colah RB, Mukherjee MB, Martin S, Ghosh K — Sickle cell disease in tribal populations in India. Indian J Med Res 2015; 141(5): 509.
17Ray R, Roy S, Sarkar A, Chowdhury R, Bhattacharyya M — Near extinction of HbS among the tribes in Bengal: an effect of epistasis. Blood 2017; 130(1): 4777.
18Mohanty D, Colah RB, Gorakshakar AC, Patel RZ, Master DC, Mahanta J, et al — Prevalence of â-thalassemia and other haemoglobinopathies in six cities in India: A multicentre study. J Community Genet 2013; 4: 33-42.
19Kumar S, Singh D, Garg A — An epidemiological study on the clinico-hematological profile of pediatric patients with congenital hemolytic anemia. International Journal of Contemporary Pediatrics 2017; l 4(2): 374-77.

Sayan Kumar Das1, Nisha Prajapati2
Background : A significant problem in the field of global health care is the rise in clinical cases of Multi Drug Resistant (MDR) bacteria. One of the most hazardous superbugs in India as well as in the world is Klebsiella Pneumoniae (KP). The aim of study was to determine the clinical traits and different risk factors of sepsis caused by KP with emphasis on the antibiotic sensitivity pattern in SNCU at a Tertiary Care Centre of Western India.
Materials and Methods : A Retrospective study was done at NICU, Department of Paediatrics, GMERS Medical College, Gandhinagar, Gujarat from 1st January, 2021 to 30th June, 2023 (2.5 years). Study done on with specified inclusion group and analysed on various parameters.
Results : The study comprised of 6576 newborns in total. Out of which 2476 (37.65%) were total sepsis cases. Out of 2476 sepsis cases, 78 (3.15%) comes out to be MDR KP. MDR KP cases shows overlapping Clinical symptoms. The most frequent perinatal risk factor, which occurred in 69.23% of cases, was prolonged labor (>24 hours). In the study it reveals, 92% of the patients, the C-reactive protein (CRP) level was positive followed by Low platelet counts (90.7%). Expiry rates were 1.33%. Colistin (61.53%), Polymyxin B (55.12%), Cefoperazone/Avibactam (51.28%) were among the most sensitive antibiotics to MDR KP strains.
Conclusions : In the Study, it reveals that Maternal Prolonged Labor, Repeated Vaginal Examinations and Sclerema, Oedema, Bleeding etc. developing as early as DOL 4 in the cases are an early suspicion of MDR Klebsiella Sepsis. Severe Thrombocytopenia (Platelet <50,000) along with Increased CRP (>200) and severe low S. Albumin (<2g/dl) on consequent blood investigations is a clue for diagnosis when Culture reports are still awaited. Neonatal care should include regular antimicrobial stewardship Program for appropriate antibiotic therapy in order to limit resistant cases.
[J Indian Med Assoc 2024; 122(9): 28-32]
Key words :Klebsiella Pneumoniae, Multi Drug Resistance, Antibiotic Susceptibility, Antibiotic Stewardship.
Sepsis is one of the main causes of Neonatal Mortality and Morbidity1. A significant problem in the field of global health care is the rise in clinical cases of Multi-Drug Resistant (MDR) bacteria2
One of the most hazardous superbugs in India as well as in the world is Klebsiella Pneumoniae (KP). India is targeting NMR<12 by 2030 as per SDG. At present, we are far away from achieving that and rising trends of Sepsis more specifically MDR cases is one of the major obstacles (Fig 1).
State of Gujarat is one of the most developing states at present in India. If we look into the NMR of Gujarat, it also shows a lack of research in areas of MDR cases to cut short NMR and achieve the SDG targets (Fig 2).
There were substantial rates of MDR (resistance to any three of five antibiotic classes) in Klebsiella pneumoniae, according to clinical and microbiological data from three sizable tertiary care NICUs on 1005
Department of Paediatrics, GMERS Medical College, Gandhinagar, Gujarat 382012
1MBBS, DNB (Paediatrics), Resident and Corresponding Author
2MD (Paediatrics), Associate Professor
Received on : 14/11/2023
Accepted on : 28/11/2023
Editor's Comment :
MDR klebsiella is one of the most notorious organisms causing Neonatal deaths in NICUs of all over the country. Early intervention with timely judicial administration of antibiotics can help to combat the problem which will help us to reduce NMR and get the Target MDG.

Fig 1 — India’s NMR Trends (Source- Niti Aayog’s Report, 2022).
culture-positive cases reported by the Delhi Neonatal Infection Study (DeNIS)3
The mortality burden of antibiotic resistance in India is still largely unstudied, despite the fast rise in MDR Cases and the general recognition of the problem4
Gram-negative bacteria have been linked to an increase in sepsis cases recently, particularly in

developing countries. Unintentional use of broadspectrum antibiotics is a contributing factor to the growth of multi-drug resistant Gram-negative bacteria, according to studies5-7. Klebsiella species are vitally crucial in this regard8-12. This bacteria causes sepsis in 4-9% of cases in affluent countries, whereas it affects 16-28% of cases in less developed nations13
According to a paper from 2016, 12.7% of isolates MDR KP causes various virulent diseases in Germany14. It is unclear what part MDR virulent K pneumoniae strains play in infections in newborns.
MATERIALS AND METHODS
Aims :
To monitor the Outcome of MDR Klebsiella Sepsis among Neonates admitted to NICU.
Objectives :
Primary Objective —
•To study the clinical patterns of MDR KP sepsis.
•The antibiotic sensitivity of MDR Klebsiella pneumoniae.
Secondary Objectives —
•To identify various risk factors of MDR Klebsiella Sepsis
Study Centre : Department of Paediatrics, GMERS Medical College, Gandhinagar.
Study Duration: 1st January, 2021 to 30th June, 2023 (2.5 years).
Study Design : Retrospective Cross-sectional Study.
Sample Size : All the Cases that met our inclusion criteria in the defined period is taken into consideration.
Inclusion Criteria :
• NICU admissions showing positive blood cultures of MDR KP only.
Exclusion criteria :
•Neonates with positive blood culture for any other organism and drug-Sensitive KP.
Criteria for defining MDR, XDR and PDR in Enterobacteriaceae15
MDR : Resistant to >1 drug in >3 antimicrobial categories.
XDR : Resistant to >1 drug in all but <2 categories.
PDR : Resistant to all antimicrobial drugs listed
Data Collection and analysis :
The Hospital Record Section (HRS), which produces daily reports, was used to collect data. Laboratory parameters have been assessed from the case records and the Pathology, Biochemistry and Microbiology departments of our college.
Collected data was entered into MS Excel and analyzed by descriptive statistics. All numeric values were expressed in exact numbers and percentages. All results thus generated are duly complied with and analyzed accordingly.
The study comprised 6576 infants who were hospitalized in the NICU of the GMERS Medical College in Gandhinagar, India. Out of which 2476 (37.65%) were total sepsis cases (both blood culture and septic screen positive). Total Culture Positive 1121 (31.34%). MDR KP 78 and Other Culture Positive (Including Sensitive KP) 1043. 78 (2.18%) of the 3576 neonates were MDR KP. 48 expired, Mortality rate 61.53%. Out of 2476 sepsis cases, There were 1251 (34.98%) preterm low birth weight infants, 286 (7.99%) preterm very low birth weight infants, 23 (0.64%) preterm extremely low birth weight infants, and 2016 (56.37%) term infants (Figs 3&4).
Out of 78 MDR KP cases, Male – 43 (55.06%), Female – 55 (44.94%) and Inborn – 33(42.30%), Outborn – 45(57.30%). So, Occurrence is more in Males and Outborns (Figs 5&6).
Most newborns begin to exhibit symptoms on day four of life, predominantly Late Onset Sepsis (LOS). Out of 78 MDR KP cases, Early Onset Sepsis (EOS) (within 72 hours of Birth) was 11 (14.10%) and LOSwas 67(85.89%). Table 1 display the date the


symptoms first appeared.
The perinatal risk factors that caused the sepsis are listed in Table 2, which demonstrates that a relatively large percentage of the infants had these risk factors. The most frequent risk factor (>24 hours of labor) was observed in 69.23% of cases, whereas the least frequent risk factor Foul-smelling liquor / Maternal fever within 2 weeks (>38oC) was observed in 2.56% of cases. In many instances, many factors were present at the same time.
Table 3 displays the overlapping symptoms and indications of newborns with blood cultures that are positive for KP. The most frequent manifestation was refusal to eat (89.73%), followed by vomiting (78.20%) and shock (70.51%), whereas apnea (8.97%) and convulsion (12.82%) were the least frequent.
KP exhibited resistance to meropenem, vancomycin, amikacin, and amoxicillin-clavulanate in


Table 1 — Onset of Symptoms (n=78)
Onset of SymptomsNumberPercentage Within 48 hours22.56 49-72 hours911.53
Day 44861.53
Day 5-71012.82
Beyond 1st Week911.53
Table 2 — Perinatal risk factors for MDR Klebsiella Sepsis (n=78)
Risk factorsNumberPercentage
Prolonged labour (more than 24 hours)5469.23
Unclean or >3 sterile vaginal examinations1316.66 PROM (more than 18 hours)45.12
Birth asphyxia33.84
Foul-smelling liquor22.56
Maternal fever within 2 weeks (>380C)22.56
Table 3 — Overlapping Clinical Features of MDR Klebsiella cases (n=78)
Symptom/SignNumber Percentage
Feeding Problems (Vomiting, FTT etc)7089.73
Shock (CRT>3 Sec)5570.51 Sclerema4658.97
Generalised Oedema4051.28 Bleeding3848.72 Fever3646.15 Mottling3646.15
Hypothermia2835.89
Abdominal distension1823.07 Lethargy1215.38 Convulsion1012.82 Apnoea78.97
Lab Parameters Percentage
CRP (>200mg/l)92.00
Severe Thrombocytopenia (<50,000/mm3)90.71
Severe Low Serum Albumin (<2g/dl)82.76
Increased WBC (>15,000/mm3)42.91
Increased Hct (>40%)26.94
Mean Platelet Volume (>9.5)21.08
this investigation. Colistin, Polymyxin B, Cefoperazone/Avibactam, were highly sensitive and Linezolid and Aztreonam exhibited moderate sensitivity (Table 4). Out of a total of 78 MDR KP cases, 33 (42.30%) neonates died and 45 (57.69%) made a full recovery. The overall mortality rate among 2476 sepsis patients was 1.33% owing to MDR KP. The beginning of feeding was used to measure clinical progress. On average, feeding began on the fourth day of starting therapy. The causative agent was responsive to intravenous antibiotics, which were given for 14 days.
In our study, it reveals in 92% of the patients, the C-reactive protein (CRP) level was abnormally high (>200mg/l) followed by Severe Thrombocytopenia (Platelet <50,000/mm3) (90.7 %) and Severe Low
Vol 122, No 09, September 2024Journal
Serum Albumin (<2g/dl) (82.7%) Depicted in Table 4. Colistin (61.53%), Polymyxin B (55.12%) and Cefoperazone/Avibactam (51.28%) were among the most sensitive antibiotics to MDR KP strains shown in Table 5 with all the others sensitive antibiotics.
In the Study, it reveals that Maternal Prolonged Labor, Repeated Vaginal Examinations and sclerema, Oedema, Mottling, Bleeding etc. developing as early as DOL 4 in the cases are an early suspicion of MDR Klebsiella Sepsis.
Severe Thrombocytopenia (Platelet <50,000) along with Increased CRP (>200) and severe low S Albumin (<2g/dl) on consequent blood investigations is a clue for diagnosis when Culture reports are still awaited. In contrast to our research, other investigations have found KP to be very resistant to Meropenem and Colistin16,17
We may infer from the results of our combined data that there are currently very few antibiotics that can effectively treat KP and the cost of these drugs are quite high in the open market. One study showed that the mean cost of treatment for MDRO Sepsis was INR 4,99,840 versus INR 180,592 for non-MDRO Sepsis18
We evaluated the different KP infection risk variables. We found that inborn newborns and neonates with birth weights under 2.5 kg were more vulnerable to KP infection. In general, birth weight and infection rate are inversely associated. This explains why newborns with birth weights under 2.5 kg were more likely to get KP infection. To reduce mortality from newborn Sepsis in low birth weight infants, prevention, early detection and early treatment are essential.
The capacity of this bacterium to live in the ICU environment and infect quickly, causing outbreaks, puts inborn newborns at higher risk for KP infection. Even though preterm newborns were shown to have a higher risk of KP infection. This may be brought on by the overall rise in the likelihood that viruses other than KP would infect preterm newborns. Prematurity was found to be one of the commonest risk factors for newborn Sepsis in research by Shitaye, et al19 , regardless of the pathogen.
In contrast to our research, other investigations have found KP to be susceptible to Meropenem. The KP pathogens were very resistant to Meropenem and highly susceptible to colistin/polymyxin B20
Limitation :
This study has three main flaws. First, some
Table 5 — Drug Sensitive to MDR Klebsiella pneumoniae DrugsNumberPercentage
Colistin (Intermediate Sensitive)4861.53
Polymyxin B4355.12
Ceftazidime/Avibactam4051.28
Aztreonam3342.30
Meropenem2126.92
Piperacillin-tazobactam56.41
Levofloxacin33.84
Ampicillin00
Gentamycin00
Cefotaxime/Ceftriaxone00
Ceftaroline00
Netilmicin00
Amoxicillin/ Amoxicillin-clavulanic acid00
Amikacin00
antibiotic disks periodically ran out of stock, which resulted in irregular antibiogram reporting. Second, the number of isolates per type of organism was insufficient for all bacteria, since CLSI advises at least 10 isolates/species of organism for a highly efficient antibiogram. Third, another restriction is the limitation of molecular typing in all MDR KP Cases to know the exact strain causing the Sepsis cases.
Before starting antibiotics, every effort should be taken to collect samples for culture and sensitivity testing. The most likely pathogens for the infection site should be known, as well as information on the patient’s background (such as previous hospitalizations, exposure at work, travel and pet ownership) and area susceptibility. All patients taking antibiotics should be continuously checked for adverse drug responses and the disappearance of infectious signs and symptoms, such as a decline in fever and white blood cell count. Through antibiotic stewardship programs clinicians should strive toward optimizing antibiotic usage, appropriate drugs whenever needed and for correct duration.
Numerous findings from studies conducted across the world demonstrate that MDR bacteria are spreading around the world and posing serious threats to public health and healthcare21. We may infer from the results of our combined data that there are currently very few antibiotics that can effectively treat KP.
To create potential long-term solutions to combat resistance, more societal funding is required for basic and applied research as well as policy-related efforts. A few of the interventions on this list include using novel business models to encourage investment in antibiotic therapies, curving the spread of antibiotic resistance to lengthening the useful lives of antibiotics, discovering fresh methods to directly combat virulent
Vol 122, No 09, September 2024Journal of the Indian Medical Association
agents without fostering resistance and changing host-agent interactions to modify disease without directly combating microbes. In the past ten years, research on genomic mutations and the use of bacteriophages has shown promise since these more creative forms of stewardship may be utilized to create treatments that do not promote resistance.
Authors would like to acknowledge all the Nursing staffs, Data entry operator, Junior residents and Microbiology Department for helping in data collection and encouraging during the entire study.
1Stoll BJ — Infections of the neonatal infant. In: Nelson Textbook of Pediatrics, Behrman Ed., Kleigman RE, RM, Jenson HB. Philadelphia: W.B. Saunders. 17th ed. 2004: 623-39.
2Edwards MS — Postnatal infections In: Fanaoff and Martins Neonatal-perinatal Medicine. 8th ed. Philadelphia: Mosby Elsevier; 2006: 791-804.
3Investigators of the Delhi Neonatal Infection Study (DeNIS) Collaboration. Characterisation and antimicrobial resistance of sepsis pathogens in neonates born in tertiary care centres in Delhi, India: a cohort study. Lancet Glob Heal 2016; 4: e752–60.
4Bakr AF— Intravenous lines related sepsis in newborn babies admitted to NICU in a developing country. J Trop Pedia 2003; 49(5): 295-7.
5Joshi SG, Ghole VS, Niphadkar KB — Neonatal Gram-negative bacteremia. Indian J Pediatr 2000; 67(1): 27-32.
6Köksal N, Hacimustafaoðlu M, Baðci S — Meropenem in neonatal severe infections due to multiresistant gram-negative bacteria. Indian J Pediatrics 2001; 68(1): 15-9.
7Roilides E, Kyriakides G, Kadiltsoglou I, Farmaki E, Venzon D, Katsaveli A, et al — Septicemia due to multiresistant Klebsiella pneumoniae in a neonatal unit: a case-control study. Am J Perinatol 2000; 17(01): 035-40.
8Stoll BJ, Hansen N, Fanaroff AA,Wright LL, CarloWA, Ehrenkranz RA, et al — Late-onset sepsis in very low birth weight neonates: the experience of the NICHD Neonatal Research Network. Pediatrics 2002; 110: 285-91.
9Zaidi AK, Thaver D, Ali SA, Khan TA — Pathogens associated with sepsis in newborns and young infants in developing countries. Pediatr Infect Dis J 2009; 28(Suppl. 1): S10-8.
10Vergnano S, Menson E, Kennea N, Embleton N, Russell AB, Watts T, et al — Neonatal infections in England: the Neon in surveillance network. Arch Dis Child Fetal Neonatal Ed 2011; 96: F9-14.
11Zea-Vera A, Ochoa TJ — Challenges in the diagnosis and management of neonatal sepsis. J Trop Pediatr 2015; 61: 113.
12Shon AS, Bajwa RP, Russo TA. Hypervirulent (hypermucoviscous) Klebsiella pneumoniae: a new and dangerous breed. Virulence 2013; 4: 107-18.
13Podschun R, Ullmann U — Klebsiella spp. as nosocomial pathogens: epidemiology, taxonomy, typing methods, and pathogenicity factors. Clin Microbiol Rev 1998; 4: 589-603.
14Haller S, Eller C, Hermes J, Kaase M, Steglich M, Radonic A, et al — What caused the outbreak of ESBL-producing Klebsiella pneumoniae in a neonatal intensive care unit, Germany 2009 to 2012? Reconstucting transmission with epidemiological analysis and whole-genome sequencing. BMJ 2015; 5: e007397
15Bialek-Davenet S, Criscuolo A, Ailloud F, Passet V, Jones L, Delannoy-Vieillard AS, et al — Genomic definition of hypervirulent and multi drug resistant Klebsiella pneumoniae clonal groups. Emerg Infect Dis 2014; 20: 1812-20.
16Yu WL, Ko WC, Cheng KC, Lee HC, Ke DS, Lee CC, et al— Association between rmpA and magA genes and clinical syndromes caused by Klebsiella pneumoniae in Taiwan. Clin Inect Dis 2006; 42: 1351-8.
17Zhang R, Lin D, Chan EW, Gu D, Chen GX, Chen S — Emergence of carbapenem-resistant serotype K1 hypervirulent Klebsiella pneumoniae strains in China. Antimicrob Agents Chemother 2015; 60: 709-11.
18Oberoi JK, Wattal C — Neonatal sepsis: an outcome study at a tertiary care centre in New Delhi, India. Poster & Oral presentation presented at “1st Global Forum on Bacterial Infections” at New Delhi on 3–5 October 2011.
19Shitaye D, Asrat D, Woldeamanuel Y, Worku B — Risk factors and etiology of neonatal sepsis in Tikur Anbessa University Hospital, Ethiopia. Ethiop Med J 2010; 48: 11-21.
20Surgers L, Boyd A, Girard PM, Arlet G, Decré D — ESBLproducing strain of hypervirulent Klebsiella pneumoniae K2, France. Emerg Infect Dis 2016; 22: 1687-8.
21Zhang Y, Zhao C, Wang Q, Wang X, Chen H, Li H, et al — High prevalence of hypervirulent Klebsiella pneumoniae infection in china: geographic distribution, clinical characteristics, and antimicrobial resistance. Antimicrob Agents Chemother 2016; 60: 6115-20.
Nidhi Dikshit1, Ayan Basu2, Nitin Arun Dikshit3, Gunjan H Prasad4
Background : Autoimmune Haemolytic Anaemia (AIHA) is defined as decreased red cell survival or increased destruction, secondary to antibodies directed against own red blood cells. The disease is heterogeneous, with symptoms ranging from fully compensated asymptomatic patients to patients presenting with rapid onset of life-threatening Anaemia.
Aims and Objectives : The main objective of our study was to distinguish Warm antibody-induced AIHA from Cold antibody-induced AIHA on the basis of immunoglobulin class of the antibody. The secondary objectives were to study the type of antibody, result of Direct Antiglobulin Test (DAT), thermal amplitude of involved antibody and to study the association of severity of anaemia with various laboratory parameters and to assess the response of different treatment modalities used to treat AIHA.
Materials and Methods : It was an observational prospective study. Fifty patients diagnosed with AIHA were taken and were categorised on the basis of antibody types, severity of haemolysis and other laboratory parameters.
Results : The parameters, which had the greatest impact on severity of haemolysis were the patients of primary AIHA, patients with multiple auto-antibodies, complement fixation and strength of DAT.
Conclusion : In this study the association of strength of DAT and severity of disease suggest that an algorithm should be designed for testing patients with DAT positive AIHA with a monospecific DAT and IgG subtype analysis. It may allow for identification of this critical subgroup of patients in whom more intense clinical intervention and close follow up might be indicated. Also, the subtyping may help in better treatment as it has been shown in many studies that steroids are more effective first line therapy in warm AIHA while Cold Agglutinin Disease (CAD) show better response to Rituximab.
[J Indian Med Assoc 2024; 122(9): 33-9]
Key words :Autoimmune Haemolytic Anaemia, Warm AIHA, Cold Agglutinin Disease, Direct Antiglobulin Test.
Autoimmune Haemolytic Anaemia (AIHA) is a clinical condition in which antibodies bind to patient’s own red cell surface antigens and initiate red cell destruction. It is classified as either autoimmune, alloimmune or drug induced based on the antigenic stimulus responsible for the immune response1. The peak incidence is in between 60 and 70 years of age. The disorder is usually more common in females2. It can be idiopathic (50%), secondary to lymphoproliferative diseases (20%), autoimmune (20%), infection and tumours3
The disease is heterogeneous with symptoms ranging from fully compensated disease to lifethreatening anaemia. It should be suspected in a patient presenting with symptoms attributable to
1MD, PDF (Clinical Haematology), Assistant Professor, Department of Haematology, Calcutta School of Tropical Medicine, Kolkata 700073
2DM (Infectious Diseases), Associate Professor, Department of Infectious Diseases, IPGME&R and SSKM Hospital, Kolkata 700020 and Corresponding Author
3MD (Radiodiagnosis), Assistant Professor, Department of Radiodiagnosis, King George's Medical University, Lucknow 226003
4MD, DNB (Clinical Haematology), Post Doctoral Fellow, Apollo Gleneagles Hospital, Kolkata 700054
Received on : 27/12/2023
Accepted on : 29/07/2024
Editor's Comment :
Extended DAT should be done in patients with AIHA as it will help to plan the first line therapy.
The strength of DAT generally correlates with the severity of AIHA.
The parameters like LDH may be used as marker to follow up such patients and may help in predicting relapse as specialised tests like DAT may not be available at all centres.
anaemia such as easy fatiguability, dyspnoea, palpitation in the absence of obvious causes like nutritional deficiency, bleeding etc and symptoms of haemolysis eg, jaundice.
Laboratory parameters helpful for diagnosis are Complete Blood Count (CBC), Direct Antiglobulin Test (DAT), Reticulocyte Count, Serum Lactate Dehydrogenase (LDH) and indirect hyperbilirubinemia. DAT helps in differentiating immune from non-immune causes.
The autoantibodies agglutinate, sensitize or cause lysis of their own red blood cells. Destruction of red cells causes anaemia and jaundice and without timely intervention, it can be fatal in some patients. The factors that have an impact on the severity of haemolysis include antibody quantity, antibody specificity, thermal amplitude, ability to bind to tissue
122, No 09, September 2024Journal
macrophages and ability to fix complement. Multiple immunoglobulins molecules coating red cells are one of the major causes of haemolysis4. IgG antibodies are relatively poor activator of classical complement pathways but IgG1 and IgG3 are readily recognised by Fc receptors on reticuloendothelial cells. IgG3 autoantibody is most effective in bringing about red cell destruction. Patients’ response to treatment correlated with the type of IgG subclasses5. Currently there are no guidelines regarding strength of DAT positivity and the severity of haemolysis.
The initial treatment aims to stabilise the patient and blood is transfused if patient has severe symptoms. In hemodynamically stable patients consideration of Packed Red Blood Cell (PRBC) transfusion to maintain haemoglobin of 7g/dl. For patients who are experiencing cardio-pulmonary symptoms due to anaemia, PRBC transfusion should not be withheld regardless of haemoglobin level.
The treatment response is varied and not all patients respond to initial treatment. Glucocorticoids are considered the first-line treatment in Warm AIHA. Splenectomy is effective second-line treatment but has never been compared with other treatments. The response rate of splenectomy is 60%-90%. Treatment of Cold agglutinin disease generally depends on etiology. In cases of severe haemolysis immunosuppression with chlorambucil or cyclophosphamide may be useful6. Significant responses are also seen with interferon7. Response to steroid is seen in low titre disease. The response to splenectomy is not as effective as in majority of cases haemolysis occurs in liver8. Single-agent rituximab is currently considered the first-line systemic therapy for CAD due to its good efûcacy and tolerability.
Aims : In view of the lack of any homogenous data in Indian population, the present study including a series of 50 AIHA cases in Eastern India, aimed at investigating the aetiology, pathogenesis, clinicohaematological profile and efficacy of the treatment.
Objectives : The primary objective of our study was to distinguish Warm antibody-induced AIHA from Cold antibody-induced AIHA on the basis of immunoglobulin class of the antibody.
The secondary objectives were to study the type of antibody, result of Direct Antiglobulin Test (DAT), thermal amplitude of involved antibody and to study the association of severity of anaemia with various laboratory parameters and to assess the response of different treatment modalities used to treat AIHA.
We studied all patients whether newly diagnosed or on treatment or on post treatment follow-up with initial diagnosis of AIHA. The severity of haemolysis was classified into severe or moderate based on study criteria laid down by Wheeler, et al9
The laboratory parameters used to categorize severity of haemolysis are-
(1) Haemoglobin <9g/dl
(2) Indirect Bilirubin >2mg/dl
(3) Reticulocytes (>2%)
(4) LDH > 500IU/ml.
The patients were enrolled on the basis of the following categories-
(1) First time diagnosed to have AIHA.
(2) Patients already diagnosed to have AIHA and on treatment at the time of analysis.
(3) Previously diagnosed to have AIHA, currently relapsed after stopping treatment.
Patients were classified as having primary or secondary AIHA based on the history, laboratory and radiological results.
We used Column Agglutination Technique (CAT) to serologically characterize the autoantibodies. Polyspecific Direct Antiglobulin Test (DAT) was performed using Low Ionic Strength Saline (LISS) Coombs ID card to identify the presence of IgG and complement. The Coomb’s positive patients were further tested using monospecific DAT LISS Coombs ID to identify the presence of immunoglobulins such as IgG, IgA, IgM and complement C3d, C3c. Results of DAT were graded from 0 to 4 as per manufacturer’s recommendations (Fig 1) and strength of DAT was interpreted by two individuals individually.

Interpretation :
(A) Positive: Agglutinated cells form a red line on the surface of the gel (strong reaction) or the agglutinates tend to disperse in the gel in a weaker reaction.
(B) Negative: Unagglutinated RBCs form a welldefined button at the bottom of the microtube.
The results of the test are graded as shown in Fig 1. The reaction on the card was read from both the sides and interpreted by two individuals independently to avoid interpretation error.
1+Reaction — RBC agglutinates are observed predominantly in the lower half of the gel microtube. Unagglutinated RBCs form a button in the bottom of the microtube
2+Reaction — RBC agglutinates are dispersed throughout the length of the gel microtube. Few unagglutinated RBCs may be observed in the bottom of the microtube.
3+ Reaction — The majority of RBC agglutinates are trapped in the upper half of the gel microtube.
4+ Reaction — A solid band of RBC agglutinates on top of the gel. A few agglutinates may filter into the gel but remain near the predominant band.
Weak Reaction — Granular suspension
MF Reaction — Mixed field agglutination / double population- RBC agglutinates at the top of the gel or is dispersed throughout the gel microtube accompanied by a button of negative red blood cells in the bottom of the microtube
Clinical and laboratory data relevant to the study were collected. These were age, gender, presence or absence of organomegaly, causes of secondary AIHA, new onset of AIHA or already diagnosed patients on treatment or relapsed AIHA.
OBSERVATIONS AND RESULTS
Fifty patients of any age/sex whether newly diagnosed / on treatment / on post treatment follow up with initial diagnosis of AIHA were included in the study. The medical records were analyzed for the demographic data (age and sex), clinical features, co-morbid conditions, investigations, mode and results of the treatment.
In our study, 66.00% of patients were Females and 34.00% of patients were Males. Mean age (years) was 45.88 ± 20.2 with median. In our study, majority (60.00%) of patients had primary AIHA. Only 20 out of 50 patients (40.00%) had secondary AIHA. The majority (60.00%) of patients were diagnosed as Warm AIHA followed by Cold AIHA (30.00%). Diagnosis was mixed AIHA in only 5 out of 50 patients (10.00%) (Table 1).
Table 1 — Distribution of
In majority 39 (78.00%) of patients there was no history of blood transfusion. The majority (76.00%) of patients had moderate anaemia. In 12 out of 50 patients (24.00%) had severe anaemia. Mean value of haemoglobin (g/dL) of study subjects was 5.86 ± 1.02 with median (25th-75th percentile) of 5.9 (5.2256.2). The mean value of haematocrit (%) was 17.63 ± 3.48, retic count (%) was 6.34 ± 2.03, total bilirubin (mg/dL) was 3.06 ± 1.58, indirect bilirubin (mg/dL) was 2.43 ± 1.41, LDH (U/L) was 889.1 ± 476.86, total leucocyte count (cells/mm³) was 11809.68 ± 20660.9 and platelet count (cells/mm³) was 2.45 ± 1.35. The median haematocrit was 17.7 (15.225-18.6), reticulocyte count was 6.15 (4.825-7.2), total bilirubin was 2.8 (1.925-3.975), indirect bilirubin was 2.05 (1.425-3.2), LDH was 760 (562.25-1045), Total Leucocyte Count was 7596.5 (5992.5-8701.75) and Platelet Count was 2.46 (1.7-3.098) respectively.
On clinical examination, fatigue was the most common symptom followed by pallor. Fatigue was present in 58.00% of patients, pallor in 56.00%, dyspnoeal and splenomegaly in 38.00%, jaundice in 12.00%, haematuria in 6.00%, fever in 10.00%, weakness in 8.00%, lymphadenopathy in 4.00%, lumbar region pain in 4.00% and anaemia in 4.00%. Clinical features were nose bleeding, hepatosplenomegaly, ascites, shortness of breath on exertion, pericardial effusion, joint pain and abdominal pain in only 1 out of 50 patients (2.00%) each.
The most common Blood Group was 'O' positive (42.00%) followed by 'A' Positive (32.00%) and 'B' Positive (24.00%). Blood Group was 'AB' Positive of only 1 out of 50 patients (2.00)
Distribution of DAT grade of study subjects — In present study, in majority (46.00%) of patients DAT grade was 3+, followed by 4+(38.00%) and 2+ (12.00%). DAT grade was 1+ in only 2 out of 50 patients (4.00%) (Table 2).
Table 2 — Distribution of
122, No 09, September 2024Journal
Distribution of extended DAT of study subjects
In present study, in majority (42.00%) of patients, extended DAT was only IgG followed by IgG + Others (34.00%). Extended DAT was only C3D in only 12 out of 50 patients (24.00%) (Table 3).
In the present study, in majority (84.00%) of patients, underlying alloantibody were not detected. Underlying alloantibody was detected in only 8 out of 50 patients (16.00%). The majority (60.00%) of patients were idiopathic. Amongst the remaining patients (40%) the common causes were Chronic liver disease (6.00%), Systemic lupus erythematosus (6.00%), Lymphoma (6.00%) and ANA positivity (4.00%). 1 out of 50 patients (2.00%) was diagnosed with paroxysmal cold haemoglobinuria.
In majority (68.00%) of patients, first line therapy given was steroids followed by Rituximab (20.00%). The majority (64.00%) of patients had complete response after first line therapy and partial response was seen in (36.00%). In majority 31 out of 50 pateints (62.00%) second line therapy was not required. In patients with partial response, 13 out of 18 (72.22%) had complete response after second line therapy. In 1 out of 50 patients (2.00%) died because of disease relapse.
Distribution of diagnosis was comparable between severity of anaemia (Severe versus Moderate). (Cold AIHA:- 25% versus 31.58% respectively, Mixed AIHA:8.33% versus 10.53% respectively, Warm AIHA:66.67% versus 57.89% respectively) (p-value=0.886).
Distribution of history of blood transfusion was comparable between severity of anaemia (Severe versus Moderate). (8.33% versus 26.32% respectively) (p value=0.257).
Significant association was seen in LDH (U/L) with severity of anemia (p-value <0.05). Mean ± SD of LDH (U/L) in severe anemia was 1213.83 ± 427.73, which was significantly higher as compared to moderate anemia (786.55 ± 449.17) (p value=0.006). No significant association was seen in reticulocyte count (%) (p value=0.91), total bilirubin (mg/dL) (p value=0.841), indirect bilirubin (mg/dL) (p value=0.952) with severity of anemia. Mean±SD of reticulocyte count (%), total bilirubin (mg/dL), indirect bilirubin (mg/dL) in severe anemia was 6.28 ± 1.99, 2.98 ± 1.48, 2.41 ± 1.41 respectively and in moderate anemia was 6.36 ± 2.07, 3.08 ± 1.62, 2.44 ± 1.43 respectively with no significant association between them.
Association of blood group with severity of anaemia — Distribution of blood group was comparable between severity of anaemia (Severe
Table 3 — Distribution of extended DAT of study subjects
Extended DATFrequencyPercentage
Only IgG2142.00%
Only C3D1224.00%
versus Moderate). (A Positive:- 33.33% versus 31.58% respectively, AB Positive:- 0% versus 2.63% respectively, B Positive:- 33.33% versus 21.05% respectively, O Positive:- 33.33% versus 44.74% respectively) (p value=0.682).
Association of DAT grade with severity of anaemia — Distribution of DAT grade was comparable between severity of anaemia (Severe versus Moderate). (1+:- 0% versus 5.26% respectively, 2+:8.33% versus 13.16% respectively, 3+:-41.67% versus 47.37% respectively, 4+:- 50% versus 34.21% respectively) (p-value=0.798) (Table 4).
Association of extended DAT with severity of Anaemia — Distribution of extended DAT was comparable between severity of Anaemia (Severe versus Moderate). (Only IgG:- 33.33% versus 44.74% respectively, Only C3D:- 16.67% versus 26.32% respectively, IgG + Others:- 50% versus 28.95% respectively) (p value=0.482) (Table 5).
Association of complete/partial response after first line therapy— Distribution of complete/partial response after first line therapy was comparable between first line therapy (Rituximab, steroids, chemotherapy, others). (Complete response:- 90% versus 55.88% versus 50% versus 75% respectively, Partial response:- 10% versus 44.12% versus 50% versus 25% respectively) (p-value=0.174).
Autoimmune Haemolytic Anaemia (AIHA) is a collective term for several diseases characterized by
Table 4 — Association of DAT grade with severity of Anaemia DATModerateSevereTotalP value grade(n=38)(n=12)
1+2 (5.26%)0 (0%)2 (4%)0.798
2+5 (13.16%)1 (8.33%)6 (12%)
3+18 (47.37%)5 (41.67%)23 (46%)
4+13 (34.21%)6 (50%)19 (38%)
Total38 (100%)12 (100%)50 (100%)
Table 5 — Association of extended DAT with severity of Anaemia
ExtendedModerateSevereTotalP value DAT(n=38)(n=12)
Only IgG17 (44.74%)4 (33.33%)21 (42%)0.482
Only C3D10 (26.32%)2 (16.67%)12 (24%)
IgG + Others11 (28.95%)6 (50%)17 (34%)
Total38 (100%)12 (100%)50 (100%)
122, No 09, September 2024Journal
autoantibody-initiated destruction of red blood cells10. It is greatly heterogeneous, with symptoms ranging from fully compensated to patients presenting with fulminant, rapid onset of life-threatening Anaemia10 Immunoglobulin class, subclass, titre, ability to activate complement, thermal amplitude and strength of Direct Antiglobulin Test (DAT) have been implicated as factors affecting the severity of the disease11,12. In view of this, it becomes very important to identify patients who are at risk of severe haemolysis, so that treatment and management is initiated under close supervision. With this background this study was undertaken, to serologically characterize the auto antibodies resulting in AIHA in the Indian population and to analyse the correlation between severity and the various factors implicated in AIHA along with assessment of treatment outcomes with various therapeutic strategies.
The incidence of AIHA is 0.8 to 1/80,000 to 1,00,000/year in western population 6,7 and the reported prevalence is 17/100,00013. In literature there are no population-based studies for incidence and prevalence of AIHA from India. It is known from various studies that frequency of AIHA is usually greater in females than in Males6,14. Similar trend was seen in our study with a Male : Female ratio of 1:1.9. This finding was in accordance with an Indian study by V Alwar, et al where it was noted that male: female ration was 1:2.214
Naithani, et al (2006) studied the clinicohaematological profile and treatment outcome of patients with Autoimmune Haemolytic Anaemia (AIHA)15. There were 79 (52 primary; 27 secondary) consecutive patients identiûed with a median age of 30.5 years. The main presenting complaints were pallor (94%), jaundice (51%), and splenomegaly (68%). Jaundice was much more common in primary (63%) as opposed to secondary (26%) AIHA. The direct antiglobulin test was negative in six patients which shows us the importance of clinical examination and aniciliary tests. Oral prednisolone produced remission in 87.5% patients. Six patients (three children, three adults) relapsed after a median period of 2 months after response. All of these responded to a second course of steroids, in a median period of 14 days. No correlation was found between response and the parameters like age, sex, jaundice, low pretreatment haemoglobin, reticulocyte count, Total Leucocyte Count (TLC), Platelet Count, subtype of AIHA and hepatosplenomegaly. The only factor which predicted relapse was increased duration between the onset of symptoms and start of treatment (r = 0.996; p=0.0001)15
Primary AIHA affects all age groups with the peak incidence of disease in the fourth and fifth decades. Secondary AIHA reflects the age distribution of the underlying disease. For example, in the case of SLE, AIHA tends to present at much earlier age group and if AIHA is secondary to lymphoproliferative disorder, it tends to present in a relatively older age group. In our study, the median age group of AIHA patient was 47.5 years (Range 3-78 years). The most common secondary cause of AIHA was autoimmune disorders (10%).
Haemolysis was classified into severe and moderate based on study criteria laid down by Das SS, et al16. Of the total patients, 24% were categorised to have severe haemolysis. The severity of haemolysis was higher in patients with primary AIHA (68.2%) as compared to patients with secondary AIHA (31.8%). The association of primary AIHA with severe haemolysis was statistically significant with p<0.001.
Das SS, et al (2018) studied patients of “mixed” AIHA (M-AIHA), characterizing M-AIHA both clinically and serologically13. Out of 134 AIHA patients, 13 diagnosed as M-AIHA were subjected to detailed immune-hematological characterization. Most patients were severely anaemic and required urgent transfusions. The median age of patient was 37 years with a female preponderance and secondary M-AIHA was observed in 8 (61.5%) patients13
In present study, in majority (84.00%) of patients, underlying alloantibody was not detected. Adsorption study and underlying alloantibody were detected in only 8 out of 50 patients (16.00%). The majority of patients were idiopathic followed by secondary causes like Chronic Liver Disease (6.00%), Systemic Lupus Erythematosus (6.00%), Lymphoma (6.00%) and ANA positivity (4.00%). Associated disorder was paroxysmal cold haemoglobinuria in only 1 out of 50 patients (2.00%).
Berensten, et al (2004) studied treatment with the anti-CD20 antibody rituximab for chronic Cold Agglutinin Disease (CAD)17. Thirty-seven courses of rituximab were administered prospectively to 27 patients. 14 of 27 patients responded to their first course of rituximab, and 6 of 10 responded to retreatment. In both groups combined, responses were achieved after 20 of 37 courses, giving an overall response rate of 54%. They observed 1 complete and 19 partial responses. Two non-responders and three patients who experienced relapse received secondline therapy with interferon-α combined with a new course of rituximab and one non-responder and two patients who experienced relapse achieved partial responses17
In present study, majority (64%) of patients had complete response after first line therapy. Partial response was seen in only 18 out of 50 patients (36%). First line therapy was failed in only 17 out of 50 patients (34%). In majority (62.00%) of patients, second line therapy was not required. Second line therapy was required in only 19 out of 50 patients (38%). Majority (72.22%) of patients had complete response after second line therapy. Partial response was seen in only 5 out of 18 patients (27.78%). One out of 50 patients died of AIHA.
Hantaweepant, et al (2019) investigated among the Thai patients the efficacy and safety of secondline treatment in primary warm-type AIHA that failed corticosteroid treatment 18 . This retrospective descriptive study included patients aged >14 years who were diagnosed with and treated for primary warm-type AIHA at the Haematology division of the Medicine Department, Siriraj Hospital, Mahidol University, Bangkok, Thailand. All 54 included patients failed first-line corticosteroid treatment after which second-line treatment was prescribed. Majority (83.3%) of the included patients were female and had a mean age at onset of 55.8 years (14.5-87.4). Most patients (63%) were refractory to steroids, and the rest of them relapsed while on steroids. The secondline medications were azathioprine (61.1%), cyclophosphamide (31.5%), danazol (3.7%), rituximab (1.9%) and chlorambucil (1.9%) and with respective response rates of 78.8%, 58.8%, 2/2 patient, 0/1 patients and 1/1 patient. Strong positive direct Coombs’ test (3+ to 4+) was the only predictive factor of treatment response (p = 0.008). Males had better relapse-free survival than females (not reached versus 20.6 months) (p = 0.023).
Distribution of complete/partial response after first line therapy was comparable between first line therapy (Rituximab, steroids, chemotherapy, others). (Complete response:- 90% versus 55.88% versus 50% versus 75% respectively, Partial response:- 10% versus 44.12% versus 50% versus 25% respectively) (p-value=0.174).
Fan, et al (2016) analyzed 68 children diagnosed as AIHA and showed that 39.7% of all patients had primary AIHA whereas 60.3% had secondary AIHA19 Average haemoglobin was lower in the <1-year age group than > 1-year age group, IgM containing group than non-IgM containing group and combinedantibody group than single-antibody group (p < 0.05 for all). Twenty nine cases (29/45, 64.4%) remained in continuous remission during the follow-up period. After first complete remission, total 35.6% patients
relapsed but after relapse still 56.3% of them responded to glucocorticoid19
In present study majority (60.00%) of patients had primary AIHA while 40.00% had secondary AIHA. In the present study, in majority (60.00%) of patients, diagnosis was warm AIHA followed by cold AIHA (30.00%). Diagnosis was mixed AIHA in only 5 out of 50 patients (10.00%).
Distribution of gender was comparable between severity of anaemia. Females had more severe anaemia as compared to males. Distribution of primary/ secondary AIHA was comparable between severity of anaemia. Cold and mixed AIHA had more severe disease. The higher LDH levels were associated with more severe disease. No significant association with severity was seen with reticulocyte count and bilirubin. Distribution of DAT grade was comparable between severity of anaemia, higher DAT positivity was associated with higher severity. Distribution of extended DAT was comparable between severity of anaemia (Severe and Moderate). (Only IgG:- 33.33% versus 44.74% respectively, Only C3d:- 16.67% versus 26.32% respectively, IgG + Others:- 50% versus 28.95% respectively) (pvalue=0.482). Distribution of complete/partial response after first line therapy was comparable between first line therapy.
The auto-antibodies profile identified in patients with AIHA was predominantly IgG along with complement followed by a few cases of complement alone and occasional cases with IgM and IgA. The parameters, which had the greatest impact on severity of haemolysis are primary AIHA, presence of multiple auto-antibodies, complement fixation and strength of DAT. Those with subtypes had significantly greater risk of severe haemolysis when compared with patients having negative for the same. The association in this study of DAT strength and complement fixation on severity of haemolysis suggest that an algorithm of following up DAT positivity in patients with AIHA with a monospecific DAT and IgG subtype analysis will allow for identification of this critical subgroup of patients in whom more intense clinical intervention and close follow-up might be indicated. Steroids are effective as first line therapy in Warm AIHA while CAD show better response to Rituximab.
1Gehrs BC, Friedberg RC — Autoimmune hemolytic anemia. Am J Hematol 2002; 69(4): 258-71. doi: 10.1002/ajh.10062
Vol 122, No 09, September 2024Journal of
2Chaudhary RK, Das SS — Autoimmune hemolytic anemia: From lab to bedside. Asian J Transfus Sci 2014; 8(1): 5-12. doi: 10.4103/0973-6247.126681
3Valent P, Lechner K — Diagnosis and treatment of autoimmune haemolytic anaemias in adults: a clinical review. Wien Klin Wochenschr 2008; 120(5-6): 136-51. doi: 10.1007/ s00508-008-0945-1
4Sokol RJ, Booker DJ, Stamps R — The pathology of autoimmune haemolytic anaemia. J Clin Pathol 1992; 45(12): 104752. doi: 10.1136/jcp.45.12.1047
5Z Li , Z Shao, Y Xu, L Shen, G Chen, Y Zhang, Y Chu — Subclasses of warm autoantibody IgG in patients with autoimmune hemolytic anemia and their clinical implications. Chin Med J (Engl) 1999; 112(9): 805-8.
6Evans RS, Baxter E, Gilliland BC — Chronic hemolytic anemia due to cold agglutinins: A 20-year history of benign gammopathy with response to chlorambucil. Blood 1973; 42: 463-70.
7O’Connor BM, Clifford JS, Lawrence WD, Logue GL — Alpha-interferon for severe cold agglutinin disease. Ann Intern Med 1989; 111: 255-6.
8Silberstein LE, Berkman EM, Schreiber AD — Cold hemagglutinin disease associated with IgG cold-reactive antibody. Ann Intern Med 1987; 106: 238-42.
9Wheeler CA, Calhoun L, Blackall DP — Warm reactive autoantibodies: clinical and serologic correlations. Am J Clin Pathol 2004; 122(5): 680-5.
10Junjie Fan, Hailong He, Wenli Zhao, Yi Wang, Jun Lu, Jie Li, et al — Clinical Features and Treatment Outcomes of Childhood Autoimmune Hemolytic Anemia: A Retrospective Analysis of 68 Cases. J Pediatr Hematol Oncol 2016; 38(2)
11Sokol RJ, Hewitt S, Booker DJ, Bailey A — Red cell autoantibodies, multiple immunoglobulin classes, and autoimmune hemolysis. Transfusion (Paris) 1990; 30(8): 714-7.
12Wikman A, Axdorph U, Gryfelt G, Gustafsson L, Björkholm M, Lundahl J — Characterization of red cell autoantibodies in consecutive DAT- positive patients with relation to in vivo haemolysis. Ann Hematol 2005; 84(3): 150-8.
13Das SS, Chakrabarty R, Zaman RU — Immunohematological and clinical characterizations of mixed autoimmune hemolytic anemia. Asian J Transfus Sci 2018; 12(2): 99-104. doi: 10.4103/ajts.AJTS_105_17
14Alwar V, Shanthala DA, Sitalakshmi S, Karuna RK — Clinical patterns and hematological spectrum in autoimmune hemolytic anemia. J Lab Physicians 2010; 2(1): 17-20. doi: 10.4103/ 0974-2727.66703.
15Naithani R, Agrawal N, Mahapatra M, Pati H, Kumar R, Choudhary VP — Autoimmune hemolytic anemia in India: clinico-hematological spectrum of 79 cases. Hematology 2006; 11(1): 73-6.
16Das SS, Nityanand S, Chaudhary R — Clinical and serological characterization of autoimmune hemolytic anemia in a tertiary care hospital in North India. Ann Hematol 2009; 88(8): 727-32.
17Berentsen S, Ulvestad E, Gjertsen BT, Hjorth-Hansen H, Langholm R, et al — Rituximab for primary chronic cold agglutinin disease: a prospective study of 37 courses of therapy in 27 patients. Blood 2004; 103(8): 2925-8. doi: 10.1182/blood2003-10-3597.
18Hantaweepant C, Pairattanakorn P, Karaketklang K, Owattanapanich W, Chinthammitr Y — Efficacy and safety of second-line treatment in Thai patients with primary warm-type autoimmune hemolytic anemia. Hematology 2019; 24(1): 720726. doi: 10.1080/16078454.2019.1671060.
19Fan J, He H, Zhao W, Wang Y, Lu J, Li J, et al — Clinical Features and Treatment Outcomes of Childhood Autoimmune Hemolytic Anemia: A Retrospective Analysis of 68 Cases. J Pediatr Hematol Oncol 2016; 38(2): e50-5. doi: 10.1097/ MPH.0000000000000476
If you want to send your queries and receive the response on any subject from JIMA, please use the E-mail or Mobile facility.
Website:https://onlinejima.com www.ejima.in
For Reception:Mobile : +919477493033
For Editorial :jima1930@rediffmail.com Mobile : +919477493027
For Circulation :jimacir@gmail.com Mobile : +919477493037
For Marketing :jimamkt@gmail.com Mobile : +919477493036
For Accounts:journalaccts@gmail.com Mobile : +919432211112
For Guideline:https://onlinejima.com
Aishwarya Babu1, Vaibhavi Patil2, Sunita M Bhatawadekar3, Prajakta Jadhav4
Background : Development of Carbapenem Resistance is on the rise in many countries including India. The risk factors for development of carbapenem resistance include poor living conditions, easy over the counter availability of antibiotics, over- or under dosage of antibiotics or presence of poor-quality drugs in the market. Though there are many mechanisms by which carbapenems develop resistance, resistance due to Metallo-beta-lactamase (MBL) is critical as being plasmid mediated, it can rapidly spread to the environment.
Aims and objectives : To determine the prevalence and antibiotic susceptibility pattern of Carbapenem Resistant Gram Negative Bacteria (CRGNB) with phenotypic detection of MBL
Materials and Methods : All the samples received in microbiology lab were processed by standard methods and Carbapenem Resistant Gram Negative Bacilli (CRGNB) were identified by automated system. Imipenem resistant isolates were subjected to detection of MBL by Combined Disk Synergy Test (CDST) & Epsilometer test (E test).
Results : The prevalence of CRGNB was found to be 21.4% in our study. Majority of the isolates were Klebsiella pneumoniae (41.7%) followed by E coli (23.3%) and Acinetobacter baumanni (15.9%). In 84% isolates were MBL producers by E test and 83% were MBL producers by CDST
Conclusion : To control the spread of MBL, active surveillance in the microbiology lab along with strict infection control practices and antibiotic stewardship program needs to be set up in each health care setting.
[J Indian Med Assoc 2024; 122(9): 40-3]
Key words : Carbapenem Resistance, CRGNB, Imipenem, MBL.
Antibiotic resistance has emerged as a global burden and a threat to the public health over the past few years. β-lactam antibiotics are the most common group of antimicrobials used for the treatment of majority of the Gram Negative Bacterial (GNB) infections1 Along with cephalosporins and penicillin, the carbapenems have become an important therapeutic option for Intensive Care Unit patients. They are used as a last resort against many multi drug resistant, Gram negative bacteria, especially in cases of infections due to Extended Spectrum Beta Lactamase (ESBL) and Amp C beta lactamase (AmpC) enzyme producing Enterobacteriaceae2 There has been an increase in the emergence of carbapenemases like metallo β lactamase (MBL) as a result of frequent use of carbapenems. MBL can hydrolyze a wide variety of β lactam agents, such as penicillins, cephalosporins, and carbapenems. MBLs are inhibited by thiol based compounds and metal chelators, such as an Ethylene Diamine Tetra Acetic Acid (EDTA)3,4
Department of Microbiology, Bharati Vidyapeeth (Deemed to be University) Medical College, Pune, Maharashtra Pune 411043
1MD (Microbiology), Assistant Professor and Corresponding
Author
2BSc (Microbiology), MSc Student, Department of Microbiology, Yashwantrao Mohite College of Arts, Science and Commerce, Pune, Maharashtra 411038
3MD (Microbiology), Professor
4BSc (Microbiology), MSc Student
Received on : 17/10/2023
Accepted on : 08/12/2023
Editor's Comment :
nn n Carbapenem resistant isolates are on a high in India. nn n Timely detection of carbapenem resistant isolates is crucial to initiate appropriate and targetted therapy nn nn n Strict antimicrobial stewardship practices also need to be implemented in every health care setting to reduce the incidence of carbapenem resistant Gram negative bacteria in our health care settings.
Many GNB, such as Acinetobacter species, Pseudomonas spp, some of the Enterobacteriaceae can easily produce MBL. MBLs can be transferred through plasmids and can cause outbreaks and nosocomial infections4 This can mainly affect the patients in Intensive Care Units (ICU’s) who have many co-morbidities or patients who are on prolonged antibiotics1 Therefore, identification and early detection of MBL is essential to provide prompt treatment to the patient which can help in reducing morbidity and mortality due to carbapenemase producing GNB.
MATERIALS AND METHODS
A total of 163 CR Gram Negative Bacilli were included in the study (Calculated from a former similar
No 09, September
study)3.All these isolates were subjected to antibiotic susceptibility testing as per Clinical & Laboratory Standards Institute (CLSI) guidelines using Vitek 2 automated system (BioMerieux, Marcy l’Etoile, France)5.Imipenem (IPM) resistant strains were taken as positive for Metallo-beta-lactamase enzyme (MBL) screening. The isolates which gave positive MBL screening test were confirmed by using two methods with inhibitor of MBL, Ethylene Diamine Tetra Acetic Acid (EDTA). By dissolving 18.61 g of EDTA(Hi Media Laboratories Pvt Ltd, India) in 100 ml of distilled water 0.5 M EDTA was prepared4
Combined Disk Synergy Test (CDST) with 0.5 M EDTA4 :
Two IPM (10 µg) disks (Hi Media Laboratories Pvt Ltd, India) were placed 30 mm apart from center to center on the surface of a Muller Hinton agar plate (MHA) (HiMedia Laboratories Pvt Ltd, India) and 10 µl 0.5 M EDTA solution was applied to one of the disks to obtain the required concentration of 750 µg. If zone of inhibition of IPM-EDTA disk was >7 mm more than that of IPM disk alone, it was considered as MBL positive4
E-test6 :
An E-test MBL strip (Hi Media Laboratories Pvt Ltd, India) contain a double-sided seven-dilution range of IPM (4-256 µg/ml) and IPM (1-64 µg/ml) in combination with EDTA. On MHA (Hi Media Laboratories Pvt Ltd, India), a lawn culture of 0.5 McFarland opacity standard of the test isolate was done after which the E-strip was placed. The plates were observed for IPM and IPM-EDTA Minimum Inhibitory Concentration (MIC) values after overnight incubation. If the MIC ratio of IPM/IPM plus EDTA was more than eight, the test was considered positive6
A total of 163 Carbapenem Resistant Gram
Negative Bacilli were processed during the study period. Age-wise distribution of the isolates are given inTable1.62%oftheisolateswereobtainedfrommale patients while only 32% were from female patients. 37% of the patients were admitted to the ICU’s (Table 2). 34% of the isolates were obtained from urine sample, 19% from pus, 17 % from blood and rest were isolated from respiratory sample like sputum, BronchoalveolarLavage(BAL)andEndotrachealTube Aspirate (ETT) (Fig 1). 41% of the isolates were Klebsiellapneumoniae,23%were Ecoli and16%were Acinetobacter baumanni (Table 3). A total of 136 isolates were MBL producers by Combined Disc
Table 1 — Age wise distribution of patients
Age group Number of (in years) patients 0-1 11 2-10 4 11-20
Table 2 — Location of the patients
Location of Number of the patients patients n (%)
Medicine 23 (14%)
Surgery 9 (5%)
Orthopedics 15 (9%)
Pediatrics 2 (1%)
ICU 43 (26%)
NICU & PICU 18 (11%)
ICU - Intensive Care Unit, NICU - Neonatal ICU, PICU - Paediatric ICU
Table 3 — Organism isolated Gram Negative Bacilli isolated Number of patients E coli 38
Klebsiella pneumoniae 68
Enterobacter cloacae 5
Enterobacter aerogenes 2
Proteus mirabilis 1
Pseudomonas aeruginosa 8
Acinetobacter baumanii 26 Burkholderia cepaciae 2
Elizabethkingia meningoseptica 1
Sphingobacterium spiritivorum 1
Chryseobacterium indologenes 2
Alcaligens faecalis 2
Synergy Test (CDST) while 138 isolates were MBL producers by E test (Fig 2). 96% of the isolates were susceptible to tigecycline, 84% were susceptible to fosfomycin and 92% to colistin (Fig 3).

Out of the 760 Gram Negative Bacilli obtained during the study period, 163 isolates were Carbapenem Resistant. The prevalence of Carbapenem Resistant Gram Negative Bacilli (CRGNB) in our hospital is 21.4%. The prevalence of CRGNB was 12% in a study by Nair PK, et al in western India (2013), 11% in a study by Ralte VSC, et al in eastern India (2022), 12% in study by Gladstone P, et al in southern India (2005) and 11% in a study by Garg A, et al in Northern India (2019)2,79 The high prevalence of CRGNB in our study could be due to the fact that majority of the patients were admitted in Intensive Care Units where they were already exposed to antibiotics possibly for more than 4 weeks. Also, most of these patients would require mechanical ventilation, urinary catheter or central line thus increasing the chance of getting infection with resistant bugs10. In 48% of the patients were above 40 years of age. Similar age distribution was seen in study by Abhishek S, et al6. Reason for risk of CRGNB above this age could be due to weaker immune system and presence of co-morbidities11. In study by Gao Y, et al chance of 60-day survival in patients above 55 years with bloodstream infection caused by CRGNB was 42% and chance of 60-day death was 63%12 . 105 patients were males (62%) and 58 were females. Males have higher prevalence of developing Gram negative bacterial infection.13 In a study by Gomila A, et al one of the predictors for development of infection caused by multidrug resistant bacteria was male gender14. Study by Satyajeet K Pawar, et al in Maharashtra also showed male predominance (65.3%) 15. Sample-wise distribution of the isolates showed that majority were obtained from urine (34%; 56/163) followed by pus, blood and respiratory specimens. Other predictors
for development of infection caused by multidrug resistant bacteria were the presence of Urinary Tract Infection and development of UTI during hospital stay in the study by Gomila A, et al14. 41% of the carbapenem resistant isolates were Klebsiella pneumoniae (68/163). Highest rate of Carbapenem Resistance (CR) is seen among Klebsiella pneumoniae as compared to other Enterobacteriaceae globally. In Italy, CR rate among Klebsiella pneumoniae is 33%, 62% in Greece,37% in Saudi Arabia and 11% in the United states13,16. In India, Klebsiella pneumoniae was the predominant CRGNB (44%) in various studies like the study by Porwal R, et al (44%), Abhishek S, et al (55%) and Satyajeet K Pawar, et al (63%)10,11,15. In the US, Klebsiella Pneumoniae Carbapenemase (KPC) is the most frequently produced carbapenemase by CR Enterobacteriaceae but in India, MBL is the most commonly produced Carbapenemase16. In 84% of the CRGNB in the present study were found to be MBL producers by E-test and 83% by CDST. In a similar study of detection of MBL by Panchal CA, et al 70% of the CRGNB were MBL producers4 CRGNB are usually resistant to all beta lactam antibiotics, beta lactam-beta lactamase inhibitors (except ceftazidime-avibactam) and Carbapenems. They are usually susceptible to tigecycline and polymyxins (colistin and polymyxin B)16-19 In the present study also all the isolates were 100% resistant to first, second and third generation of cephalosporins, piperacillin-tazobactam, cefoperazone-sulbactam, ertapenem, imipenem and meropenem. 96% (158/ 163)of the isolates were susceptible to tigecycline, 84% (136/163) were susceptible to fosfomycin and 92% (150/163) to colistin. Typically, NDM producers are resistant to all aminoglycosides16,20. 75% of the isolates were resistant to amikacin, 80% to gentamicin, 85% to cotrimoxazole and 97% to ciprofloxacin in our study
The first step in dealing with the problem of MBL is the identification of infected patients. Active surveillance for the most MBL needs to be done in the microbiology laboratory.To initiate appropriate and targeted therapy and to reduce the chance of development of antibiotic resistance, timely detection of MBL is crucial. This is because, MBL infected/ colonised patients can serve as a reservoir of infection thus contaminating the environment. To prevent this, such patients need to be contact isolated and vigilant infection control practices like hand hygiene, proper waste disposal should be maintained. Although
Vol 122, No 09, September 2024
Journal of the Indian Medical Association
molecular techniques are regarded as the gold standard for detection of MBL, in routine diagnostic laboratory, it becomes impractical due to its requirement of costly infrastructure and trained personnel. Rapid and effective phenotypic detection of MBL is therefore the need of the hour. From our study, CDST and E test was found to be almost equally efficient for detection of MBL. To control Carbapenem Resistance, strict antimicrobial stewardship practices also need to be implemented in every health care setting. Limiting the use of invasive procedures can also contribute towards prevention of Carbapenem Resistance in hospitals.
1 Bahrami S, Shafiee F, Hakamifard A, Fazeli H, Soltani R — Antimicrobial susceptibility pattern of carbapenemase-producing Gram-negative nosocomial bacteria at Al Zahra hospital, Isfahan, Iran. Iran J Microbiol 2021; 13(1): 50-7.
2 Nair PK — Prevalence of carbapenem resistant Enterobacteriaceae from a tertiary care hospital in Mumbai, India. Journal of Microbiology and Infectious Diseases 2013; 3(4): 207-10.
3 Vamsi S, Ramamoorthy KS, Murali TS, Vamsi A, Reddy BR, Hameliamma M — Prevalence of Carbapenem Resistant Gram Negative Bacteria in Rural Hospital Mahabubnagar, Telangana and Systemic Review Int J Curr Microbiol App Sci 2021; 10(03): 1542-7.
4 Panchal CA, Oza SS, Mehta SJ — Comparison of four phenotypic methods for detection of metallo-â-lactamase-producing Gram-negative bacteria in rural teaching hospital. J Lab Physicians 2017; 9: 81-3.
5 Clinical and Laboratory Standards Institute: performance standards for antimicrobial susceptibility testing; 29th Informational Supplement, CLSI M100-S29. Wayne PA, USA: Clinical and Laboratory Standards Institute 2023.
6 Sachdeva R, Sharma B, Sharma R — Evaluation of different phenotypic tests for detection of metallo-â-lactamases in imipenem-resistant Pseudomonas aeruginosa J Lab Physicians 2017; 9(4): 249-53.
7 Ralte VSC, Loganathan A, Manohar P, Sailo CV, Sanga Z, Ralte L, et al — The emergence of carbapenem-resistant Gram-negative bacteria in Mizoram, northeast India. Microbiol Res 2022; 13(3): 342-9.
8 Gladstone P, Rajendran P, Brahmadathan KN — Incidence of carbapenem resistant nonfermenting gram negative bacilli from patients with respiratory infections in the intensive care units. Indian J Med Microbiol 2005; 23(3): 189-91.
9 Garg A, Garg J, Kumar S, Bhattacharya A, Agarwal S, Upadhyay GC — Molecular epidemiology & therapeutic options of carbapenem-resistant Gram-negative bacteria. Indian J Med Res 2019; 149(2): 285-9.
10 Porwal R, Gopalakrishnan R, Rajesh NJ, Ramasubramanian V — Carbapenem resistant Gram-negative bacteremia in an Indian intensive care unit: A review of the clinical profile and treatment outcome of 50 patients. Indian J Crit Care Med 2014; 18(11): 750-3.
11 Abhishek S, Naik SS, Leela KV, Maheswary D — Genotypic distribution and antimicrobial susceptibilities of carbapenemase-producing Enterobacteriaceae isolated in tertiary care hospital in south India. J Pure Appl Microbiol 2022; 16(4): 2488-95.
12 Gao Y, Lin H, Xu Y, Yao Y, Shi D, Li J, et al — Prognostic Risk Factors of Carbapenem-Resistant Gram-Negative Bacteria Bloodstream Infection in Immunosuppressed Patients: A 7Year Retrospective Cohort Study Infect Drug Resist 2022; 15: 6451-62.
13 Aloraifi RI, Alharthi AF, Almefleh AA, Alamri AH, Alobud AS, Bawazeer RA, et al — Prevalence of Carbapenem Non-susceptible Gram-Negative Bacteria at Tertiary Care Hospitals in Saudi Arabia. Cureus 2023; 15(1): e33767.
14 Gomila A, Shaw E, Carratalà J, Leibovici L, Tebé C, Wiegand I, et al — Combacte-magnet WP5- Rescuing Study. Predictive factors for multidrug-resistant gram-negative bacteria among hospitalised patients with complicated urinary tract infections. Antimicrob Resist Infect Control 2018; 7: 111. doi: 10.1186/s13756-018-0401-6.
15 Satyajeet K Pawar — Carbapenem resistant Enterobacteriaceae:Prevalence and bacteriological profile in a tertiary teaching hospital from rural western India. Indian J Microbiol Res 2018; 5(3): 342-7.
16 Iovleva A, Doi Y — Carbapenem-Resistant Enterobacteriaceae Clin Lab Med 2017; 37(2): 303-15. doi: 10.1016/ j.cll.2017.01.005.
17 Zeng M, Xia J, Zong Z, Shi Y, Ni Y, Hu F, et al — Guidelines for the diagnosis, treatment, prevention and control of infections caused by carbapenem-resistant gram-negative bacilli. J Microbiol Immunol Infect 2023; 56(4): 653-671. doi: 10.1016/ j.jmii.2023.01.017.
18 Paul M, Carrara E, Retamar P, Tängdén T, Bitterman R, Bonomo RA, et al — European Society of Clinical Microbiology and Infectious Diseases (ESCMID) guidelines for the treatment of infections caused by multidrug-resistant Gram-negative bacilli. Clin Microbiol Infect 2022; 28(4): 521-47. doi: 10.1016/j.cmi.2021.11.025.
19 Sy CL, Chen PY, Cheng CW, Huang LJ, Wang CH, Chang TH, et al — Recommendations and guidelines for the treatment of infections due to multidrug resistant organisms. J Microbiol Immunol Infect 2022; 55(3): 359-86. doi: 10.1016/ j.jmii.2022.02.001.
20 Yang W, Hu F — Research Updates of Plasmid-Mediated Aminoglycoside Resistance 16S rRNA Methyltransferase. Antibiotics 2022; 11(7): 906.doi:10.3390/antibiotics11070906.
Ananya Biswas1, Anwesa Pal2, Arnab Bhar3
Background : Occipital bone is unique in respect to its relation with brainstem as it rests on clivus and passthrough Foramen Magnum to continue as spinal cord. Any pathological lesion in anterior or antero-lateral location of brainstem approached surgically through transcondylar plane. Most common obstructions in this process are Occipital Condyle (OC) and Jugular Tubercle (JT). Familiarity with the anatomical configurations of these structures is important for a safe and uncomplicated outcome of the surgeries.
Aims and Objective : Measurement of length, width and height of Jugular Tubercle (JT) of dry human occipital bone and to find out presence of bilateral dimorphism if any in West Bengal population.
Materials and Methods : In the present study authors measured different parameters in 150 available dry human occipital bones; preserved in Anatomy departments of different Medical Colleges of Kolkata over last one year. Measurement of length, width and height were taken by slide callipers and analysed.
Result : In the present study mean values of the parameters of JT were: length 13.79±2.0mm (right) and 13.85±1.7mm (left), width 10.15±1.4mm (right) and 10.15±1.6mm (left), height 7.57±1.8mm (right) and 8.32±1.9mm (left). In present study only height shown statistically significant difference between right and left side.
Conclusion : Measurement of different parameters of JT of occipital bone can be useful for neurosurgeons during pre and intraoperative transcondylar surgical intervention. In addition, it would contribute to anthropometric data available for JT in different population.
[J Indian Med Assoc 2024; 122(9): 44-7]
Key words :Jugular Tubercle, Transcondylar Approach, Occipital Condyle, Hypoglossal Canal.
Intra or extra dural any brainstem lesion is a medical emergency and need definite medical attention and intervention when necessary. Surgical exposure of the brainstem is a challenging step for neurosurgeons as Foramen Magnum (FM) is guarded by thick bony prominences and closely related to important neurovascular structures pass through it. Different surgical approaches like lateral transcondylar and its modifications, supracondylar approach, Endoscopic Endonasal Transclival Approach and Extreme Lateral Infrajugular Transcondylar Transtubercular Exposure (ELITE) are being introduced for last few years. These approaches are effective in decreasing the depth of the surgical field and improving visualization by resection of the Occipital Condyle (OC), Jugular Tubercle (JT) and preferably articular facets of the C1 and C21-6. In ELITE, drilling the Jugular Tubercle (JT) can maximise the extent of exposure and removal of JT is critical for optimising access to the inferior and midclival areas, Vertebro-basilar Artery Junction, ventral aspect of pons and medulla 7
Department of Anatomy, IPGME&R and SSKM Hospital, Kolkata, West Bengal 700020
1MD, Associate Professor
2MD, Assistant Professor and Corresponding Author
3MD, Associate Professor, Department of Anatomy, R G Kar
Medical College And Hospital, Kolkata 700004
Received on : 14/09/2023
Accepted on : 16/09/2023
Editor's Comment :
By drilling or removing of Jugular Tubercle (JT), Extreme Lateral Infrajugular Transcondylar Transtubercular Exposure (ELITE) can maximise the exposure of lesions of the brainstem region or nearby neuro-vascular structures like vertebra-basilar arterial junction during surgery. Hence, knowledge of morphometric variations of JT can decrease morbidity of patients after surgery.
This study measured bilateral height, width and length of JT among the West Bengal population and found a statistically significant difference between height of right and left side. The data obtained may be useful to the neurosurgeons as well as for the anthropologists, morphologists and clinical anatomists.
Modified endo scopic transclival approach allows direct access to ventrolateral lesions in the infraclival or petroclival region without brain or cranial nerve retraction. Supracondylar approach is a new addition in this field which is minimally invasive extradural approach to the Hypoglossal Canal (HC) with low risk of morbidity, where the Occipital Condyle (OC) and the lateral osseous circumference of the Foramen Magnum are preserved and drilled extradurally and dorsal parts of the JT are removed. Angle of visualization of ventral aspect of brainstem and it surrounding improved by far-lateral approach. Principal obstacle in the far-lateral approach is Jugular Tubercle, especially when pathology is located in vertebra or in Vertebro-basilar Junction (VBJ)8-12
122, No 09, September 2024Journal
Additional 2-4mm increase in the operative field from the Foramen Magnum toward the clivus is possible by removal of JT13
Hence, detailed regional anatomical orientation and knowledge of variations of the JT increase safety and reduces rate of morbidity by allowing adequate neurovascular decompression during the surgical approaches.
The purpose of this study is to measure the dimensions of JT, describe its structural variations and pursue a morphometrical analysis of the collected data.
An observational descriptive morphometric study was performed on 150 dry healthy adult occipital bones collected from the department of Anatomy of different Medical Colleges in Kolkata after getting Institutional Ethical Committee clearance letter. Malformed, unossified or broken bones were excluded. The length, width and height of JT were measured bilaterally with Vernier slide callipers (with the minimum division on the vernier scale measuring 0.02mm. The zero mark on the vernier scale coincided with the zero mark on the main scale, so no correction factor has been used for the vernier scale). Each measurement was taken thrice and the mean value of the three was taken to avoid observer bias. Data was summarized by routine descriptive statistics. Data of various morphometric parameters were expressed with the mean, Standard Deviation, 25th, 75th, 10th, 90 th, 5th and 95th percentile value. Key variables were expressed with the 95% confidence intervals. Bilaterality was compared by t-test or Mc Nemar’s Chi-square test with the help of Statistica version 6 (Tulsa, Oklahoma: StatSoft Inc, 2001) and MedCalc version 11.6 (Mariakerke, Belgium: MedCalc Software 2011). All variables are normally distributed by KolmogorovSmirnoff goodness of fit test (Figs 1-3).
Range, mean ±SD and 95% confidence interval is given in Table 1. Bilateral difference in length and width of JT were found statistically insignificant, whereas show highly significant bilateral variation (paired sample t-test, P<0.0001) in height. Table 2 shows percentile value of JT.
DISCUSSION
Lateral transcondylar
approach is a complicated skull base approach used to access anterior and anterolateral region of brainstem, FM and associated joints. Though different terminologies used for different approaches, but main aim is early exposure of vertebral artery, lateral craniotomy and resection of OC and JT. Extent of resection of the bony parts depends on location of pathology and structural variation in bony prominences in and around FM region5.
Dowd, et al14, Spektor, et al15 and Goel A, et al16 reported increase in visual angle for the petroclival region by resection of OC in their research studies. Wu A, et al in 201017 mentioned about JT Angle (JTA). The angle was measured in a cadaveric study of condylar fossa exposure and 3D CT study. They concluded that if JT and OC were not prominent (JTA>180o) greater petroclival or brainstem exposure was found by condylar fossa approach than transcondylar approach17. It has also established in various studies that both extra and intradural resection of JT can be performed for management of lesions of the brainstem to gain a wider exposure for which the dimensions of JT will help neurosurgeons a lot18-20
In the present study length, width and height of JT were measured. Specific bony landmarks for measurement would be helpful to get a reliable assessment by different researchers. In 2006, evaluation of individual structural variations of JT in 100 split occipital bones was done by Mintelis, et al Authors measured the length of JT between the posterior condylar canal and basilar part of the clivus7 However, reliability of these landmarks was questionable as condylar canal was not a constant feature of occipital bone. Muthukumar, et al 21
Table 1 — Measurement of Jugular Tubercle (JT) – Whole cohort [n = 150] and bilateral comparison by paired sample t-test
ParametersSideRange Mean ± SD95% ConfidenceP value (Minimum -Intervalbetween maximum) (lower limit –group upper limit) comparisons
LengthRight9.90 - 18.52 13.79 ± 1.96013.47 - 14.110.7009
Left8.18 - 17.1213.85 ± 1.77613.56 - 14.13
WidthRight6.38 - 13.80 10.15 ±1.4359.92 - 10.380.9688
Left5.60 - 15.0010.15 ± 1.5699.90 - 10.40
HeightRight4.00 - 11.607.57 ± 1.796 7.28 - 7.86<0.0001
Left4.20 - 12.208.32 ± 1.8678.02 - 8.62
2 — Percentile values of Jugular Tubercle (JT) ParameterSide5th


demonstrated that presence of condylar canal was only in 60% in their study specimens. Wu A, et al also reported absence of posterior condylar foramen in 27% of specimen unilaterally and in 17% bilaterally in their research work in 2010. So, instead of taking this as a reference point they took measurement of the JT length between the anterior and posterior regions where the prominence of tubercle flattens17 In the present study we followed author Wu A, et al17 at the time of measurement of the same.
The thickness or height was measured according to the points of the imaginary lines drawn perpendicular to the width and the length by Avcl E, et al5. Mintelis and his colleagues7 measured the JT width as the maximum distance between the anterior border of the hypo-glossal canal and the anterior infrajugular point. Above mentioned same procedures were followed in present study for the measurements of mentioned parameters.
Avci E, et al5 in 2011 observed on thirty dry skulls (dried specimens, 60 sides) and ten formalin-fixed cadaveric heads with perfused vessels, were carried out to define the microsurgical anatomy of the FM region. Morphometric analysis and variations of the FM, OC, JT and Hypoglossal Canal (HC) were noted. Radiological assessment (3D-computed tomography) of the OC, JT, HC were also conducted on dry skulls. The short and long OC were demonstrated in 5% and 33% of the specimens, respectively. Flat formation of the JT was determined in 10% and tall JT was found in 23% of the specimens. The comparison of the anatomical measurements and the correspondent radiological mean values did not achieve statistical significance. The OC and JT are the main bony prominences obstructing the anterolateral surface of the brainstem. Neurosurgeons should be familiar with

variations of the structures surrounding the FM in order to perform the safest and widest exposure possible5
Result of the Study by Mintelis, et al7 showed mean length of the JT was 1.65 ± 0.36 cm (range 1.2–3 cm); its mean width was 1.15 ± 0.16 cm (range 0.7–1.7 cm); and its mean thickness was 0.61 ± 0.15 cm (range 0.2–1 cm). The authors analysed the difference in morphometric data with regard to right and left sides and found no statistically significant difference between the two sides. Furthermore, data from the morphometric study were compared with the results of 20 measurements obtained from threedimensional computed tomography (3D CT) scans. Accordingly, the mean length of the JT was 1.35 ± 0.15 cm (range 1–2.8 cm); the mean width, 1.10 ± 0.12 cm (range 0.8–1.3 cm); and the mean thickness, 0.51 ± 0.18 cm (range 0.2–1 cm). they concluded that morphometric data on the JT contribute significantly to the neurosurgeon’s task of skull base drilling. The 3D CT scans were useful in the preoperative planning7.
Table 3 shows that mean values are different in each study for JT. length of JT is higher in study by Mintelis A, et al7 than other studies but width and height were showing lower value in comparison to others. The above table shows that mean height of JT of right side of present study is close to that of done by Avci E, et al5. But, in their study bilateral difference was non-significant whereas, in present study the mean of left side is much higher (8.32mm with SD 1.867) than that of the right side (7.57mm with SD 1.796). and was found statistically significant difference in height (P<0.0001).
Parameters Mintelis A,Avci E, et al (2011)p-valuePresent study (2022)p-value (mm) et al (2006)RightLeft RightLeft
122, No 09, September 2024Journal
Different surgical approaches are being increasingly used to access lesions ventral to the brainstem and cervico-medullary junction. Majority of these approaches demand resection of the JT partially or completely. The dimensions and orientation of the JT may influence the surgical approach in the lesions of craniovertebral junction. So, a sound knowledge and understanding of the bony anatomy and variations of this region is important for these approaches. The purpose of the present study was to conduct a morphometric analysis of the JT. Present study found statistically significant difference between right and left side in height of JT (P<0.0001).
Different investigators reported variable morphometry of JT. These variations may be due to different sample and methods of data assimilation and also genetic endowment of different populations. The data obtained may be of useful to the neurosurgeons. The data can give us idea about the amount of bone that can safely be removed without disturbing the hypoglossal canal and giving a wide exposure on different approaches. The findings are also enlightening for the anthropologists, morphologists and clinical anatomists.
The major limitation of this study is the lack of knowledge regarding the age and gender of the bony specimens. So, gender dimorphism could not be elicited if any. Present study was based on dry bone specimen with limited sample size. In future there is a scope for extension of this study with larger sample size and comparison of the data with cadaveric specimen as well as radiological specimens to get more precise and complete result.
We would like to express our special thanks of gratitude to our respected Director, members of Ethical committee for their permission and concerned Head(s) of the Department(s) and faculty members of Anatomy of different government medical colleges of Kolkata for their guidance to access the bones preserved in the departmental museums. The authors with full heart do pay homage to the departed souls who have donated their mortal bodies in Anatomy departments for study & research works.
1Routal RR, Pal GP, Bhagwat SS, Tamankar BP— Material studies with sexual dimorphism in foramen magnum of human crania. J Anat Soc India 1984; 33(2): 85-9.
2Paraskevas GK, Tsitsopoulos PP, Papaziogas B, Kitsoulis P, Spanidou S, Tsitsopoulos P — Osseous variations of the hypoglossal canal area. Med Sci Monit 2009; 15(3): 75-83.
47
3Tubbs RS, Christoph J, Griessenauer, Marios L, Mohammadali MS, Aaron ACG: Morphometric analysis of the foramen magnum: An anatomic study. Neurosurgery 2010; 66(2): 385-8.
4Rehman PG, Yadav R, Deshpande G — Morphometry analysis of the foramen magnum dimensions and its relation to gender. Journal of Forensic Medicine and Toxicology 2011; 28(1): 62-4.
5AvcI E, DagtekIn A, Ozturk AH, Kara E, Ozturk NC, Uluc K, et al — Anatomical Variations of the Foramen Magnum, Occipital Condyle and Jugular Tubercle. Turkish Neurosurgery 2011; 21(2): 181-90.
6Zaidi SHH, Gupta R, Usman N — A study of hypoglossal canal in North Indian crania. Journal of Anatomical Society of India 2011; 60(2): 224-6.
7Mintelis A, Sameshima T, Bulsara KR, Gray L, Friedman AH, Fukushima T — Jugular tubercle: Morphometric analysis and surgical significance. J Neurosurg 2006; 105: 753-7.
8Xiong Jian, Chen Gaung — Morphometric analysis and microsurgical anatomy for lateral transcondylar approach. Journal of US-Chaina Medical Science 2008; 5(1): 27-33
9Singh KB — A material study of Chinese crania. J Anat soc India 1963; 12-6.
10Chet han P, Prakash KG, Murlýmanju BV, Prashanth KU, Prabhu LV, Saralaya VV, et al — Morphological Analysis and Morphometry of the Foramen Magnum: An Anatomical Investigation. Turkish Neurosurgery 2012; 22(4): 416-41.
11Osunwoke EA, Oladipo GS, Gwunireama IU, Ngaokere JO — Morphometric analysis of the foramen magnum and jugular foramen in adult skulls in southern Nigerian population. Am J Sci Ind Res 2012; 3(6): 446-8.
12Pereira GAM, Lopes PTC, Santos AMPV, Duarte RD, Piva L, Pozzobon A — Morphometric Analysis Related to the Transcondylar Approach in Dry Skulls and Computed Tomography. Int J Morphol 2012; 30(2): 399-404.
13Radhakrishna SK, Shivarama CH, Ramakrishna A, Bhagy B — Morphometric analysis of foramen magnum for sex determination in south indian population. NUJHS 2012; 2(1): 20-2.
14Dowd GC, Zeiller S, Awasthi D — Far lateral transcondylar approach: Dimensional anatomy. Neurosurgery 1999; 45: 95100.
15Goel A, Desai K, Muzumdar D — Surgery on anterior foramen magnum meningiomas using a conventional posterior suboccipital approach: A report on an experience with 17 cases. Neurosurgery 2001; 49: 102-6.
16Spektor S, Anderson GJ, McMenomey SO, Horgan MA, Kellog JX, Delashaw JB Jr — Quantitative description of the far-lateral transcondylar transtubercular approach to the foramen magnum and clivus. J Neurosurg 2000; 92: 824-31.
17Wu A, Zabramski JM, Jittapiromsak P, Wallace RC, Spetzler RF, Preul MC — Quantitative analysis of variants of the farlateral approach: condylar fossa and transcondylar exposures. Neurosurgery 2010; 66(6): 191-8.
18Salas E, Sekhar CN, Ziyal I, Caputy AJ and Wright DC — Variations of the extreme lateral craniocervical approach: Anatomical study and clinical analysis of 69 patients. J Neurosurg (spine 2) 1999; 90: 206-9.
19Day JD — Intradural jugular tubercle reduction to enhance exposure via the transcondylar approach: Technical note. Neurosurgery 2004; 55: 247-50.
20Mori K, Nakao Y, Yamamoto T, Maeda M — Intradural jugular tuberclectomy in a case of inadequate extradural removal. Surg Neurol 2005; 64: 347-50.
21Muthukumar N, Swaminathan R, Venkatesh G, Bhanumathy SP — A morphometric analysis of the foramen magnum region as it relates to the transcondylar approach. Acta Neurochir (Wien) 2005; 147: 889-95.
Nebedita Dutta1, Debasis Sarkar2, Pradip Kumar Sinha3
Background : In patients with Chronic Kidney Disease (CKD), cardiovascular physiological alteration occurs a lot and it becomes the most common cause of death in these patients.
Aims and Objective : to study the prevalence, correlation and association of Left Ventricular Diastolic Dysfunction (LVDD), Systolic Dysfunction (LVSD) and Left Ventricular Hypertrophy (LVH) with Left Ventricular Mass Index (LVMI) in relation to different stages of CKD patients.
Materials and Methods : it was a cross-sectional observational study involving 60 patients of established CKD patients after consideration of inclusion and exclusion criteria; tools used were estimated Glomerular Filtration Rate (eGFR) calculation for the staging of CKD and 2D echocardiography for grading and calculation of diastolic dysfunction, systolic dysfunction and LVMI. The data were analyzed by standard statistical methods.
Results : Most patients (41.6%) had grade II diastolic dysfunction seen mainly in stage IV patients and grade III dysfunction occurred in 66.7% of stage V patients. There was a significant association between systolic dysfunction and advanced stages of CKD. LVMI showed a progressive increase from stage I disease to stage V disease.
Conclusion : With advanced stages of CKD, there was a statistically significant increase in LVDD, LVMI and a statistical decrease in systolic function.
[J Indian Med Assoc 2024; 122(9): 48-53]
Key words :Chronic Kidney Disease, Left Ventricular Diastolic Dysfunction, Left Ventricular Systolic Dysfunction, Left Ventricular Mass Index, Estimated Glomerular Filtration Rate.
Chronic Kidney Disease (CKD) is an important and common non-communicable condition globally. The prevalence of CKD among the Asian population is approximately 17% 1 . In patients with CKD, cardiovascular disease is the most common cause of death. Patients with eGFR below 60 ml/min/1.73m2 are much more likely to die from Cardiovascular (CV) complications than to develop End Stage Renal Disease (ESRD).
Diminished estimated Glomerular Filtration Rate (eGFR) and albuminuria are powerful, graded, independent predictors of cardiovascular mortality, morbidity and all-cause mortality2. Patients with CKD have a high burden of conventional risk factors that lead to accelerated atherosclerosis, LV dilatation with hypertrophy, systolic dysfunction and high LV filling pressure along with numerous CVD risk factors specific to CKD.
One of the most common cardiac structural abnormalities in CKD patients is Left Ventricular Hypertrophy2. LV dysfunction particularly diastolic
Department of General Medicine, Medical College, Kolkata 700073
1MBBS, MD (Medicine), Senior Resident
2MBBS, MD (Medicine), Associate Professor and Corresponding
Author
3MBBS, MD (Medicine), DM (Cardiology), Professor
Received on : 12/04/2024
Accepted on : 14/04/2024
Editor's Comment :
Chronic Kiney Diseases impose increased cardio-vascular morbidity and mortality. So, patients of Chronic Kidney Disease should be regularly screened for associated cardiovascular disease. Prompt intervention can be taken up if cardio-vascular abnormality is detected early.
dysfunction initiates cardiovascular disease in CKD patients3. It is impaired LV relaxation and increased LV stiffness and can be associated with normal or abnormal systolic function. LV Systolic Dysfunction is most identified by a subnormal LV Ejection Fraction (LVEF). Furthermore, in hemodialysis patients and those with later stages of Chronic Kidney Disease, Coronary Artery Obstruction, reduced Coronary Reserve and LV functional and structural abnormality secondary to volume and pressure overload leads to the development of cardiomyopathy4. In later stages, left ventricular adaptation leads to decreased capillary density, LV dilatation, more severe diastolic dysfunction, conduction defects and eccentric hypertrophy. All of these predispose to sudden cardiac death in these patients5.
Early detection of cardiac functional and structural abnormality with a proper intervention directed at the pathophysiological mechanism can delay the decline in cardiac function and decrease morbidity and
122, No 09, September 2024Journal
mortality. Our purpose of the study was to determine the prevalence of LV Systolic and Diastolic Dysfunction in different stages of CKD and to evaluate the correlation and association of various echocardiography parameters (E/A, E/e’, LA diameter, LVEF, fractional shortening, LVMI) of LV function with the stages.
(1) To study the prevalence of Left Ventricular Diastolic Dysfunction, Left Ventricular Systolic Dysfunction and Left Ventricular Hypertrophy in different stages of Chronic Kidney Disease patients.
(2) To study the correlation and association of Diastolic Dysfunction and Systolic Dysfunction, Left Ventricular Mass Index with different stages of chronic kidney disease.
(A) Study Type : Cross-sectional observational study.
(B) Sample Size : 60 patients with CKD were enrolled.
(C) Sample Size Calculation : According to a study done by Shady Elhusseiny, et al in India showed that the correlation coefficient of E/E’ with estimated GFR was 0.426. Now considering 95% confidence interval and 95% precision; sample size was calculated using the equation7 :
Total sample size =N=[(Zα + Zβ)/C]2 + 3. Here, the standard normal deviate for α = Zα =1.9600. The standard normal deviate for β = Zβ = 1.2816. C= 0.5
* ln[(1+r)/(1-r)] = 0.4477. So, total sample size = N=[(1.96 + 1.2816)/0.4477] 2 + 3 = 55. Minimum sample size needed = 55. We took 60 patients.
(D) Sampling Technique : Simple random sampling.
(E) Inclusion Criteria : All patients attending Medical College and Hospital OPD and admitted in the General Medicine Ward who are diagnosed as cases of Chronic Kidney Disease as per KDIGO guidelines.
(F) Exclusion criteria : Pre-existing cardiac disease like Rheumatic Heart Disease, Ischemic Heart Disease, Congenital Heart Disease, Myocarditis Due to Infective Etiology, Primary Heart Muscle Disease like Cardiomyopathies, patients with Acute Kidney Injury, pregnant or lactating women, patients who are unable to give informed consent
(G) Procedure : All CKD patients who have given consent for participation in this study have been evaluated with laboratory examinations and echocardiography. After filling of the proforma and
consent, blood tests were done to detect renal function such as serum Urea and Creatinine and other co-morbidities like diabetes mellitus and anemia. During check-up, vitals were measured including blood pressure. Then echocardiography was done and parameters that were previously determined were noted. During the same time, other cardiovascular causes were ruled out.
We have used the Modification of Diet in Renal Disease (MDRD) Equation for calculating the estimated Glomerular Filtration Rate (eGFR) and classified them according to KDIGO guidelines 2012 which denotes G1>90 ml/min/1.73m2, G2=60-90, G3=30-60, G4=15-30 and G5<15 ml/mi/1.73m2
We have used a 2D Echocardiography machine GE LOGIQ 400 PRO with a 3.5 MHz transducer probe. Two-dimensional echocardiography and M mode recording perpendicularly to the long axis of and through the center of the left ventricle at the papillary muscle level were taken as standard measurements of systolic and diastolic wall thickness and chamber dimensions. For measurement of left ventricular systolic function Left Ventricular Ejection Fraction (LVEF), regional wall motion abnormality and fractional shortening were taken. For measurement of left ventricular diastolic function E (early mitral inflow velocity), A (m/sec): late mitral inflow velocity, E/A ratio, E’s (m/sec): early diastolic relaxation velocity, E/E’ ratio and LA size was taken. Left Ventricular Mass Index was calculated by the Devereux formula: LVMI=[ 0.8{1.04[([LVIDD + IVSD +LVPWD]3-LVIDD3)]+0.6]/body surface area8
Among all 60 patients, 31.7% patients were <40 years of age and 18.3% were >60 years of age. The mean (SD) age was 48.2(12.4) years. 39(65%) patients were male and 21(35%) were female patients. Among all study participants, majority (61.7%) had multiple co-morbidities. Hypertension was the most common co-morbidity (88.3%) followed by diabetes (60%). The mean (SD) SBP and DBP were 138.7(19.4) mm Hg and 84.5(11.3) mm Hg.
Table 1 depicts that Diastolic Dysfunction was present in 83.3% patients. Majority (41.6%) of the patients had grade II Diastolic Dysfunction; among this group, it was highest in stage IV CKD patients. Grade III diastolic dysfunction was present in 20% of total patients and it was highest (66.7%) among stage V CKD patients. There was significant association (P value<0.001) and spearman Rho correlation was 0.693; significant positive correlation was noted.
As shown in Table 2, 76.7% patients have normal
Table 1 — CKD stages and LV Diastolic Dysfunction
Normal4 (80) 3 (33.4)1(7.6)1 (6.2)1 (5.9)10 (16.7)
Grade I1 (20)4 (44.4)6(46.4) 1(6.2)1 (5.9)13 (21.7)55.2,
Grade II0 (0)2 (22.2)5 (38.4)11(68.8)7 (41.1)25 (41.6)12, <0.001
Grade III0 (0)0 (0)1(7.6)3(18.8)8(47.1)12 (20)
Total5 (100)9 (100)13 (100)16 (100)17 (100)60 (100)
¥ Spearman Rho Correlation Coefficient (P value) = 0.693 (<0.001)
LVEF (systolic function); 16.7% patients had mildly abnormal Systolic function. There was significant association and moderate but significant correlation between Systolic Dysfunction and advanced stages of CKD.
Table 3 shows the mean along with standard deviation for E/A, E/E’, LA diameter, LVMI, %FS, EF in different stages of Chronic Kidney Disease. The mean E/E’ increased from 5.96(SD0.51) in CKD stage 1 to 13.67(SD 1.78) in CKD stage 5; the mean E/A decreased from 1.08 (SD 0.17) in CKD stage 1 to 0.83 (SD 0.25) in CKD stage 2 and then increased to 1.73(SD 0.52) in CKD stage 5. LA diameter progressively increased with a mean 33.94(SD 3.8) to 53.98(SD 6.88) in CKD stage 5. LVMI shows similar progression with 99.4(SD 6.37) in CKD stage 1 to 146.87(SD 18.95) in CKD stage 5.FS (%) and EF(%) shows a similar decrement with advanced stages; mean values are 43.08(SD 1.08) in stage 1 to 22.29(SD 6.53) in stage 5 and 64.6(SD 1.62) in CKD stage 1 to 45.56(SD 9.31) in CKD stage 5 for FS(%) and EF(%) respectively. Concentric LVH was more
prevalent (75%) in stage 2 and eccentric LVH was more seen in end stages (87.4%).
DISCUSSION
Our study was a hospital-based cross-sectional study conducted in patients attending Nephrology and General medicine OPD and IPD, Medical College, Kolkata.
Left Ventricular Systolic Function (LVSF) was measured using Left Ventricular Ejection Fraction (LVEF), Fractional Shortening (FS) and regional wall motion abnormality (RWMA). Of all the patients, 76.7% patients have normal LVEF(systolic function). Among patients with severely abnormal LVSF, one patient belonged to stage IV and another patient was in stage V. 88.3% of stage IV patients had normal LVSF. 50% of stage V patients had mildly abnormal LVSF followed by normal LVSF in 31.3% in the same group. There was a significant association and moderate but significant correlation between gradually increasing systolic dysfunction and progressing stages of CKD. The study by Szu-Chia Chen, et al
Table 2 — CKD stages and LV Systolic Dysfunction LVEF %Stages of CKDChi Squared, (Systolic Dysfunction)G1 No (%)G2 No (%)G3 No (%)G4 No (%)G5 No (%)Total No (%)df, P Value
Normal5 (100)8 (100)13 (100)15 (83.3)5 (31.3)46 (76.7)
Mildly abnormal0 (0)0 (0)0 (0) 2 (11.1)8 (50)10 (16.7)28.63, Moderately abnormal0 (0)0 (0)0 (0)0 (0)2 (12.1)2 (3.3)12, 0.004
Severely abnormal0 (0)0 (0)0 (0)1 (5.6)1 (6.3)2 (3.3)
Total5 (100)8 (100)13 (100)18 (100)16 (100)60 (100) ¥ Spearman Rho Correlation Coefficient (P value) = 0.596 (<0.001)
Table 3 — Echo measures of LV Systolic and Diastolic Dysfunction in different stages of CKD Chronic Kidney Disease
Stage
E/E’5.96(0.51) 7.34(0.59)10.58(1.58)13.30(1.21)13.67(1.78)0.841 P<0.001
LA Diameter33.94(3.8)33.94(3.09)43.88(3.16)50.05(5.07)53.98(6.88)0.549 P<0.001 LVMI99.4(6.37)112(10.42)120.46(11.88)132.72(19.70)146.87(18.95)0.369 P<0.001
Fractional Shortening43.08(1.08)39(1.44)33.41(2.17)29.44(5.25)22.29(6.53)-0.691 P<0.001 LVEF% 64.6(1.62)64(1.41)62.76(5.63)55.33(0.66)45.56(9.31) 0.596 P<0.001
Concentric LVH1(20%)6(75%)9(69.2%)9(50%)1(6.3%)
Eccentric LVH0(0%)0(0%)0(0%)6(33.3%)14(87.4%)
122, No 09, September 2024Journal
reported a significant trend of stepwise decrease in LVEF with the advancement of CKD stages9. A study was done by Farah Anum Jameel, et al showed left ventricular systolic dysfunction was present in 31% of end-stage renal disease patients10. A similar study done by Mukesh Laddha, et al reported reduced ejection fraction among 24.3% of patients with endstage renal disease11. The study done by Chelliah Dharmaraj, et al also showed systolic dysfunction among 34% of CKD patients12. In our study, 28.3% patients had below normal fractional shortening. A majority(77%) of patients with below normal fractional shortening belonged to stage V CKD. Significant association was noted between stages of CKD and fractional shortening. Spearman Rho correlation coefficient value was -0.691 that is, significant negative correlation was present. The study done by Rathod Nitin R, et al reported 29% patients with mild/ moderate CKD (eGFR>30ml/min/1.73m2) and 21.7% of severe CKD (eGFR<30 ml/min/1.73m 2 ) had impaired (<25%) fractional shortening13. We found no regional wall motion abnormality in 70% patients. Mild global hypokinesia was present in 18.3% patients and most of them were in stage V CKD. Severe global hypokinesia was present in 11.7% patients and 72% of them were in stage V CKD. Significant association (P value <0.001) was noted between stages of CKD and RWMA and there was moderate and positive correlation (P value 0.574). The study by ReetuGupta et al studied 100 CKD patients and the study reported: 17.1% of stage 2 CKD cases had preserved ejection fraction and 64.3% of stage 2 CKD cases were having reduced ejection function14. 35.7% of stage 3 CKD cases had preserved ejection fraction and 64.7% of stage 3 CKD cases were having reduced ejection function 35.3% of stage 4 CKD cases had preserved ejection fraction and 64.7% of stage 4 CKD cases were having reduced ejection function. 22.6% of stage 5 CKD cases had preserved ejection fraction and 77.4% of stage 5 CKD cases were having reduced ejection function. The prevalence of systolic dysfunction as indicated by reduced ejection fraction was increasing with CKD stages which was similar to our study. In this study, the mean Left Ventricular Mass Index (LVMI) was 127.7 gm/m 2 with standard deviation of 22.3 gm/m 2. 88.3% of patients had increased LVMI; among them, the majority belonged to stage IV followed by stage V and stage III respectively. A significant positive correlation was present between stages of CKD and LVMI (P value<0.001; Spearman correlation coefficient =0.369). The study done by Szu-Chia Chen, et al
reported a significant trend for stepwise increase in LVMI and the prevalence of left ventricular hypertrophy corresponding to the advancement of CKD stages 9. LVMI was further categorized with respect to relative wall thickness and we found 43.3% patients had concentric LVH; 33.3% of patients had eccentric LVH and 23.4% had concentric remodeling. 70% of patients with eccentric LVH were in stage V. Concentric LVH prevalence increased with advancement of stages of CKD up to stage IV in our study. No significant correlation was found between stages of CKD and categories of LVMI. Park, et al measured LV mass for LVH and found linear correlation and significant association between LV mass and worsening kidney function15. In this study cohort, 13% of patients had eccentric hypertrophy, 36% patients had concentric hypertrophy, 30% had concentric remodeling and 21% had normal LV geometry. The study done by Rathod Nitin R, et al reported the incidence of LVH in 40% of CKD patients and 40 % of LVH was concentric type and 60% was an eccentric type13. In our study, 83.3% patients had diastolic dysfunction. This finding is comparable to a similar study by Chelilah, et al where diastolic dysfunction was present in 74% patients12. In the CRIC study (stage 2-4 CKD) diastolic function was abnormal in 71% of patients15. In our study population, among the patients with CKD stage I, 80% had no diastolic dysfunction. Majority (41.6%) of the patients had grade II diastolic dysfunction; among this group, it was highest in stage IV CKD patients. Grade III diastolic dysfunction was present in 20% of total patients and it was highest (66.7%) among stage V CKD patients. A head on comparison was done between stages of CKD and grade of diastolic dysfunction with Chi square test. There was significant association (P value <0.001) and spearman Rho correlation was 0.693; significant positive correlation was noted that is increase in diastolic dysfunction with progressive stages of CKD. The mean value of E/A and E/E’ increased progressively with advanced stages of CKD and it was statistically significant and positively correlated. This finding is comparable to the study done by Beata Franczyk, et al; this study found that LA size and E/E’ increases significantly in later stages of CKD and also E/E’ is the best predictor of Diastolic Dysfunction16. In a similar study, Takenori Otsuka, et al found that severity of kidney dysfunction increased significantly in parallel with the rise of E/E’ (P<0.02), which is corroborative with our study17. The study done by Shady Elhusseiny, et al found significant direct correlation between GFR and E/MED
E’ and LAT E’. There was significant inverse correlation between GFR and LA size , E/A and grades of LVDD 18 . In our study, LVH (concentric and eccentric) was present in 76.6 % patients; LV systolic dysfunction was present in 23.3% patients and LV diastolic dysfunction was present in 83.3% patients. A similar study by Ahmed, et al reported LVH in 80% patients; LV Diastolic Dysfunction in 53.3% patients and LV Systolic Dysfunction in 36.3% patients19. LVSF and LVH findings were corroborative to this study. Another study by Laddha, et al reported LVH in 74.3% patients, diastolic dysfunction in 61.4%, systolic dysfunction in 24.3% patients 11 . The higher percentage of diastolic dysfunction in our study may be due to selection bias. In the study done by Chillo P, et al prevalence of LV systolic dysfunction was 16.2%20. Most of the patients were having ESRD.In our study, all the echocardiographic parameters were individually correlated with urine ACR and eGFR separately by Spearman Rho correlation coefficient. With urine ACR significant positive correlation was found with LVEF%, fractional shortening, negative correlation was found with LVIDd, LVIDs, LVMI, RWMA, E/E’ ,E/A ratio, LA diameter and grades of LV diastolic dysfunction. In a study conducted by Hiraki Nagai, et al it was found that urine ACR even at low level can be associated with significant diastolic dysfunction which corroborates with our study21 eGFR had significant positive correlation with fractional shortening, LVEF; significant negative correlation LVIDd, LVIDs, E/A, E/E’ ratio, LVMI, LA diameter and RWMA and grades of LVDD. A similar study done by K Matsushita, et al found lower eGFR and higher albuminuria were associated with increased LV mass, size, and systolic and diastolic dysfunction22. Association with systolic dysfunction was weaker than other LV parameters. The associations with eGFR were most evident at level <30ml/min/1.73m2 whereas even a high normal ACR of 10-29 mg/g demonstrated significant association with some cardiac abnormalities. Findings of association with eGFR corroborated with our study. Masugata, et al in a similar study has found that E/E’ increases with decreasing eGFR which is like the finding of this study23. In a similar study by Tarun Rao, et al showed that the prevalence of LV systolic dysfunction (Odds Ratio for Stage II was 1.8 and for stage V was 3.29) and LV diastolic dysfunction (Odds Ratio for stage II was 2.24 and for stage V was 6.6) increased with more severe renal dysfunction24. The mean EF decreased from 55.8 in CKD stage I to 53.1 in CKD stage 5, a similar finding was for fractional
shortening. The mean E/A increased from 1.15 in CKD stage I to 1.67 in CKD stage V. The mean E/E’ ratio increased from 9.1 in stage I to 11.8 in CKD stage V. Our study findings corroborated with this study.
Our cardinal effort in this study was to evaluate cardiac function in different stages of Chronic Kidney Disease with the help of 2D echocardiography in our Tertiary Care Hospital. In 60 diagnosed CKD patients of different stages participated in our study. In our study, LVH was the most common (76%) cardiac structural abnormality. LV diastolic dysfunction was present in 83.3% of patients and LV Systolic Dysfunction was present in 23.3% of patients. With advanced stages of CKD, there was a statistically significant increase in Left Ventricular Diastolic Dysfunction, Left Ventricular Mass Index and a statistically significant decrease in fractional shortening, LV Systolic Function. Estimated GFR also had a significant positive correlation with fractional shortening and a significant negative correlation with LVMI, LV diastolic dysfunction, and LV systolic dysfunction. In our study, we also found a significant positive correlation between urine ACR with fractional shortening and a significant negative correlation with LVMI, LV systolic dysfunction, and LVDD. LV diastolic dysfunction is present from the early stages of CKD. LV systolic function remains preserved till later stages and in our study, we found decreased LV systolic function from stage IV onwards. There is an increased prevalence of concentric hypertrophy in the early stages of CKD while eccentric hypertrophy was present mostly in stage V followed by stage IV. It may be possible to use eGFR and urine ACR as a predictive markers of worse cardiac function in CKD patients if they are properly followed up. Echocardiography should be used as an essential investigation for cardiac function evaluation in CKD patients in all stages.
1Ene-lordache B, Perico N, Bikbov B, Carminati S, Remuzzi A, Perna A, et al — Chronic kidney disease and cardiovascular risk in six regions of the world (ISN-KDDC): A cross-sectional study. Lancet Globe Health 2016; 4: e307-e319, 2016.
2Comprehensive Clinical Nephrology. JhonFeehally et al. Chapter 81. Cardiovascular Disease In Chronic Kidney Disease. Page-941-3.7Failure: Part I. Circulation 2002; 105: 1387-93.
3Zile MR, Brutsaert DL — New concepts in Diastolic Dysfunction and Diastolic Heart Failure: Part I. Circulation 2002; 105: 1387-93.
4Reddy YNV, Obokata M, Dean PG, Melenovsky V, Nath KA, Borlaug BA — Long-term cardiovascular changes following
Vol 122, No 09, September 2024Journal of the Indian Medical Association
creation of arteriovenous fistula in patients with end stage renal disease. Eur Heart J 2017; 38(24): 1913.
5Shamseddin MK, Parfrey PS — Sudden cardiac death in chronic kidney disease: epidemiology and prevention. Nat Rev Nephrol 2011; 7(3): 145-54. doi: 10.1038/nrneph.2010.191. Epub 2011 Feb 1. PMID: 21283136.
6Shady Hussein Elhusseiny. Assessment of Left Ventricle Diastolic Dysfunction in Chronic Kidney Disease Patients. Cardiology and Cardiovascular Research 2021; 5(1): 25-33.
7Hulley SB, Cummings SR, Browner WS, Grady D, Newman TB — Designing clinical research : an epidemiological approach .4th ed Philadelphia. PA : Lippincott Williams & Wilkins, 2013. Appendix 6C, page 79.
8Devereux RB, Alonso DR, Lutas EM — Echocardiographic assessment of left ventricular hypertrophy: comparison to necropsy findings. Am J Cardiol 1986; 57: 450.
9Chen SC, Chang JM, Liu WC, Tsai YC, Tsai JC, Su HM, et al — Stepwise Increases in Left Ventricular Mass Index and Decreases in Left Ventricular Ejection Fraction Correspond with the Stages of Chronic Kidney Disease in Diabetes Patients. Journal of Diabetes Research 2012; ID 789325, 7.
10Jameel FA, Junejo AM, Khan QUA, Date S, Faraz A, Rizvi SHM, et al — Echocardiographic Changes in Chronic Kidney Disease Patients on Maintenance Hemodialysis. Cureus 2020; 12(7): e8969. doi: 10.7759/cureus.8969. PMID: 32766011; PMCID: PMC7398731
11Laddha M, Sachdeva V, Diggikar PM, Satpathy PK, Kakrani AL — Echocardiographic assessment of cardiac dysfunction in patients of end stage renal disease on haemodialysis. J Assoc Physicians India 2014; 62: 28-32.
12Dharmaraj C — A Study on Prevalence of Left Ventricular Dysfunction And its Correlation With Estimated Glomerular Filtration Rate (Egfr) In Ckd Patients. IOSR Journal of Dental and Medical Sciences (IOSR- JDMS)
13Rathod Nitin R, Ghodasara Malay K, Shah Harsh D — Assessment of cardiac dysfunction by 2D echocardiography in patients with chronic kidney disease. JPBMS 2012; 17(07):
14Gupta R, Kumar A — Assessment of Left Ventricular Hypertrophy and Dysfunction in Patients of Chronic Kidney Disease. Academia Journal of Medicine 2020; 2(2): 211-6. https://doi.org/10.21276/ajm.2019.2.2.53.
15Park M, Hsu CY, Li Y, Mishra RK, Keane M, Rosas SE, et al — Association between kidney function and subclinical cardiac abnormalities in CKD. J Am SocNephrol 2012; 23: 172534.
16Franczyk-Skóra B, Gluba A, Olszewski R, Banach M, Rysz J — Heart function disturbances in chronic kidney diseaseechocardiographic indices. Archives of medical science : AMS 2024; 10(6): 1109-6. https://doi.org/10.5114/aoms.2014.47822.
17Otsuka T, Yoshikawa H, Sugi K — Left ventricular diastolic dysfunction in the early stage of chronic kidney disease.Division of Cardiovascular Medicine, Toho University Ohashi Medical Center, 2-17-6 Ohashi, Meguro-ku, Tokyo 1538515, Japan.
18Elhusseiny SH — Assessment of Left Ventricle Diastolic Dysfunction in Chronic Kidney Disease Patients. Cardiology and Cardiovascular Research 2021; 5(1): 25-33.
19Ahmed HA, Yassein YS, Zaki SA, Al Qersh AM, Fahim FS — Study of echocardiographic changes among adult patients on maintenance hemodialysis. Menoufia Med J 2016; 29: 44-51. 10.4103/1110-2098.178949.
20Chillo P, Mujuni E — Prevalence and predictors of left ventricular dysfunction among patients with chronic kidney disease attending Muhimbili National Hospital in Tanzania — a cross-sectional study. Research Reports in Clinical Cardiology 2018; 9: 11-21.
21Nagai H, Suzuki S, Ishii H, Shibata Y, Harata S, Takayama Y, et al — Impact of low-grade albuminuria on left ventricular diastolic dysfunction. IJC Metabolic & Endocrine 2015; 6: 136. ISSN 2214-7624, https://doi.org/10.1016/j.ijcme.2015.01.006.
22Matsushita K, Kwak L, Sang Y, Ballew SH, Skali H, Shah AM, et al — Josef Coresh, Scott Solomon. Kidney Disease Measures and Left Ventricular Structure and Function: The Atherosclerosis Risk in Communities Study. Journal of the American Heart Association 2017; 6: e006259.
23 Masugata H, Senda S, Goda F — Echocardiographic assessment of the cardio-renal connection: is left ventricular hypertrophy or diastolic function more closely correlated with estimated glomerular filtration rate in patientswith cardiovascular risk factors? Clin Exp Hypertens 2010.
24Rao R, Karwa M, Wanjari A — Left ventricular dysfunction among chronic kidney disease patients: a cross sectional study. DOI: http://dx.doi.org/10.18203/2349-3933.ijam20183390.
Neha Neha1, Bhavesh Kotak2, Kheya Uttam Ghosh3, A V Ravi Shankar4, Krishna Chaitanya Veligandla5, Rahul Rathod6
Infections are currently the greatest cause of disease Worldwide, with community-acquired infections having the most essential role. The growing resistance to antibiotics further intensifies the threat of infections, which remains a significant issue even after 50 years, necessitating the introduction of combination antibiotic therapies to achieve better treatment outcomes. Since its inception, patients of all ages, particularly newborns, children and adults, have extensively utilized the amoxicillin/clavulanate combination. The addition of clavulanic acid to amoxicillin widened the scope to encompass strains that produce beta-lactamases in addition to other bacterial species. The increasing prevalence of antibiotic resistance necessitates higher antibiotic doses for effective treatment of infections. Amoxicillin/ clavulanate plays a crucial role in the treatment of a variety of infections, particularly Respiratory Tract Infections, in adults and children globally; this is due to the development of increased dosage schedules and improved formulations. Amoxicillin/clavulanate is frequently recommended by international and national prescribing guidelines for the management of community-acquired infections. The ATLAS and SOAR susceptibility investigations, which demonstrate that the susceptibility of the common respiratory pathogens, S. pneumoniae and H influenzae, remains strong, supported these recommendations in India. Inadequate or early discontinuation of antibiotic therapy may result in recurrent infections, treatment failure and the emergence of antibiotic resistance. Therefore, healthcare providers and caregivers need to ensure that paediatric patients complete their prescribed course of amoxicillin/clavulanate to enhance its therapeutic advantages while reducing the risk of resistance. The present review article is intended to give comprehensive information about amoxicillin/clavulanate and its use in pediatric infections in outpatient settings.
[J Indian Med Assoc 2024; 122(9): 54-61]
Key words :Amoxicillin/Clavulanate, Outpatient, Paediatric, URTI, ASOM, Higher Strength.
Infections continue to be one of the major causes of morbidity and mortality in the paediatric age group, around the World. As a result, both in newborns and children, antibiotics are among the most frequently recommended drugs1. The first natural antibiotic in the 20th century was penicillin, discovered by Fleming in 1928. The first β-lactamase inhibitor- clavulanic acid was derived from Streptomyces clavuligerus. The years that followed (1940-1970), are referred to as “the golden era” of antibiotic evolution because of the significant increase in the rate of antibiotic discovery that occurred during this time1,2. Since its introduction in the 1970s, amoxicillin has become the most popular penicillin, both alone and in combination with
Department of Medical Affairs, Dr Reddys Laboratories Ltd, Hyderabad 500034
1MD, Medical Advisor and Corresponding Author
2MBBS, MS, FRCS, Medical Director
3MBBS, DCH, DNB, Associate Professor, Department of NICU, In-charge
4MBBS, DCH, DNB, FAAP, Consultant Pedeatrician, Department of Paediatrics, Kauvery Hospital, Chennai, Tamil Nadu 600018
5MBBS, MBA, Cluster Head
6MBBS, MD, Cluster Head
Received on : 14/05/2024
Accepted on : 16/05/2024
Editor's Comment :
The amoxicillin/clavulanate combination remains a widely used antibiotic in paediatric outpatient care for various infections, including URTIs, UTIs, AOM and CAP.
According to the WHO AWaRe classification, amoxicillin/ clavulanate is categorized in the “Access group,” making it a first or second choice for treating common infections while minimizing antibiotic resistance. Its effectiveness in managing resistance and maintaining treatment efficacy in children underscores its ongoing importance in outpatient care.
clavulanic acid3. Streptomyces clavuligerus was used to isolate the first β-lactamase inhibitor, clavulanic acid. It is referred to as a “suicide inhibitor” because of its ability to inactivate β -lactamase via secondary chemical interactions and complex formation1,4
Amoxicillin/clavulanate is a cornerstone antibiotic in primary care settings and Emergency Departments across the nation. It is a proportionate composite of two different medicines: amoxicillin and clavulanic acid3. This combination is used as a broad-spectrum antibiotic for treatment against a variety of bacterial infections as clavulanic acid effectively inhibits the βlactamase enzyme and enhances the antibacterial activity of amoxicillin 4 . Although amoxicillin and
122, No 09, September 2024Journal
ampicillin share the same spectrum of activity and potency, amoxicillin demonstrated superior oral absorption, resulting in a plasma exposure that is almost double that of ampicillin5,6.
Table 1 — Ratio of amoxicillin/potassium clavulanate of varying strengths in oral suspension and tablet 12
Amoxicillin/ Potassium clavulanateAmoxicillin/ Potassium (Oral Suspension)clavulanate (Oral Tablet)
•125 mg /31.25 mg per 5 mL (4:1)•250mg/125 mg (2:1)
Amoxicillin is an analog of penicillin and exhibits identical activity against gramnegative bacteria and Gram-positive bacteria, including Salmonella spp, Shigella spp, Borrelia species, Enterococcus species, Corynebacterium diphtheria, Moraxella catarrhalis, Haemophilus influenzae, Listeria monocytogenes, Streptococcus species, Klebsiella pneumoniae and Escherichia coli. Additionally, with the addition of clavulanic acid, the spectrum is widened to cover all the strains of the abovementioned microorganisms and includes methicillinsensitive Staphylococcus aureus (MSSA), Capnocytophaga canimorsus, Pasteurella multocida, Proteus species, Neisseria species, among others7,8
•200 mg /28.5 mg per 5 mL (7:1)•500mg/125mg (4:1)
•250 mg /62.5 mg per 5 mL (4:1)•875mg/125 mg (7:1)
•400 mg /57 mg per 5 mL (7:1)•200 mg/28.5 mg (chewable)
•400 mg/57 mg (chewable)
•600 mg/42.9 mg per 5 mL (14:1)•1000mg/62.5mg (The extended(The extended-release formulationrelease 12 hr formulation cannot cannot be used in place of otherbe used in place of other immediate-release strengths).immediate release strengths).
Amoxicillin/clavulanate is orally administered to treat Upper Respiratory Tract Infections (URTI), Community-acquired Pneumonia (CAP), Acute Otitis Media (AOM) as well as Urinary Tract Infections (UTIs). Amoxicillin/clavulanate is available in various formulations including multiple-dose formulations for adults and paediatrics in different parts of the World.6 Oral formulations of this antimicrobial are available as immediate or extended-release tablets, chewable tablets or reconstituted suspensions. Taking it with food improves its absorption and reduces adverse GI symptoms9-11. Amoxicillin 250 mg and potassium clavulanate 125 mg strength tablets are not recommended in paediatric patients, due to a higher amount of clavulanate than other strengths1,3 The initial ratio for an amoxicillin-clavulanic acid combination, due to clavulanic acid’s high affinity for ß-lactamases, was set at 4:1, administered in a three times daily dosage regimen; ratios of 2:1, 7:1, 14:1, and 16:1 are currently available in different countries12. To make it more palatable in the paediatric population, oral suspension can be flavored. It is necessary to maintain a consistent amoxicillin-toclavulanate ratio because clavulanic acid does not require substantial quantities to effectively inhibit ßlactamase enzymes (Table 1). The reconstituted solution must be stored in the refrigerator and wellshaken prior to use to increase the durability and potency3,11
Pharmacokinetics (PK) and Pharmacodynamics (PD) Characteristics of Amoxicillin/Clavulanate: Amoxicillin/clavulanate both exhibit good oral
absorption from the Gastrointestinal tract (about 60% oral bioavailability). Both components ie, amoxicillin and clavulanic acid had similar PK parameters after oral administration and they did not affect the PK parameters of each other 6,13,14 . Following oral ingestion, amoxicillin/clavulanate exhibits a half-life of approximately 1.3 hours for amoxicillin and 1 hour for clavulanate. Both components of the drug have low levels of binding to proteins in the bloodstream, with amoxicillin being bound to serum proteins by around 18% and clavulanate by approximately 25%. Overall, amoxicillin/clavulanate is known to distribute effectively throughout various tissues in the body6
Antimicrobial Resistance and Antibiotic Susceptibility of Respiratory Pathogens : Insights from Global Surveillance Studies
Anti-microbial Resistance (AMR) is primarily caused by the improper use of antibiotics by doctors and patients. Drug resistance can be determined with the help of the tripartite interaction between the host, antibiotics and pathogens15,16. As per World Health Organization (WHO), AMR is caused by genetic alterations and is accelerated by antibiotic misuse and overuse 17 Streptococcus pneumoniae (S pneumoniae) strains can have “intermediate” or “high” penicillin resistance. Penicillin-resistant Streptococcus pneumoniae (PRSP) isolates typically have minimum inhibitory concentrations (MIC) >2 to 4 µg/mL; isolates with MICs >4 or MIC >8 µg/mL are uncommon even though there are regional variations in resistance rates. Paediatric patients who fail to benefit from the initial therapy or who have recently taken antibiotics (within the last two to four weeks) for any other indication frequently have strains of S pneumonia with both intermediate and high-level penicillin resistance (PISP/PRSP)18,19
The Survey of Antibiotic Resistance (SOAR) during 2012-14 conducted in various regions analyzed respiratory isolates of H influenzae, M catarrhalis, S pneumoniae and S pyogenes 15,23 . The survey
122, No 09, September 2024Journal
revealed that amoxicillin/clavulanate demonstrated high susceptibility rates for M catarrhalis, H influenzae, and pathogens causing CAP (Table 2)15,23. Various breakpoints were utilized in the analysis of the new SOAR data including Clinical and Laboratory Standards Institute (CLSI), the dose-specific European Committee on Antimicrobial Susceptibility Testing (EUCAST) and PK/PD breakpoints24
A global AMR surveillance program with a fully searchable database is called Antimicrobial Testing Leadership and Surveillance (ATLAS). It covers the susceptibilities of a variety of bacterial and fungal pathogens to various antimicrobials and is available for general access to all. CLSI and EUCAST breakpoints are used to examine ATLAS data. Accessible susceptibility data for India is only available for a limited subset of S. pneumoniae isolates from 2019 (n = 11) and H Influenzae isolates from 2016 (n = 23) and 2019 (n = 37) (Table 3)25
Another SOAR study, conducted by Torumkuney, et al in Greece between 2014 and 2016 and published in 2018, (Table 3) concluded that these drugs are ineffective as monotherapy for community-acquired Respiratory Tract Infections due to the high prevalence of macrolide resistance among S pneumoniae and clarithromycin’s reduced activity against H influenzae26. Amoxicillin/clavulanate, on the
other hand, has shown excellent in vitro activity and is safe for use in paediatric patients, in contrast to equally effective fluoroquinolones26
Amoxicillin/clavulanic Acid (AMC); Antimicrobial Testing Leadership and Surveillance (ATLAS); Community-acquired Respiratory Tract Infections (CA-RTI); Clinical and Laboratory Standards Institute (CLSI); European Committee on Antimicrobial Susceptibility Testing (EUCAST); Pharmacokinetic/ pharmacodynamic (PK/PD); Survey of Antibiotic Resistance (SOAR); Sulfamethoxazole/trimethoprim (SXT); (% susceptibility is based on CLSI breakpoints).
Uses in Paediatric Outpatient Department (OPD): Initial dosage strengths for paediatric formulations were 20/5 or 40/10 mg/kg/day in three separate doses 6 . Currently, the recommended paediatric dosage for Mild to Moderate infections is 25/3.6 mg/ kg/day divided into two doses, while for severe infections, 45/6.4 mg/kg/day or 90/6.4 mg/kg/day (divided into two doses) is suggested6,22. Table 3 presents the indications and dosage regimens for amoxicillin/clavulanate based on guidelines from the US Food and Drug Administration (FDA) and the European Medicines Agency summary of product characteristics (SmPC).


Nearly half of antibiotics are prescribed in an outpatient setting for the treatment of URTIs, CAP, and AOM, which are common Respiratory Tract Infections as well as UTIs6,27
Treatment of Acute Otitis Media (AOM) :
AOM, a common childhood infection, arises commonly following acute URTIs and is the most prevalent reason for paediatric clinic visits and antibiotic prescriptions20. Immediate antibiotic therapy is advised for patients under 2 years with bilateral AOM, severe symptoms, spontaneous perforation, or recurrent episodes. In cases of uncertainty, antibiotic treatment may be considered for infants under 2 years with severe symptoms27-30. Table 4 lists the antibiotics in accordance with children’s age and clinical characteristics. In children with penicillin allergy, macrolides or cephalosporins can be used27,30
In severe cases, the approved dose of amoxicillin is 80-90 mg/kg/day. However, for children weighing above 20 kg, this may exceed the typical clinical dose of 1500 mg/day for adults. Therefore, a daily dosage of 1500 mg amoxicillin is considered acceptable for children over 20 kg 20. In children at low risk of colonization by resistant Streptococcus pneumoniae, 2 doses of amoxicillin alone or amoxicillin/clavulanate are indicated, whereas 3 doses are recommended for children at high risk27. The American Academy of
Paediatrics & American Academy of Family Physicians (AAP/AAFP) Guidelines recommended high-dose amoxicillin/clavulanate (90/6.4 mg/kg/day in 2 divided doses) as the preferred empirical treatment for AOM (approved 2013, reaffirmed 2019)19. Antibiotic treatment is recommended for 10 days in paediatric patients who are susceptible to adverse effects (under 2 years old and/or with spontaneous otorrhea). The duration of therapy can be reduced to 5 days, in children older than 2 years, without the risk of adverse evolution27
Treatment of Community-acquired Pneumonia (CAP) :
Community-acquired pneumonia has a high morbidity and mortality rate and is a significant public health problem in India 15. Based on the limited information available, it was suggested to take the following course of action: Children who have been vaccinated with pneumococcal conjugate vaccine and exhibit mild symptoms, do not require immediate antibiotic treatment, instead close monitoring is advised. The thorough evaluation of clinical, epidemiological, radiological, and laboratory data strongly suggests a viral infection. Therefore, timely evaluation is recommended and a careful follow-up should be ensured. In all other circumstances, antibiotic treatment is still recommended27,31,32
Vol 122, No 09, September 2024Journal
Table 4 — Recommended therapy in children with AOM, UTI, URTI and community-acquired pneumonia27,31,32

^Treatment with azithromycin, clarithromycin should be recommended in children under 6 weeks old. * In case of suspected infection by Mycoplasma pneumoniae, Chlamydia pneumoniae, or Bordetella pertussis. Staphylococcus aureus is unusual; if pleural fluid culture or haemoculture reveal S. aureus, oxacillin can be added, or vancomycin is advised in areas with methicillin-resistant S. aureus.
*Risk factors for bacterial resistance: age <3 years, daycare attendance, older siblings, and recent antibiotic therapy (<1 month).
** The dosage refers to amoxicillin.
122, No 09, September 2024Journal
For mild or moderate types, a course of therapy lasting 5-7 days is recommended. A prolonged duration of therapy (8–14 days) should be considered in severe and/or complicated cases and the event of suspected infection with Mycoplasma pneumoniae27,33,34
Treatment of Upper Respiratory Tract Infections (URTIs) :
URTIs pose significant public health challenges and contribute to both mortality and morbidity in developed and developing countries. In India, URTIs affect a substantial portion of the population, with prevalence rates of approximately 52%35,36. URTI includes acute pharyngitis, rhinosinusitis and AOM which are common in children 24. When treating URTIs, antibiotics with broad-spectrum activity are commonly prescribed to target not only the primary pathogen, such as Pneumococcus, but also other clinically relevant colonizing bacteria like S aureus, H influenzae, and M catarrhalis. Besides amoxicillin/ clavulanate, cephalosporins and macrolides are frequently recommended broad-spectrum antibiotics for treating RTI36
The recommended dose of amoxicillin/clavulanate is 875 mg/125 mg taken twice daily, 500 mg/125 mg taken three times daily, or 2000 mg/125 mg taken twice daily along with either doxycycline or macrolide. NICE 2019 guidelines recommend amoxicillin/ clavulanate as the initial treatment of choice for severe symptoms for adults and paediatric patients aged more than a month and below 18 years24,37
Treatment of Urinary Tract Infections (UTIs) :
UTIs in paediatrics, primarily caused by E coli and other Enterobacteriaceae , carry the risk of complications and renal scarring 38 . A significant concern to the health of the general population is posed by the rise of extended-spectrum β-lactamaseproducing Enterobacteriaceae (ESBL-E) as a cause of febrile UTI39-41. However, recent studies indicate that amoxicillin/clavulanate retains substantial susceptibility against modern Enterobacterales causing UTIs6.
The study by Beytur et al. suggested that if the causative agent is susceptible, amoxicillin/clavulanate may be effective for ESBL-positive UTIs. However, strains with high amoxicillin/clavulanate MICs may develop resistance during therapy42. Another study by Wilkowski, et al found that high doses of oral amoxicillin/clavulanate could overcome the resistance of ESBL-producing K pneumoniae strains, providing a safe and affordable substitute for carbapenems in specific UTIs43
Amoxicillin/clavulanate combination remains a commonly used antibiotic in paediatric outpatient settings for various infections, including URTIs, UTIs, AOM and CAP. Despite the availability of other antibiotic options, amoxicillin/clavulanate continues to be recommended as the first-choice treatment for these paediatric infectious diseases. WHO has developed the AWaRe classification to guide antibiotic selection based on their importance in treating common infections while minimizing antibiotic resistance. Amoxicillin/clavulanate falls into the “Access” group, which includes antibiotics recommended as first or second choices for frequent infections, unlike other antibiotics like Azithromycin, Cefixime and Cefuroxime which fall under the “Watch” group. This classification highlights the continued relevance and effectiveness of amoxicillin/clavulanate in paediatric outpatient settings44
International and country-specific local antibiotic prescribing guidelines frequently recommend amoxicillin/clavulanate to treat community acquiredRTIs. These recommendations in India are supported by the ATLAS and SOAR susceptibility studies, which demonstrate that S pneumoniae and H influenzae are still highly susceptible RTI pathogens24
While these medications are generally safe and effective, they can sometimes cause adverse effects in children. Two common adverse effects encountered with amoxicillin/clavulanate in paediatric patients are low compliance and diarrhoea. Poor adherence to recommended antibiotic treatment may cause worsening of patients’ health or delays in recovery. Additionally, it might cause a rise in hospital admissions and expenses, in addition to the emergence of antibiotic-resistant bacteria45
In an Indian Real-World prospective study done by Jaydeep Chaudhary, et al, it was found that the production method of amoxicillin impacts the quality of the resulting antibiotic formulation. The study further showed that a biocatalytic or enzymatic method of preparation was found superior and 81.25% of clinicians believed that Good Manufacturing Practices (GMP) played a critical role in the occurrence of gastrointestinal side effects45 This study proved that the attributes of the antibiotic depend upon the manufacturing process and can have a direct influence on the antibiotic efficacy, side effects and hence compliance to treatment.
Compliance as we are aware may be affected by the dosage, duration, palatability, formulation, side effects and cost of the medication. Children’s medication compliance varies widely, between 11%
122, No 09, September 2024Journal
to 93%46-48. There exists a strong perception among healthcare practitioners that all antibiotic courses must be completed as that would limit the risk of relapse and selection of resistant organisms. A study conducted by Chan, et al reported that over 30% of individuals non-adherent to antibiotic therapy showed a high prevalence of antibiotic resistance. In a similar Indian survey, clinicians agreed that non-adherence to oral antibiotic treatment poses a challenge and AMR was reported as a key consequence. It was perceived that a 60 ml dosage (instead of the commonly available 30 ml dosage) of amoxicillin/clavulanate addressed the challenges observed with non-compliance to antibiotic therapy completion45. Extended-release formulations of amoxicillin/clavulanate can provide sustained release of the medication over a longer period. This can help reduce fluctuations in drug concentration in the body and minimize GI side effects like diarrhoea. In randomized single-blind studies, twice-daily amoxicillin/clavulanic acid regimens were considerably less likely to cause diarrhoea than three times-daily regimens 11 Importance of GMP of amoxicillin/ clavulanate is crucial for treatment outcomes ie, safety and effectiveness.
In a large non-comparative trial involving children with AOM, the administration of a high-dose formulation of amoxicillin/clavulanate (90/6.4 mg/kg/ day in 2 divided doses) demonstrated substantial efficacy against penicillin-resistant S pneumoniae strains (with penicillin MICs of 2 or 4 mg/L, surpassing the maximum threshold limit of the US indication for S pneumoniae is 2 mg/L)11. Amoxicillin and clavulanic acid in sufficient doses are effective against ßlactamase-positive bacteria as well as susceptibleto-medium-resistant S pneumoniae . For these reasons, oral amoxicillin is commonly recommended by clinicians, with or without a β-lactamase inhibitor, unless patients have allergies to penicillin20. Dagan, et al conducted a study to evaluate the efficacy of a high dosage of amoxicillin/clavulanate (90/6.4 mg/kg/ day) in treating AOM. The results demonstrated that this particular formulation was highly effective against H influenzae, eliminating the pathogen in 94.0% of patients (78 out of 83) within 4-6 days22,49
The clinical use of amoxicillin/clavulanate in UTI is questionable given the increased prevalence of ESBLs Worldwide. Oral cephalosporins such as ceftibuten, cefpodoxime and cefixime are less susceptible to ESBLs and stable to OXA-1 as compared to amoxicillin, making them potential alternatives when used in conjunction with clavulanate for treatment of UTIs. To treat UTIs caused by ESBLproducing Klebsiella spp and E coli amoxicillin/
clavulanate can be used in conjunction with thirdgeneration oral cephalosporins such as cefpodoxime or ceftibuten6
In real-world evidence, physicians prescribe antibiotics based on their knowledge of the disease’s pathogenesis, the course of the illness, the responsible pathogens, the severity of the condition, and pharmacological expertise20
In conclusion, amoxicillin/clavulanate remains a relevant and valuable antibiotic in the management of paediatric infections in outpatient settings. Its broadspectrum activity, good PK properties and high susceptibility rates against common respiratory pathogens make it a preferred choice for the therapeutic management of URTIs, AOM, CAP and UTIs in paediatric patients. However, to preserve the effectiveness of antibiotics and prevent the development of antimicrobial resistance, it is crucial to exercise caution in their utilization. This cautious approach helps to safeguard the potency of these medications for future use.
1Keij FM, Tramper-Stranders GA, Koch BCP — Pharmacokinetics of Clavulanic Acid in the Paediatric Population: A Systematic Literature Review. Clin Pharmacokinet 2022; 61: 63753.
2Brown ED, Wright GD — Antibacterial drug discovery in the resistance era. Nature 2016; 529: 336-43.
3Evans J, Hanoodi M, Wittler M — Amoxicillin Clavulanate, http://www.ncbi.nlm.nih.gov/pubmed/7037354 (2023).
4SAM KD — Pharmacokinetics of Amoxicillin/Clavulanic Acid Combination after Oral Administration of New Suspensions Formulation in Human Volunteers. Int J Pharmacol 2007; 3: 265-9.
5Geddes AM, Klugman KP, Rolinson GN — Introduction: historical perspective and development of amoxicillin/clavulanate. Int J Antimicrob Agents 2007; 30 Suppl 2: S109-12.
6Veeraraghavan B, Bakthavatchalam YD, Sahni RD — Orally Administered Amoxicillin/Clavulanate: Current Role in Outpatient Therapy. Infect Dis Ther 2021; 10: 15-25.
7Benninger MS — Amoxicillin/clavulanate potassium extended release tablets: a new antimicrobial for the treatment of acute bacterial sinusitis and community-acquired pneumonia. Expert Opin Pharmacother 2003; 4: 1839-46.
8Brogden RN, Carmine A, Heel RC — Amoxycillin/clavulanic acid: a review of its antibacterial activity, pharmacokinetics and therapeutic use. Drugs 1981; 22: 337-62.
9Jacobs MR — Extended release amoxicillin/clavulanate: optimizing a product for respiratory infections based on pharmacodynamic principles. Expert Rev Anti Infect Ther 2005; 3: 353-60.
10Stein GE, Gurwith MJ — Amoxicillin-potassium clavulanate, a beta-lactamase-resistant antibiotic combination. Clin Pharm 1984; 3: 591-9.
11Easton J, Noble S, Perry CM — Amoxicillin/clavulanic acid: a review of its use in the management of paediatric patients with acute otitis media. Drugs 2003; 63: 311-40.
Vol 122, No 09, September 2024Journal of
12Huttner A, Bielicki J, Clements MN — Oral amoxicillin and amoxicillin-clavulanic acid: properties, indications and usage. Clin Microbiol Infect 2020; 26: 871-9.
13Fatima A, Jiyad Shaikh M, Zahid H — Clinical Pharmacokinetics of Clavulanic Acid, a Novel β- Lactamase Isolated from Streptomyces clavuligerus and Its Variability. In: Medicinal Chemistry. IntechOpen. Epub ahead of print 13 March 2019. DOI: 10.5772/intechopen.79409.
14MacGregor RR, Graziani AL — Oral administration of antibiotics: a rational alternative to the parenteral route. Clin Infect Dis 1997; 24: 457-67.
15Budhiraja S, Agarwal A, Chugh Y — Amoxicillin+clavulanic acid in community acquired pneumonia: Past, present, and future from an Indian perspective. Asian J Med Sci 2022; 13: 235-44.
16Nuermberger EL, Bishai WR — Antibiotic Resistance in Streptococcus pneumoniae: What Does the Future Hold? Clin Infect Dis 2004; 38: S363-S371.
17Antimicrobial Resistance. World Health Organization, https:// www.who.int/news-room/fact-sheets/detail/antimicrobial-resistance (2021).
18Mamishi S, Moradkhani S, Mahmoudi S — Penicillin-Resistant trend of Streptococcus pneumoniae in Asia: A systematic review. Iran J Microbiol 2014; 6: 198-210.
19Lahiry S, Dalal K, Pawar A — High-Dose amoxicillin supported with clavulanic acid as empirical therapy in acute otitis media. Asian J Med Sci 2021; 12: 134-144.
20Chu C-H, Wang M-C, Lin L-Y — High-dose amoxicillin with clavulanate for the treatment of acute otitis media in children. Scientific World Journal 2013; 2013: 965096.
21The United States Food and Drug Administration. Prescribing information for Augmnetin. GSK. 2006. US Food and Drug Administration , https://www.accessdata.fda.gov/ drugsatfda_docs/label/2008/050564s051lbl.pdf (2006).
22White AR, Kaye C, Poupard J — Augmentin (amoxicillin/ clavulanate) in the treatment of community-acquired respiratory tract infection: a review of the continuing development of an innovative antimicrobial agent. J Antimicrob Chemother 2004; 53 Suppl 1: i3-20.
23Torumkuney D, Chaiwarith R, Reechaipichitkul W — Results from the Survey of Antibiotic Resistance (SOAR) 2012-14 in Thailand, India, South Korea and Singapore. J Antimicrob Chemother 2016; 71 Suppl 1: i3-19.
24Torumkuney D, Poojary A, Shenoy B — Country data on AMR in India in the context of community-acquired respiratory tract infections: links between antibiotic susceptibility, local and international antibiotic prescribing guidelines, access to medicine and clinical outcome. J Antimicrob Chemother 2022; 77: i10–i17.
25Antimicrobial Surveillance- Pfizer, https://www.pfizer.com/science/focus-areas/anti-infectives/antimicrobial-surveillance.
26Torumkuney D, Papaparaskevas J, Morrissey I — Results from the Survey of Antibiotic Resistance (SOAR) 2014-16 in Greece. J Antimicrob Chemother 2018; 73: v36-v42.
27Chiappini E, Mazzantini R, Bruzzese E — Rational use of antibiotics for the management of children’s respiratory tract infections in the ambulatory setting: an evidence-based consensus by the Italian Society of Preventive and Social Paediatrics. Paediatr Respir Rev 2014; 15: 231-6.
28Lieberthal AS, Carroll AE, Chonmaitree T — The diagnosis and management of acute otitis media. Paediatrics 2013; 131: e964-99.
29Marchisio P, Bellussi L, Di Mauro G — Acute otitis media: From diagnosis to prevention. Summary of the Italian guideline. Int J Pediatr Otorhinolaryngol 2010; 74: 1209-16.
30Venekamp RP, Sanders S, Glasziou PP — Antibiotics for acute otitis media in children. Cochrane database Syst Rev 2013; CD000219.
31Bradley JS, Byington CL, Shah SS — Executive summary: the management of community-acquired pneumonia in infants and children older than 3 months of age: clinical practice guidelines by the Paediatric Infectious Diseases Society and the Infectious Diseases Society of America. Clin Infect Dis 2011; 53: 617–30.
32Esposito S, Cohen R, Domingo JD — Antibiotic therapy for paediatric community-acquired pneumonia: do we know when, what and for how long to treat? Pediatr Infect Dis J 2012; 31: e78-85.
33Haider BA, Saeed MA, Bhutta ZA — Short-course versus longcourse antibiotic therapy for non-severe community-acquired pneumonia in children aged 2 months to 59 months. Cochrane database Syst Rev 2008; CD005976.
34Kabra SK, Lodha R, Pandey RM — Antibiotics for community acquired pneumonia in children. Cochrane database Syst Rev 2006; CD004874.
35Amsath C. Manikanadan ANDA — Antibiotic Susceptibility of Bacterial Strains Isolated from Patients with Respiratory Tract Infections. Int J Pure Appl Zool; 1.
36Sharma A, Teli C, Aiwale A SNA — Prospective Comparative Study to Evaluate the Susceptibility of Bacterial Strains Isolated from Patients with Respiratory Tract Infection to Cefpodoxime Plus Clavulanic Acid and to Amoxicillin Plus Clavulanic Acid. Int J Sci Stud 2020; 8: 101-9.
37NICE. Guideline NG 138. Pneumonia (community-acquired): Antimicrobial Prescribing, https://www.nice.org.uk/guidance/ ng138.
38Madhi F, Jung C, Timsit S — Febrile urinary-tract infection due to extended-spectrum beta-lactamase-producing Enterobacteriaceae in children: A French prospective multicenter study. PLoS One 2018; 13: e0190910.
39Pitout JDD, Laupland KB — Extended-spectrum betalactamase-producing Enterobacteriaceae: an emerging public-health concern. Lancet Infect Dis 2008; 8: 159-66.
40Livni G, Ashkenazi S — Treatment of resistant bacterial infections in children: thinking inside and outside the box. Adv Exp Med Biol 2013; 764: 123-32.
41Lignieres G, Birgy A, Jung C — Relay oral therapy in febrile urinary tract infections caused by extended spectrum betalactamase-producing Enterobacteriaceae in children: A French multicenter study. PLoS One 2021; 16: e0257217.
42Beytur A, Yakupogullari Y, Oguz F — Oral amoxicillin-clavulanic Acid treatment in urinary tract infections caused by extendedspectrum Beta-lactamase-producing organisms. Jundishapur J Microbiol 2015; 8: e13792.
43Wilkowski P, Hryniewiecka E, Jasiñska K — Breaking Antimicrobial Resistance: High-Dose Amoxicillin with Clavulanic Acid for Urinary Tract Infections Due to Extended-Spectrum BetaLactamase (ESBL)-Producing Klebsiella pneumoniae. Ann Transplant 2023; 28: e939258.
44AWaRe Classification. World Health Organization, https:// www.who.int/publications/i/item/2021-aware-classification.
45Kardas P — Patient compliance with antibiotic treatment for respiratory tract infections. J Antimicrob Chemother 2002; 49: 897-903.
46Hoppe JE, Wahrenberger C — Compliance of paediatric patients with treatment involving antibiotic suspensions: a pilot study. Clin Ther 1999; 21: 1193-201.
47Winnick S, Lucas DO, Hartman AL — How do you improve compliance? Paediatrics 2005; 115: e718-24.
48Patel D, Acharya U, Shinde M — Compliance to antibiotic therapy at paediatric out-patient clinic. J Fam Med Prim Care 2022; 11: 1012.
49Dagan R, Hoberman A, Johnson C — Bacteriologic and clinical efficacy of high dose amoxicillin/clavulanate in children with acute otitis media. Pediatr Infect Dis J 2001; 20: 829-37.
Umakanta Mahapatra1, Prantick Kumar Bhunia2, Bijoy Kumar Murmu3, Soumya Kundu4
Scrub Typhus is an endemic zoonotic disease caused by rickettsial bacteria, Oriental tutugamushi. It is a major public health problem in many parts of India. It is often under diagnosed and under reported due to lack of awareness among the clinicians and testing facilities. Fever is the usual presenting symptom. Other signs and symptoms are headache, myalgia, cough, hepatosplenomegaly, abdominal pain and lymphadenopathy. Although eschar is the single most pathognomonic feature of scrub Typhus, it is present in 43.5-87% of cases. Due to a lack of awareness among clinicians and diagnostic facility in rural areas, fatal complications such as Acute Respiratory Distress Syndrome (ARDS), meningoencephalitis, pneumonitis, acute kidney injury and myocarditis may occur in patients who are not treated early. Here we are presenting a case series of ten cases of scrub Typhus patients admitted in tertiary care hospital of rural parts of West Bengal. Initially one of them had acute kidney injury and another patient developed jaundice, but all recovered completely within a few weeks. All patients responded to Doxycycline (200 mg/day for 7 days). Death is attributable to delayed presentation, delayed diagnosis, and drug resistance. Timely commencement of empirical antibiotic therapy, after careful clinical assessment in limited diagnostic facility setup may prevent the morbidity and the mortality. The clinicians should be aware of this serious but easily curable diseases. [J Indian Med Assoc 2024; 122(9): 62-5]
Key words :Scrub Typhus, Case series, Rural Bengal.
Scrub Typhus is a mite-transmitted, acute febrile illness caused by bacterium Orientia tsutsugamushi. It was a military disease that caused thousands of cases during Second World War. The original name of Scrub Typhus was “tsutsugamushi diseases” (by Hashimoto in 1810). It is highly prevalent in rural areas where there is difficulty in timely diagnose and treatment. It was estimated that about one bilion people was at risk of this disease and annual incidence was one million1. The World Health Organization (WHO) described Scrub Typhus as one of the most under diagnosed and under reported febrile illness and strongly emphasized surveillance owing to its relatively high case fatality rate (up to 30 % in untreated patients)2 Scrub Typhus is prevalent in many parts of India especially in east, south and Himalayan region3. Scrub Typhus outbreak
1DCH, MD, DM, Assistant Professor, Department of General Medicine, Midnapore Medical College and Hospital, Midnapore, West Bengal 721101 and Corresponding Author
2MD (Medicine), Senior Resident, Department of General Medicine, Deben Mahata Government Medical College & Hospital, Purulia, West Bengal 723147
3MD (Medicine), Associate Professor and Head, Department of General Medicine, Deben Mahata Government Medical College & Hospital, Purulia, West Bengal 723147
4MD (Pathology), Assistant Professor, Department of Pathology, Midnapore Medical College and Hospital, Midnapore, West Bengal 721101
Received on : 17/04/2022
Accepted on : 29/06/2023
Editor's Comment :
Scrub Typhus should be suspected in all cases of fever specially FUO, because it has a wide range of manifestations. Mortality is high if there is delay in initiation of treatment but outcome is excellent if treated early.
was reported for the first time in West Bengal from Darjeeling district in 20044. It is more prevalent in the northern part of West Bengal mainly Alipurduar, Jalpaiguri, Cooch behar and Darjeeling, as the areas are heavily forested and rich in wildlife biodiversity 5 . The disease is associated with agricultural or occupational exposures like exposure to Piles of wood, Domestic animals, Rodents and Rice fields.
The main pathology is focal or disseminated vasculitis due to endothelial dysfunction and perivascular infiltration of leukocytes.
After an incubation period of 6 to 21 days (usually, 10-12 days), the patients present with fever with Chill, Headache, Myalgia, Cough and Gastrointestinal symptoms6. The severity of presentation varies widely, depending on the susceptibility of the host, the virulence of the organism or both. Complications such as Pneumonia, Acute Respiratory Distress Syndrome (ARDS), Myocarditis, Meningoencephalitis, Encephalitis, Hepatitis, DIC, Haemophagocytic Syndrome, Acute Kidney Injury (AKI), Acute Pancreatitis, Transient Adrenal Insufficiency and SubAcute Painful Thyroiditis are not uncommon in
122, No 09, September 2024Journal
untreated patients. The presence of characteristic eschar (blistered ulcer covered with black crust and surrounded by reddish erythema) at the bite site was considered to be pathognomonic of Scrub Typhus7
Diagnosis of Scrub Typhus is clinically difficult; hence laboratory tests play an important role. A high index of suspicion for Scrub Typhus is necessary in febrile patients not responding to conventional antibiotics. The response to antibiotics in Scrub Typhus is excellent.
Although Scrub Typhus is endemic in our country, it is under diagnosed because of the non-specific symptomatology, lack of access to diagnostic facilities in rural areas and low index of suspicion by the physicians.
We are reporting a case series of ten cases of Scrub Typhus patients admitted in Tertiary Care Hospital of Rural Parts of west Bengal. Presentation of the Cases :
Total ten patients admitted in inpatient Department of General Medicine, Deben Mahata Government Medical College, Purulia, West Bengal during July, 2022 to September, 2022. Median age of the patients was 21.5 years. Majority of them were engaged in cultivation (six patients were farmer and four were student). Co-morbidity (diabetes) was present only in two patients. Fever was the most common symptoms. Headache and myalgia was also common. Three patients had tachycardia but Blood Pressure was normal in all. Jaundice was present in one patient. One patient was anaemic. Necrotic eschar was noted only in one patient (Fig 1). Although five patients complain of cough, abnormal auscultatory finding was present in one patient only (Table 1). Examination cardiovascular and Central Nervous System was unremarkable.

Complete Hemogram revealed Leukocytosis in two patients and one had Anaemia (Table 2). Platelet count was within normal limit in all. Urine R/E and M/ E did not reveal any abnormality. Renal Function Test (Urea/Creatinine – 60/1.8 mg/dl) was impaired in one patient. Liver Function Test (LFT) was reported normal except one (Bilirubin/Direct – 3/1.8 mg/dl, AST/ALT –424/458 IU/L, ALP 206IU/L and Protein/Albumin 6.5/ 4 gm/dl). Chest X-ray PA view showed no obvious abnormality (Fig 2).
All patients were tested positive for Scrub Typhus IgM ELISA and negative for RTPCR for COVID-19 in nasopharyngeal swab. Rapid diagnostic test for malarial parasite was negative. Serology for Dengue, Hepatitis B surface antigen (HBsAg), Hepatitis C virus and Human Immunodeficiency Virus (HIV) were also negative. Leptospira was negative for Case No 6.
Every one responded well to 7 days course with Doxycycline (200mg/day). Average duration of hospital stay was 4.9 days with a range from 4 to 6 days. On follow-up visit after two weeks, everybody
Duration of stay(day)5565444655
Co-morbidityNilNilNilNilDMDMNilNilNilNil Chief complaintFever,Fever,Fever,Fever,Fever,Fever,Fever,Fever,Fever,Fever, cough headache cough cough coughjaundice bodyache cough headache bodyache Vitals Spo298%98%98%98%98%98%98%98%98%98%
General
Table 2 — Biochemical parameters and outcome of the cases
Case 1Case 2Case 3Case 4Case 5Case 6Case 7Case 8Case 9Case 10 LaboratoryTLC (/cumm)800067001350092004600660076001150057006800 parametersUrea(mg/dl)45346035374344263632
Creatinine (mg/dl)1.00.81.81.20.70.60.60.50.70.7 LFTNNNNNANNNN CXRNNNNNNNNNN
ELISA+ve+ve+ve+ve+ve +ve+ve+ve+ve+ve Treatment andTreatmentD+SD+SD+SD+SD+SD+SD+SD+SD+SD+S outcomeOutcomeRRRRRRRRRR
TLC – Total leukocyte count. CXR- Chest X-ray PA View. ELISA- ELISA for Scrub Typhus. N – Normal. A – Altered. R – Recovered. D – Doxycycline. S - Supportive
were symptomatically better. Abnormal RFT in Case No 3 normalized in two weeks and LFT in Case No. 6 became normal in next four weeks.
DISCUSSION
Scrub Typhus is a rickettsial disease, widespread and prevalent in different parts of India especially in east, south and Himalayan region2. Scrub Typhus is a potential health concern in India due to poor health care, limited diagnostic facility, and the epidemiological trend of the disease. Humans are the accidental hosts. The disease is transmitted by the bite of larval stage of infected trombiculid mites8. The disease is more common in rainy season. Working in vegetable fields, hilly areas, and harvesting poses the highest risk. The causative organism is bacteria of the family Rickettsiaceae, that are obligate intracellular, Gram negative, non-flagellate pleomorphic coccobacilli. The clinical presentations range from sub-clinical disease to organ failure. Common clinical features are fever with chills, rashes, headaches, myalgia, regional lymphadenopathy. Necrotic Escher at the bite site are most pathognomonic of the disease. But different studies reported the presence of eschar in 43.5-87% of the cases9-11. Eschar is usually present on Caucasian and East Asian patients but is seen less frequently on South Asians, especially those who are dark skinned. It was unreported by our patients because of painless and nonpruritic nature of the lesion and complexion of the patients.
The disease usually runs a benign course but complication like, Hepatitis, Pneumonia, AKI, ARDS, Meningoencephalitis, Myocarditis, Conjunctival Injection, Subconjunctival Hemorrhage, Sepsis and Multiorgan failure are not uncommon. In a study of 502 Scrub Typhus patient, majority had stage 1 AKI and 3.94% of them required dialysis12. In our study one patient had AKI, due to early diagnosis and treatment, the patient recovered completely. Delay in the diagnosis for laboratory conformation may lead

to unfavourable outcome. Griffith M, et al reported 116 Scrub Typhus patient admitted in Critical Care Unit, 87.9% required ventilatory support and hospital mortality was 24%.
High degree of vigilance is required to look for alternative or overlapping possibilities. Malaria, Leptospira, Dengue, Meningococcal diseases, Typhoid, HIV and infectious mononucleosis may mimic and share many clinical features. The macular rash of dengue is finer. Malaria can be excluded by peripheral smear. Leptospirosis, typhoid and meningococcal disease can be diagnosed by culture of blood, CSF or bone marrow. Leptospirosis, infectious mononucleosis and HIV can be diagnosed by serology.
Serological test, widely used in India for diagnosis of Scrub Typhus was the Weil Felix (WF) test as it was easily available, highly specific but lacks
122, No 09, September 2024Journal
sensitivity13. Indirect Immuno-fluorescence Assay (IFA) is the gold standard test for diagnosis of Scrub Typhus. Although it is highly sensitive but its use is limited because of the cost and availability. IgM enzyme linked immuno-sorbent assay is commonly used. Different study showed that compared to IFA, IgM ELISA was quite satisfactory in diagnosing Scrub Typhus14 In view of the disadvantages of IFA and WF tests, IgM ELISA is currently preferred method. A rapid immuno-chromatographic assay using recombinant major outer membrane protein (r56) to detect IgM, IgG and IgA antibodies was shown to be reliable and suitable in developing countries but is expensive.
Doxycycline is the drug of choice. Azithromycin, rifampicin and tetracycline were found effective treatment options with more or less no difference15. Azithromycin is used in children below eight years, doxycycline resistant strains and pregnant women16 But empirical use of antibiotics in suspected Scrub Typhus may lead to emergence of resistant strains. As appropriate anti-biotic therapy shows rapid response in Scrub Typhus, cheap and effective drug such as doxycycline should be treatment protocol of acute febrile illness in patients during the endemic season.
High clinical suspicion is required as there is limited accesses to rapid test and low sensitivity of other test. During the outbreak of Scrub Typhus in north India in 2009, the patients were treated with empirical Doxycycline with 100% success rate17 Morbidity and mortality can be reduced by early initiation of appropriate antibiotics18
A high degree of clinical suspicion and familiarity with the various manifestations of Scrub Typhus allow early diagnosis and timely commencement of appropriate antibiotics therapy may reduce the morbidity and mortality.
(1)Scrub Typhus is endemic in different parts of India and all physician should bel aware of the disease.
(2)Delayed presentation, availability and cost of laboratory testing of Scrub Typhus are major problems in the rural areas of India.
(3)Physician should have a high degree of clinical suspicion and remain vigilant for alternate diagnosis in an area where Scrub Typhus is prevalent.
(4)In suspected cases of Scrub Typhus, empirical appropriate antibiotic treatment while waiting for confirmation and ruling out other possibilities, can prevent complications and death.
1Joo Jeong Y, Kim S, Dae Wook Y, Lee JW, Kim K, Hee Lee S — Scrub Typhus: Clinical, Pathologic, and Imaging Findings. Radio Graphics 2007; 27: 161-72.
2WHO Recommended Surveillance Standards WHO/CDS/ CSR/ISR/99.2. Second ed: World Health Organization http:// www.who.int/csr/ resources/publications/surveillance/ whocdscsrisr992.pdf?ua=1 Accessed 25 Aug 2015.
3Sharma PK — Scrub Typhus in Darjeeling, India: opportunities for simple, practical prevention measures. Transactions of the Royal Society of Tropical Medicine and Hygiene 2009; 103: 1153-8.
4Tilak R, Kunwar R, Wankhade B, Tilak VW — Emergence of Schoengastiella ligula as the vector of scrub Typhus outbreak in Darjeeling: Has Leptotrombidium deliense beenreplaced? Indian J Public Health 2011; 55: 92-9.
5Sharma PK, Ramakrishnan R, Hutin YJ, Barui AK, Manickam P, Kakkar M, et al — Scrub Typhus in Darjeeling, India: Opportunities for simple, practical preventionmeasures. Trans R Soc Trop Med Hyg 2009; 103: 1153-8.
6Huang CT, Chi H, Lee HC, Chiu NC, Huang FY — Scrub Typhus in children in a teaching hospital in eastern Taiwan, 2000-2005. South East Asian J Trop Med Public Health 2009; 40(4): 789-94.
7Senthilkumaran S, Balamurgan N, Karthikeyan V, Thirumalaikolundusubramanian P — Eschar- A Forgotten Focus of Concern. J Glob Infect Dis 2010; 2(2): 195-6.
8Aggarwal P, Mahesh DM, Ravi Kumar V, Himral P, Kaushal SS, Verma BS — Atypical Eschar Sites in Scrub Typhus in Sub-Himalayas. JAPI2009; 57: 153.
9Varghese GM, Trowbridge P, Janardhanan J — Clinical profile and improving mortality trend of scrub Typhus in South India. Int J Infect Dis 2014; 23: 39-43.
10Griffith M, Peter JV, Karthik G — Profile of organ dysfunction and predictors of mortality in severe scrub Typhus infection requiring intensive care admission. Indian J Crit Care Med 2014; 18: 497-502.
11Ogawa M, Hagiwara T, Kishimoto T — Scrub Typhus in Japan: epidemiology and clinical features of cases reported in 1998. Am J Trop Med Hyg 2002; 67: 162-5.
12Sedhain A, Bhattarai GR — Renal manifestation in Scrub Typhus during a major outbreak in central Nepal. Indian J Nephrol 2017; 27: 440-5.
13Amano K, Suzuki N, Hatakeyama H — The reactivity between rickettsiae and Weil-Felix test antigens against sera of rickettsial disease patients. Acta Virol 1992; 36: 67-72.
14Kala D, Gupta S, Nagraik R, Verma V, Thakur A, Kaushal A — Diagnosis of scrub Typhus: recent advancements and challenges. Biotech 2020; 10(9): 396. Published online 2020 Aug.
15El Sayed I, Liu Q, Wee I, Hine P — Antibiotics for treating scrub Typhus. Cochrane Database Syst Rev 2018; 9: CD002150.
16Phimda K, Hoontrakul S, Suttinont C — Doxycycline versus azithromycin for treatment of leptospirosis and scrub Typhus. Antimicrob Agents Chemother 2007; 51: 3259-63.
17Mahajan A, Jasrotia DS, Charak RS, Kumar T, Bhagat PL, Sharma N, et al — Scrub Typhus: Jammu outbreak-2009. JK Science 2010; 12: 98-101.
18Adhikari S, Poudel RS, Shrestha S, Lamichhane P — Predictors of mortality in scrub Typhus infection requiring intensive care admission in Tertiary Healthcare Centre of Nepal. Interdiscip Perspect Infect Dis 2018; 2018: 4867958.
Xavier Ryon Washington Ramesh1, C Edwin Emperor2, Oxy T S Dharsini3
Background : Pan Facial Fractures to the facial region are common in Road Traffic Accidents. The association of fractures extending into the surrounding structures (Skull) should not be neglected. Duty Medical Officers should be aware of the life-saving initial management and stabilization of the patient in Pan Facial Fractures.
Case Report : We report here an interesting case of Pan Facial Fracture and its management and outcome.
Conclusion : Duty Medical Officers should be aware of Pan Facial Fractures. Increasing incidence of High- velocity injuries in Road Traffic Accidents causes a higher rate of Pan facial injuries in association with head injuries. Early reconstruction with the precision of facial bones injury and fractures with buttresses provides good results anatomically, surgically, functionally and cosmetically. With the establishment of advanced trauma care in all institutions in one state, it’s mandatory to know about Pan Facial Fractures and their management.
[J Indian Med Assoc 2024; 122(9): 66-70]
Key words :Pan Facial Fracture, Road Traffic Accidents, Buttresses, Open Reduction and Internal Fixation.
Global status report on Road Safety (2015) states that 15-20 million injuries and more than 1.25 million deaths occur in Road Traffic Accidents (RTA)1. In India according to the Ministry of Road Transport and Highways (2019) the total number of accidents was 4,49,002, of which 4,51,361 injuries and 1,51,113 deaths were reported2. Drunken drive and high speed have been shown to increase RTA. Social factors ie, interpersonal violence is also a cause of Pan facial injuries. Pan Facial Fractures are fractures involving the upper third, middle third and lower third of the face 3. Fractures of the frontal bone, maxilla, zygomatic complex, Naso-ethmoid Orbital (NEO) region are more common4. Bony buttresses - Vertical and Horizontal, define the vertical height, width of the face and provide the bony support required for mastication5. We share our experience in managing an interesting case of Pan Facial Fracture.
53-year-old male came with an alleged history of RTA. The patient had sustained a head injury along with injuries to the face, right hand and left forearm referred from a private hospital.
Examinations — Patient conscious, oriented, Blood Pressure-120/80 Mmhg, Pulse-70/Min, Saturation- 97% after stabilization, Patient had left subconjunctival hemorrhage, B/L cheek swelling with tenderness, b/l maxillary, frontal, ethmoid sinus tenderness present. He had multiple abrasions over the chin, sutured wound over the right 2nd finger, abrasions over the left forearm.
Department of Plastic and Reconstructive Surgery, Kanyakumari Government Medical College and Hospital, Nagercoil, Tamil Nadu 629201
1MBBS, Medical Officer
2MCH, MS, DLO, Professor and Head
3MCH, MS, Assistant Professor and Corresponding Author
Received on : 31/03/2022
Accepted on : 07/04/2022
Editor's Comment :
Early primary stabilization should be done in the golden hour which is life-saving and provides a better outcome for the patient.
Initial management was based on the Algorithmic protocol of Advanced Trauma Life Support (ATLS)6. This patient (Fig 13 - pre-operative picture) belongs to pan facial fractures and was managed under anesthesia with implants (miniplate, compression plate) 7,8 . CT scan Brain-plain showed the normal study. CT scan findings showing multiple Pan Facial Fractures along with Temporo-mandibular Joint (TMJ) dislocation are listed in Table 1, CT scan 3dimensional images showing multiple fractures are shown in Figs 1,2. CT scan showing b/l TMJ dislocation (Figs 3a & 3b), Fractures of the mandible (Fig 4), Maxilla (Fig 5), Nasal Bone (Fig 6), Hard palate (Fig 7), Orbit (Fig 8).
Procedure Under Anaesthesia, the patient was placed in the supine position, parts painted and draped, eyelet wiring/IMF done. Through the extraoral approach, fracture site left parasymphysis mandible exposed, reduction done and fixed wiring was done with 5-hole plate and 4-hole plate with screws. Through Intra Oral approach fracture maxilla exposed in the gingiva-alveolar sulcus, a reduction is done and fixed with a 3-hole plate with screws, open reduction and internal fixation was done to the hard palate and closed (Fig 12). Through the Infra Orbital approach, Blowout orbital fracture was exposed on both sides, herniated contents (Fig 9) reduced and floor of orbit repair was done with prolene mesh (Fig 10).
Fracture right orbit wall fixed with 2hole plate with screws. IMF in situ. No CSF Rhinorrhea was seen, frontal sinus fracture was managed conservatively. Comminuted nasal bone fractures closed reduction done. Complete hemostasis obtained, wound closed in layers. The list of Pan Facial Fractures and their management are in Table 2.
Postoperatively the patient (Fig 14) was treated with Intravenous (IV) fluids, IV antibiotics, IV antiemetics,
122, No 09, September 2024Journal
Table 1 — CT scan plain (axial) findings showing multiple Pan Facial Fractures are listed below
BoneType of FracturesNo of Fractures
MANDIBLEComminuted displaced fracture1 noted at the left Para symphysis Menti with B/L TM Joint dislocation
MAXILLAComminuted fractures are seen6 in anterior, medial, posterolateral walls of the B/L maxillary sinus.
SPHENOIDComminuted fractures seen4 on B/L medial and lateral pterygoid plates
HARD PALATELinear displaced fracture seen1 in left paramedian hard palate extending into the alveolar process of the anterior maxilla
NASAL BONESComminuted fractures are4 seen in B/L Nasal bones and nasal septum
BONY ORBITBlow out fracture seen in the6 floor of both orbits with herniation of orbitalfat into B/L maxillary sinus. Comminuted fracture at the medial and superior wall of both orbit and lateral wall of the left orbit.
ZYGOMATIC BONEFracture is seen in the left1 zygomatic arch
FRONTAL BONEComminuted displaced fractures2 are seen in anterior and posterior walls of the frontal sinus
NASO-ETHMOIDComminuted displaced fractures3 are seen in the roof of the ethmoid and B/L fovea ethmoidalis
TOTAL28
analgesic, antihistamines, anti-inflammatory drugs. Supportive care was given. The patient was doing well and was discharged in a good condition at the time of discharge.
Fracture classification14. In 1998 Hendrickson classified palatal fractures15
Pan facial fractures are the combination of fractures

Fig 1 — 3-dimensional CT scan frontal view showing pan facial fractures of Mandible(a), Maxilla(b), Sphenoid, Hard Palate, Nasal Bone(c), Bony Orbit(d), Zygomatic Bone(e), Frontal Bone(f), Naso-ethmoid Bone

Fig 2 — 3-dimensional CT scan
Oblique view showing pan facial fractures of Mandible, Maxilla, Sphenoid, Hard Palate, Nasal Bone, Bony Orbit, Zygomatic Bone, Frontal Bone, Nasoethmoid Bone



scan


mainly involving the upper third, middle third, and lower third of the face3. Initial management was done according to the algorithmic protocol of Advanced Trauma Life Support (ATLS)6
FractureManagement
Orbital floor B/LOpen Reduction and Internal Fixation, Herniated contents reduced and prolene mesh placed in situ. MaxillaOpen Reduction and Internal Fixation (ORIF).
MandibleOpen Reduction and Internal Fixation. Zygomatic boneOpen Reduction and Internal Fixation. Nasal boneClosed reduction. Naso-EthmoidReconstruction. FrontalConservative. SphenoidConservative.
Hard palateOpen Reduction and Internal Fixation, Palatal repair was done.




At first, French Surgeon Rene Le Fort (1901) described Standard fracture patterns classically as Le Forte 1,2,3 and the lines of weakness in the midface9. Later Cryer in 1916 made descriptions of buttresses10. Vertical pillars and horizontal buttresses Illustrations were also made 11 Palatine and maxillary fractures are important for the structural stability of the midface which was described by

Table 3 — Horizontal and vertical buttresses of face19
Vertical buttressesHorizontal buttresses
Nasomaxillary (red)Frontal (orange)
Zygomaticomaxillary (purple)Zygomatic (orange)
PterygomaxillaryMaxillary (blue)
Condyle and posterior mandible (pink)Mandibular (green)
Epsteen and Dingman 12 . The importance of this relationship to the cranial base was finalized by Ferret, et al In 1993 Marciani modified Lefort’s13
Buttress — Buttresses are the regions of thick bones that neutralize the forces applied to them16. The proper outcome of maxillofacial reconstruction in terms of restoration of facial height, width and projection in addition to restoring the occlusion depends upon the proper reduction of buttresses 17,18 . Vertical and horizontal buttresses should be established and fixed before the orbital wall and rim correction18. The vertical and horizontal buttresses of the face are shown in Table 3 correlates with Fig 11 showing markings of facial skeleton buttresses19,20


122, No 09, September 2024Journal
Sequencing — There are two approaches for sequencing, (1) Bottom to Top or Inside out. (2) Top to Bottom or Outside in21,22
In this case, we have done the bottom to top approach with reduction and rigid fixation using occlusion as a guide. Dental Occlusion was maintained by Intermaxillary Fixation (IMF) and eyelet wiring 23. The fracture mandible was repaired first which was used as a guide for the establishment of height, width and projection of the lower face. The mandible was exposed through an extraoral approach that will facilitate the repair and minimize the risk of intraoral dehiscence. Mandibular buttresses along the left para symphysis menti are fixed with a 5-hole plate and 4-hole plate with screws made up of Titanium 8 Temporo Mandibular joint was reduced along the condyle and posterior mandibular vertical buttresses. Through intraoral approach maxilla was exposed in the region of gingiva alveolar sulcus along the maxillary horizontal buttresses, the hard palate fracture which is linearly displaced in the left paramedian region extending into the anterior maxilla is reduced, approximated, and restored providing a Le Fort 1 level fixation with 3-hole plate with screws and palatal repair was completed. Our goal of fixing the mandibular maxillary unit as a single block to articulate with the skull base to restore the spatial relationship between them was achieved and proper occlusion was restored24. In mid-face thicker bone for fixation is seen in the lateral and medial zygomatic maxillary buttress, whereas the central area over the maxillary sinus in the zygomatic horizontal buttress is thin and tends to fracture usually, so screw fixation is not done routinely in the central region 25 . Through infraorbital approach along the zygomaticomaxillary vertical buttress and zygomatic horizontal buttress blow out orbital fracture exposed on both sides, herniated contents are reduced, orbital floor repair completed with prolene mesh. Midface height, width, and projection was restored. Frontal Bone Fracture and sphenoid bone fracture was managed conservatively. The postoperative period was uneventful and the patient was discharged in a good condition.
Complications — Usually in Pan Facial Fractures we may expect, Immediate-Bleeding, CSF Rhinorrhoea or Otorrhea, Intermediate-Infection, Foreign body reaction.
Late-Palatal fistula, Telecanthus, Enophthalmos, malunion, Nonunion, Wound dehiscence.
In our case there was minimal bleed, no CSF rhinorrhea and no signs of infections were seen.
Points to be Noted :
(1)Pan Facial Fractures are usually associated with a head injury and the patient may need ventilator support.
(2)Documentation of injury details is needed for medicolegal reasons.
(3)Explanation about the outcomes of surgery to the patient’s relatives.
(4)Patient’s photograph prior to injury acts as a guide for the surgeon in treatment goals. A preoperative and postoperative photograph is a good practice for documentation and comparison.
(5)Before orbital walls and rim correction vertical and horizontal buttresses are established and fixed.
(6)In fractures involving Fronto nasal orbital ethmoid region (FNOE) attention is to be paid to soft tissue repair. Delayed and inadequate FNOE complex fractures treatment leads to complications.
(7)For proper occlusion mandibular and maxillary fixation is mandatory.
(8)In fractures involving Orbital walls forced duction test is necessary before and during surgery.
(9)Look for prolapse of orbital floor contents, CSF rhinorrhea, Facial nerve paralysis, Trigeminal nerve Injury, Infraorbital paraesthesia, neurological complications, different modalities of management.
Early primary intensive care and stabilization should be done in the golden hour which is life-saving and provides a better outcome for the patient. Duty medical officers should be aware of airway compromise, Nasal bleed, Alveolar bleed, Tongue injury, Head injuries, Cervical spine injuries associated with Pan Facial Fractures. Sequencing of the Pan Facial Fracture management depends more on the clinical situation than predefined algorithms, as in Pan Facial Fractures there will be different clinical presentations. Alignment of buttresses is very important to provide a 3 dimensional functional and cosmetic correction for the patient.
Conflict of Interest : None
1Gadre KS — Incidence and pattern of cranio-maxillofacial injuries: a 22-year retrospective analysis of cases operated at major trauma hospitals/centers in Pune, India. J Maxillofac Oral Surg 2013; 12(4): 372-8.CrossRefGoogle Scholar
2Census Available From:https://morth.nic.in/sites/default/files/ Annual%20Report_21-22- 1.pdf. Hosted by National Informatics Centre (NIC)
3Shahrokh C Bagheri, Martin B. Steed, Chris Jo Martin B — 2014, Craniomaxillarfacial Trauma Surgery, From Plastic Surgery Secret Plus (Second Edition), 2010. 223
4Kim J, Choi JH, Chung YK, Kim SW — Panfacial Bone Fracture & Medial To Lateral Approach, 2016; 17(4): 181-5.
5Gerry Funk Dr, 2017, Facial Fracture Management Handbook, University Of Iowa
6Larry H, Hollier JR, Kelley P, Koshy JC — 2014, Soft – Tissue And Skeletal Injuries Of The Face, Charles M. Thorne ed. Grabb And Smith’s Plastic Surgery (Seventh Edition), Phila-
Vol 122, No 09, September 2024Journal of the Indian Medical Association
delphia, PA 19103 USA By Lippincott Williams & Wilkins, a Wolters Kluwer Business. 311-12.
7Edwards TJC, David DJ, Simpson DA, Abbott AH — The relationship between fracture severity and complication rate in miniplate osteosynthesis of mandibular fractures. Br J Plast Surg 1994; 47: 210-1.
8Tuovinen V, Norholt SE, Pedersen SS, Jensen J — A retrospective analysis of 279 patients with isolated mandible fractures treated with titanium miniplates. J Oral Maxillofac Surg 1994; 52: 931-5.
9Patterson R— The Le Fort fractures: René Le Fort and his work in anatomical pathology. Can J Surg 1991; 34(2): 183-4. [PubMed] [Google Scholar]
10Cryer MH — The maxillae In: The internal anatomy of the face Philadelphia, PA: Lea and Febiger; 19: 1676-77. [Google Scholar]
11Gruss JS, Mackinnon SE — Complex maxillary fractures: role of buttress reconstruction and immediate bone grafts. Plast Reconstr Surg 1986; 78(1): 9-22. [PubMed] [Google Scholar]
12Epsteen CM, Dingman RO — Maxillofacial surgery. Am J Surg 1952; 83(5): 613-4. [PubMed] [Google Scholar]
13Ferre JC, Chevalier C, Barbin JY — Réflexions sur la biomécanique de la base du cräne et de la face [The biomechanics of the base of the skull and face] Rev Stomatol Chir Maxillofac 1990; 91(1): 1-8. [PubMed] [Google Scholar]
14Marciani RD — Management of midface fractures: ffty years later. J Oral Maxillofac Surg 1993; 51(9): 960-8. Review
15Hendrickson M, Clark N, Manson PN, Yaremchuk M, Robertson B, Slezak S, et al — Palatal fractures: classification, patterns, and treatment with rigid internal fixation. Plast Reconstr Surg 1998; 101(2): 319-32.
16Gadre KS, Kumar B, Gadre DP — Panfacial Fractures. 2021. Oral And Maxillofacial Surgery For The Clinician, Gateway
East, Singapore: 189721, Springer Nature Singapore Pte Ltd, 1289 ( 60.7.1)
17Manson PN, Hoopes JE, Su CT — Structural pillars of the facial skeleton: an approach to the management of Le Fort fractures. Plast Reconstr Surg 1980; 66: 54-62.
18Manson PN, Clark N, Robertson B, Slezak S, Wheatly M, Vander Kolk C, Iliff N — Subunit principles in midface fractures: the importance of sagittal buttresses,soft-tissue reductions, and sequencing treatment of segmental fractures. Plast Reconstr Surg 1999; 103(4): 1287-306.
19Gadre KS, Kumar B, Gadre DP —, 2021, Oral And Maxillofacial Surgery For The Clinician, 1290 (Table 60.2)
20Diagram Available From:https://media.springernature.com/ original/springer-static/image/chp%3A10.1007%2F978-98115-1346- 6_60/MediaObjects/462947_1_En_60_Fig9_HTML.jpg
21Curtis W, Horswell BB — Panfacial fractures: an approach to management. Oral Maxillofac Surg Clin North Am 2013; 25(4): 649-60.
22Yang R, Zhang C, Liu Y, Li Z, Li Z — Why should we start from mandibular fractures in the treatment of panfacial fractures? J Oral Maxillofac Surg 2012; 70(6): 1386-92.
23Cornelius CP, Ehrenfeld M — The use of MMF screws: surgical technique, indications, contraindications, and common problems in review of the literature. Craniomaxillofac Trauma Reconstr 2010; 3: 55-80.
24Imazawa T, Komuro Y, Inoue M, Yanai A — Mandibular fractures treated with maxillomandibular fixation screws (MMFS method) J Craniofac Surg 2006; 17(3): 544-9. [PubMed] [Google Scholar]
25Kausar A, Lettieri SC — Management of Panfacial Fracture. Seminars in plastic surgery 2017; 31(2): 108-17. doi:10.1055/ s-0037-1601579
Deepak Golwalkar1, Jwalant Pandya2
SARS-CoV-2 infection leads to multi-system involvement with brunt of the damage primarily borne by the lungs. SARS-CoV-2 viral pneumonitis manifests itself in the form of diffused lung infiltration and interstitial pneumonitis. Resultant alveolar oxygenation impairment leads to drop in SpO2 and breathlessness. Radiologically it manifests in the form of ground glass opacities in both lung fields. These radiological findings & residual lung infiltrations usually take months to clear. However, administration of Methylene Blue (MB) in Nebulised form given to the convalescent patient dramatically hastens the clinical outcome with demonstrable clearance of radiological lesion. This paper present a a case report of Post SARS-Cov-2 convalescent, Type II DM patient with extensive bilateral residual lung involvement in the form of broncho pneumonic changes in both mid and lower zones treated with MB nebulization along with steroids and antibiotics, improved dramatically within 6 weeks of institution of MB nebulization with sequential clearance of lung infiltration documented by radiographs. [J Indian Med Assoc 2024; 122(9): 71-2]
Key words :Fibrosis, COVID-19, Methylene Blue.
SARS-CoV-2 infection leads to multi-system involvement with brunt of the damage primarily borne by the lungs. SARS-CoV-2 viral pneumonitis manifests itself in the form of diffused lung infiltration and interstitial pneumonitis. Resultant alveolar oxygenation impairment leads to drop in SpO2 and breathlessness. Radiologically it manifests in the form of ground glass opacities in both lung fields. These radiological findings & residual lung infiltrations usually take months to clear.
However, administration of Methylene Blue (MB) in Nebulised form given to the convalescent patient dramatically hastens the clinical outcome with demonstrable clearance of radiological lesion. MB in nebulised form is being used by us, now for a considerable period of time as an adjunct to conventional chemotherapeutic agents in treatment of SARS-CoV-2 patients with considerable success. Here is a case report of Post SARS-Cov-2 convalescent, Type II DM patient with extensive bilateral residual lung involvement in the form of broncho pneumonic changes in both mid and lower zones treated with MB nebulization along with steroids and antibiotics, improved dramatically within 6 weeks of institution of MB nebulization with sequential clearance of lung infiltration documented by radiographs.
A 54-year-old male patient with Type-2 DM, got admitted at Sir T Hospital, Bhavnagar with complaints of fever, fatigue, dry cough and breathlessness on 1 st September, 2020 and was found COVID-19 positive the next day. He was admitted in government Covid facility & treated for COVID-19 positive bilateral lower respiratory tract pneumonitis & infiltration in both lung fields at
Department of Pulmonary, Dr Deepak Golwalkar Clinic, Bhavnagar, Gujarat 364002
1MBBS, DTCD, FCCP, Consultant Pulmonologist and Corresponding Author
2MD, Pathology, Senior Consultant
Received on : 21/07/2021
Accepted on : 09/02/2022
Editor's Comment :
Methylene blue nebulization therapy in Post COVID-19 pneumonitis promotes early resolution of interstitial inflammation and prevents ensuing pulmonary interstital fibrosis with near complete clearance of lesion on radiography.
Our endeavor here, through this case report is to highlight & emphasize the role of Methylene Blue (MB) as an adjunct to conventional treatment in COVID-19 lung injury mitigation and speedy resolution of lung pathology.
government run Covid hospital. He was treated with fullfledged anti-Covid therapy including Remdesivir, LMWH, Steroids and antibiotics and vitamin supplements and discharged on 15th September, 2020.
Patient was brought in our OPD on 28th September, 2020 with complaints of weakness, fatigue, coughing and breathlessness on exertion. His chest radiograph on the same day revealed bilateral lung infiltration with bronchopneumonic changes in mid & lower zones (Fig 1). His blood pressure & diabetes was under good control with medication. Patient’s basal SpO2 was 95 which dropped to 85 after 20 meters walk on first consultation. Patient’s informed consent was obtained before proceeding with further line of treatment.
Patient was put on following regimen :
Tablet Ivermectin 12mg, ODx4d ; Tablet Prednisolone 5mg TD Sx 10days + Tablet Deryphylline Retard 150mg BD x 10days + Azithromycin 500 mg x 5days + days + Acetyl Cystein OD x 7days, Sublingual Methylene Blue (MB) solution, 0.1% 2.5 ml daily till completion of treatment and daily nebulization inhalation therapy. Nebulization fluid consisted of Dexamethasone 8mg + Levasalbutamol 1.25mg + Ipratropium 500 mcg + Methylene Blue (MB) 5ml 0.1% daily for 10 days.
After 10 days of above therapy Patient was reviewed on 8th October, 2020. There was marked symptomatic, clinical & radiological improvement. There was general feeling of well-being. Fig 2 showing radiological
Vol 122, No 09, September 2024Journal
improvement in the form of decreased pneumonitis. After 20 meters walk patient’s SpO2 dropped to 92 as compared to 85 on first visit.
Subsequently, patient was put on: Tablet Cephadroxyl 500 mg BD X 5 days + Tablet Prednisolone 5mg OD x 15days + Tablet Deriphylline 150mg BD x 15 days + Sublingual MB (0.1%) 2.5 ml OD & Nebulized inhalation therapy with Dexamethasone & MB(0.1%) 5ml & Levasabutamol Ipratropium
After 15 days on above treatment regimen, there was marked subjective, symptomatic & clinical improvement. SpO2 remained at 95 even after 20 meter walk. Chest Xray on 5 th November, 2020 revealed appreciable improvement with markedly reduced infiltration pneumonitis. Chest radiographs taken sequentially show regression & clearance of pulmonary infiltration and interstitial pneumonitis with complete resolution in chest radiograph taken on 3rd December, 2020. Patient’s chest scan obtained on 04/12/2020, also revealed considerable reduction of lesion with 10% residual infiltration. Patient was able to complete 6-minute walk test with no drop in Spo2, reflecting near complete resolution of underlying pathology (Figs 3&4).
Methylene Blue, an inert dye used in medical practice since time immemorial, has various applications such dermatological, IV administration in methemoglobinemia, sinus tract demarcation during surgical procedures and as in various diagnostic procedures eg, diagnosis of Broncho Pleural Fistula, Vesicovaginal fistula, etc.
Methylene Blue (MB) was the first synthetic antiseptic dye to be used therapeutically. In fact, its use was widespread before the advent of sulfonamides and penicillin. As early as 1933, NEJM cited the use of methylene blue in treatment of urinary tuberculosis. Its safety and inertness in human species has been proved by its extensive use in surgical procedures, IV administration in refractory septic shock6 where MB had an acute vasopressor effect in patient with hypotension not responding to other medications.
There are Several Mechanisms of Actions Postulated for the Effectiveness of Methylene Blue (MB) :
•MB prevents platelet activation, adhesion and aggregation through inhibiting the arachidonic acid metabolism in platelets. This helps in reducing interstitial pneumonitis in post COVID-19 patients
•It has been documented that MB has a direct inhibitory effect on Nitric Oxide Synthatase (NOS)3. MB being a potent NO synthatase inhibitor, neutralizes the bradykinin mediated pro-inflammatory cascades and prevents cytokine storm. Bradykinin mediates most of its pro-inflammatory effects through NO generation. MB blocks/hinders NO generation and decreases tissue injury and inflammation3
•Antibacterial properties of MB4
CONCLUSION
Our endeavor here, through this case report is to highlight & emphasize the role of Methylene Blue (MB) as an adjunct to conventional treatment in COVID-19 lung injury mitigation and speedy resolution of lung pathology. MB, when given by sublingual and inhalation (Nebulization) routes:
•MB also prevents platelet activation and adhesion/ aggregation promoting fibrinolysis5 and clearance of

Fig 1 — Bilateral Lung Infiltration & Pneumonitis (dated 28-09-2020)

Fig 3 — Appriciable Resolution (dated 5-11-2020)

Fig 2 — Partial Resolution (dated 8-10-2020)

Fig 4 — Complete Resolution (dated 3-12-2020)
inflammatory infiltration. This was reflected here in this case study by subjective and clinical improvement as well objective clearance of radiological lesion.
•Reduces tissue injury by blocking pro-inflammatory mediators1 and
•Improves O2 availability at cellular level by facilitating oxygen release2
We have observed gratifying results by instituting Methylene Blue inhalation & sublingual application in these COVID-19 patients with advanced lung injury who recovered rapidly and satisfactorily.
More research is needed in understanding the mechanism of action of Methylene Blue in curing interstitial pulmonary pneumonitis.
Remark : Informed written consent of the Patient was obtained in advance for this case study.
Conflict of Interest : The Authors declare that research was conducted in absence of any commercial or financial relationships that could be construed as a potential conflict of interest.
1Damir Bojadzic, Oscar Alcazar & Peter Buchwald.: Methylene Blue Inhibits In vitro SARS-CoV-2-ACE2 protein-protein Interaction-A mechanism that can contribute to its Antiviral action.
2Seyyed Mommad Ghahestani et al, : MB may have a role in treatment of COVID-19; Medical Hypotheses : 2020
3Alamdari DH, Moghaddam AB — Application of Methylene blue-Vitanin C- N-acetyl cysteine for treatment of critically ill COVID-19 patients, report of a phase-I clinical trial. European Journal of Pharmacology; 885(2020)
4Ansari MA, Fatima Z — Anti-Fungal Action of MB involves Mitochondrial dysfunction and Disruption of Redox & Homeostasis. The Open Microbiology Journal 2016; 10: 12-22.
5Bozoy, Dimitri, Axelband — Utilization of Methylene blue in the setting of hypotension associated with concurrent renal & hepatic failure: a concise review. OPUS 12 Scientist 2008; 21-9.
6Preiser, Jean-Charles, Lejeune — Methylene blue administration in septic shock; A clinical trial, Critical Care Medicine 1995; 23: 259-64
7Schenk P, Madl C, Rezaie-Majd S, Lehr S, Muller C — Methylene blue improves the hepatopulmonary syndrome. Ann Intern Med 2000; 133: 701-6
8Zirlik S, Hildner KM, Neurath MF — Methylene Blue-Aided In Vitro Staining of Central Airways during Flexible Bronchoscopy. Scientific World Journal 2012; 2012: 625867.
Anish Desai1, Priyanka Das2, Sreeni Nair3, Siddhi Parab4
Background : Respiratory diseases constitute the leading cause of mortality globally. Lincomycin, a lincosamide antibiotic, has proven effective in treating respiratory infections. This study aims to evaluate the efficacy of 1000 mg of lincomycin once daily in the treatment of Upper Respiratory Tract Infections (URTIs).
Methods : The study was an open-label, prospective, interventional clinical study conducted on 40 patients who were diagnosed with URTIs and received oral lincomycin 1000 mg once daily for five days.
Results : The results showed that lincomycin significantly reduced the mean symptom scores for headache, throat pain, odynophagia (difficulty swallowing), and sinus tenderness. Additionally, the mean scores for nasal and tonsillar congestion were completely reduced post-lincomycin treatment (p<0.05). Lincomycin also shown to be safe and tolerated by all patients.
Conclusion : In this clinical study, 1000mg of lincomycin once daily has been shown to be effective and safe in treating URTI.
Key words :Upper Respiratory Tract Infections (URTIs), Lincomycin.
Respiratory Tract Infections (RTIs) are one of the top ten reasons for patient visits to Primary Health Care (PHC). Infections of the respiratory tract cause 9-28% of appointments and are the most frequent among acute illnesses. In India, Upper Respiratory Tract Infections (URTIs) are among the most frequently diagnosed conditions in PHCs. These infections encompass a range of ailments, including rhinosinusitis, Acute Otitis Media (AOM), pharyngotonsillitis and laryngitis1
Respiratory diseases constitute the leading cause of mortality in China and globally, impacting over one billion individuals worldwide. Among children aged 018 years, URTI accounts for 81% of emergency room hospital visits for respiratory issues. Li YR, et al conducted a cross-sectional study on morbidity in Hong Kong, revealing that 26.4% of hospital outpatient cases were linked to URTI2. As one of the prevalent diseases, the global burden of URTI was estimated to be 17.2 billion in 20193
1MD, FCP, PGDHEP, Director, Medical Affairs, Intellimed Healthcare Solutions, Mumbai 400071
2PhD Molecular Biology, Deputy General Manager - Medical Writing, Intellimed Healthcare Solutions, Mumbai 400071
3Doctor of Pharmacy, Assistant Manager - Medical Affairs, Intellimed Healthcare Solutions, Mumbai 400071
4M Pharm (Pharmacology) Executive - Medical Affairs, Intellimed Healthcare Solutions, Mumbai 400071
Received on : 06/09/2024
Accepted on : 10/09/2024
[J Indian Med Assoc 2024; 122(9): 73-6]
According to the 2019-2020 National Family Health Survey, Maharashtra recorded 2.4% and 3.8% prevalence of Acute Respiratory Infections (ARIs)in urban and rural areas that would ensue in the following 2 weeks. In the Indian slum areas, ARI constitutes more than two-thirds of all childhood illnesses 4 However, diverse microbial agents target different viruses and bacteria that are implicated in URTIs. This broad category of infections contributes to the development of diseases in patients, such as acute bronchitis, common cold, influenza and respiratory distress syndromes. Defining most of these patient diseases is challenging because the symptoms associated with URTIs often overlap and their causes are similar5.
Due to the diverse pathogenic mechanisms triggered by numerous virus types, no universally effective treatment is currently available for URTIs. Despite their widespread use in treating uncomplicated viral URTIs, antibiotics are ineffective against viruses.
Lincomycin is a lincosamide antibiotic derived as a natural fermentation product from Streptomyces lincolnensis7. It received approval from the Food and Drug Administration on December 29, 1964. Lincomycin has proven effective in treating acute URTIs and ear, nose, and throat infections, such as tonsillitis, pharyngitis, sinusitis and AOM, along with pneumococcal pneumonia and paediatric
122, No 09, September 2024Journal
streptococcal infections. In the context of RTIs, lincomycin can be a valuable choice when there is awareness of local susceptibility trends and epidemiology and when culture data is accessible.8 This antibiotic exhibits activity against Gram-positive cocci, bacilli, Gram-negative cocci, and certain other microorganisms, including Haemophilus species. It inhibits bacterial protein synthesis by binding to the 23S RNA of the 50S subunit of the bacterial ribosome. Lincomycin has demonstrated activity against the majority of bacterial strains9
The increased frequency of antibiotic usage in URTIs is a global issue, consistently ranking high among the conditions associated with antibiotic prescriptions. According to the current review of literature, before prescribing an antibiotic for these infections, a precise diagnosis must precede; such diagnosis shall establish its bacterial origin to prevent the null clinical utility of the drug and the potential risk of increasing bacterial resistance. Suttajit S, et al explored the patterns and evaluated the appropriateness and predictors of antibiotic prescriptions for bacterial and viral URTIs. The study showed that irrespective of the diagnosis, amoxicillin, macrolides and lincomycin injections were most frequently prescribed for bacterial infections versus those for viral infections6. With the help of a drug prescription database, a retrospective observational study showed that lincomycin was in the list of top 25 antibiotics that were frequently prescribed in children under 16 years of age with URTIs at private ambulatory healthcare practices10
Lincomycin has a relatively narrow activity spectrum, which primarily targets specific bacteria. Avoiding broad-spectrum antibiotics that could contribute to further antibiotic resistance can be advantageous 11 . Lincomycin can substitute for patients with penicillin allergies who need treatment for bacterial URTIs caused by susceptible organisms 12 . Despite numerous clinical and microbiological studies assessing the efficacy of lincomycin in common infections encountered in clinical settings, the existing evidence has not been extensively reviewed or propagated over the past few decades.8 The objective of this study was to evaluate the efficacy of oral lincomycin for treating URTI.
MATERIALS AND METHODS
This is an open-label, prospective, interventional clinical study that evaluated the efficacy of lincomycin 1000 mg once daily in the treatment of URTI. A total of 40 patients were included in the study.
A total of 40 patients were included in the study, including 28 (70%) male and 12 (30%) female patients, respectively. The mean age of the male and female patients was 42.68 and 41.42 years respectively. All patients received oral lincomycin 1000 mg once daily until day 5. The different co-morbidities of the patients are mentioned in Table 1. Patients diagnosed with tonsillitis contributed to the highest percentage of the population.
Table 1 — Demographic details of patients Co-morbidity wise distribution :
Effectiveness of Oral Lincomycin :
Oral lincomycin 1000mg once daily for 5 days significantly reduced the mean symptom scores for headache (p<0.05), throat pain (p<0.05), odynophagia (p<0.05) and sinus tenderness (p<0.05). Further, the mean scores for nasal (p<0.05) and tonsillar congestion (p<0.05) formation were completely reduced post-lincomycin treatment (Fig 1).
Safety :
Lincomycin was shown to be safe and tolerated by all patients. Readmission was not observed in any patients and no adverse events such as diarrhoea, CDI or anaphylaxis were reported.
In this study, there was a significant reduction in the mean scores for various symptoms that included headache, throat pain, odynophagia (difficult swallowing) and sinus tenderness. Mean scores for manifestations such as nasal congestion and tonsillar congestion were completely reduced after the lincomycin treatment, indicating a reduction in infection and overall improvement in the patient’s condition. These findings demonstrate the efficacy of oral lincomycin 1000mg in treating URTI.
The effectiveness of lincomycin has been established in previous studies. A clinical study by






Breese BB, et al reported that 100 patients (paediatric) with haemolytic streptococcal infection were randomly administered with ampicillin, penicillin and lincomycin. All three drugs were given orally for ten days: lincomycin and ampicillin in capsule form and potassium penicillin G in pill form. The ampicillin and potassium penicillin G dosage was approximately 5
to 10 mg per pound of body weight (10 to 20 mg per kilogram); lincomycin was just twice as large. The study demonstrated that approximately 82% of patients showed improvement with lincomycin. Within three weeks of therapy, failure rates were 12.0% for lincomycin, 17.8% for ampicillin and 25.4% for penicillin, with the penicillin-lincomycin difference
Vol 122, No 09, September 2024Journal
(13.4%) being significant (p <0.02). Randomly selected groups and consistent failure criteria ensure therapy effectiveness differences are shown by failure rate differences, including recurrences and carriers. The study concluded that ampicillin and lincomycin might be added to the list of drugs effective against haemolytic streptococcal disease13
In another Indian study involving 40 adult patients diagnosed with tonsillitis or sinusitis, the efficacy of oral lincomycin at a dose of 500mg and cefpodoxime at 200mg, administered twice daily for a duration of 5 days, was investigated. Following the study period, all participants underwent re-evaluation and their response rates were examined. The prevalent clinical symptoms included body temperature, headache, throat pain, postnasal discharge, mucopus, odynophagia (difficult swallowing), sinus tenderness, nasal congestion, pharyngeal congestion and tonsillar congestion. Overall, lincomycin hydrochloride demonstrated higher efficacy in alleviating all symptoms, except for headache, versus cefpodoxime proxetil. Out of a total of 100% patients in each group, 67.89% of those treated with lincomycin and 52.27% of those treated with cefpodoxime experienced complete relief across all clinical symptoms14. In our study, administration of lincomycin 1000mg once daily also significantly reduced the clinical manifestations of URTI presented by the patients.
However, this present study has limitations, such as a restricted assessment period of 5 days to evaluate the efficacy of lincomycin. The short duration may not fully capture potential long-term effects or complications associated with prolonged use. Hence, it is recommended that future research should engage in comparative studies involving other antibiotics and the inclusion of extended follow-up studies becomes crucial for a thorough assessment of safety considerations.
In this clinical study, lincomycin 1000 mg once daily has been shown to be effective in treating URTI.
Declaration : Article is not published / submitted in any other journal.
Acknowledgments : The authors thank all the study investigators, study coordinators and other study personnel who participated in the study, for their contributions.
Conflict of Interest : No
Fundings : The study and publication were financially supported by Wallace Pharmaceuticals Pvt Ltd.
1Ferrara P, Cutrona C, Sbordone A — Which treatment for upper respiratory tract infections? Ital J Pediatr 2015; 41(Suppl 2): A31. doi:10.1186/1824-7288-41-S2-A31
2Li YR, Xiao CC, Li J — Association between air pollution and upper respiratory tract infection in hospital outpatients aged 0–14 years in Hefei, China: a time series study. Public Health 2018; 156: 92-100. doi:10.1016/j.puhe.2017.12.006
3Lim JT, Tan KB, Abisheganaden J, Dickens BL — Forecasting upper respiratory tract infection burden using high-dimensional time series data and forecast combinations. PLOS Computational Biology 2023; 19(2): e1010892. doi:10.1371/ journal.pcbi.1010892
4Murarkar S, Gothankar J, Doke P — Prevalence of the Acute Respiratory Infections and Associated Factors in the Rural Areas and Urban Slum Areas of Western Maharashtra, India: A Community-Based Cross-Sectional Study. Front Public Health 2021; 9: 723807. doi:10.3389/fpubh.2021.723807
5Thomas M, Bomar PA — Upper Respiratory Tract Infection. In: StatPearls. StatPearls Publishing; 2023. Accessed October 26, 2023. http://www.ncbi.nlm.nih.gov/books/NBK532961/
6Suttajit S, Wagner AK, Tantipidoke R, Ross-Degnan D, Sitthiamorn C. Patterns, Appropriateness, and Predictors of Antimicrobial Prescribing for Adults with Upper Respiratory Infections in Urban Slum Communities of Bangkok. Southeast Asian J Trop Med Public Health 2005; 36(2).
7Spí•ek J, Øezanka T — Lincosamides: Chemical structure, biosynthesis, mechanism of action, resistance, and applications. Biochemical Pharmacology 2017; 133: 20-8. doi:10.1016/j.bcp.2016.12.001
8Desai A, Narayanan V, Anand S — Lincomycin/ : A review and meta-analysis of its efficacy and tolerance in common infections encountered in clinical practice. Journal of the Indian Medical Association 2021; 119: 69.
9Baran A, Kwiatkowska A, Potocki L — Antibiotics and Bacterial Resistance—A Short Story of an Endless Arms Race. Int J Mol Sci 2023; 24(6): 5777. doi:10.3390/ijms24065777
10Peláez-Ballestas I, Hernández-Garduño A, Arredondo-García JL, Viramontes-Madrid JL, Aguilar-Chiu A — Use of antibiotics in upper respiratory infections on patients under 16 years old in private ambulatory medicine. Salud pública Méx 2003; 45(3): 159-64. doi:10.1590/S0036-36342003000300004
11Schwarz S, Shen J, Kadlec K — Lincosamides, Streptogramins, Phenicols, and Pleuromutilins: Mode of Action and Mechanisms of Resistance. Cold Spring Harb Perspect Med 2016; 6(11): a027037. doi:10.1101/ cshperspect.a027037
12Qiu W, Zhou Y, Li Z — Application of Antibiotics/Antimicrobial Agents on Dental Caries. Biomed Res Int 2020; 2020: 5658212. doi:10.1155/2020/5658212
13Breese BB — Beta-Hemolytic Streptococcal Illness: Comparison of Lincomycin, Ampicillin, and Potassium Penicillin G in Treatment. Am J Dis Child 1966; 112(1): 21. doi:10.1001/ archpedi.1966.02090100057004
14Kothadiya A — A multicentric, open label, randomised, postmarketing efficacy study comparing multidose of lincomycin hydrochloride capsule 500 mg with multidose cefpodoxime proxetil tablet 200 mg in patients with tonsillitis, sinusitis. J Indian Med Assoc 2012; 110(8): 580-3.
[The Editor is not responsible for the views expressed by the correspondents]
SIR, — Hepatitis is inflammation of liver by various infectious (hepatitis virus A, B, C, D and E) and non-infectious (alcohol) agents. Type A and E are responsible for acute infection and failure. Type B and C virus strains are responsible for chronic diseases like cirrhosis, cancer and even death. The various modes of transmission are stated in Fig 1.
Globally 354 million people are living with Hepatitis B or C infection1. In India, 40 million people are infected with hepatitis B chronically and 6-12 million people with hepatitis C2. Sustainable Developmental Goal (SDG) 3.3 “targets by 2030, to end the epidemics of AIDS, tuberculosis, malaria and neglected tropical diseases, and combat hepatitis, waterborne diseases and other communicable diseases to promote healthy lives and well-being for all.” The WHO global hepatitis strategy began in 2016 with an aim to achieve hepatitis elimination by 2030. Targets were set for the same which are reduction in the incidence of hepatitis infection cause by B & C virus to 90%, reduction in hepatitis related deaths by 65%, to ensure 90% diagnosis among people suffering from hepatitis B & C virus and at least 80% of those diagnosed receive appropriate treatment. To achieve the above targets the National Viral Hepatitis Control Program was launched in India on 28th July, 2018.
Every year 28th July is observed as World Hepatitis Day with an aim to create awareness about viral hepatitis and its effect on health. In the year 2022, WHO highlights to bring hepatitis care closer to primary health facilities and communities so as to improve access to treatment and care. As we all know that to achieve any target it is necessary to integrate multiple sectors and involve community participation. The comprehensive approach promotive, preventive and curative have always proven to be helpful. Under promotive measures creating awareness about the disease, symptoms, available treatment and prognosis can be done through print media, IEC (Information, Education and Communication) activities like nukkad natak, banners etc in the regional languages. Various components are available under the preventive measure. Firstly, the Hepatitis B immunization the birth dose was introduced in 2008 and was universalized in 2011. Even now some districts of western, south-eastern and central India have a very low HBV coverage3 which indirectly can contribute to high prevalence of hepatitis cases. To improve this, we should begin right from screening. Screening needs to be done at sub-center and primary health center using rapid test kits for ANC mothers, high risk population which includes person with multiple blood transfusions, hemodialysis patients, sexual partners of infected people, commercial sex workers, IV drug users, prisoners etc. For those whom the test turns positive appropriate referral to higher centers must be done for confirmation, counselling and prompt treatment. Here we could also reach out to Publicprivate partnerships to promote screening, reporting and surveillance. Non-Governmental Organizations and Peer groups can help promote behavioral change communication among the high-risk population to reduce the incidence, mortality and morbidity of hepatitis. Promoting institutional deliveries of all mothers so that their babies receive the immunization on time. A target to reach near 100% antenatal screening and care must be aimed at to reduce the incidence. Secondly moving on to safety of blood and blood products, there are plenty of strategies available, but the most important strategy for safe blood and blood products will be increasing voluntary blood donation. Reuse prevention of syringes was a critical intervention to prevent Hepatitis B and C transmission which needs to be continued strictly. Thirdly the hygiene and sanitation which is

Fig 1 — Modes of transmission of hepatitis viruses covered under the Swachh Bharat Mission in which initiatives were taken to control open defecation, provide safe drinking water, food hygiene by following the appropriate food safety guidelines, appropriate waste disposal etc. The efforts for the mentioned initiatives must be continues so as to achieve good sanitation and hygiene.
Among the above discussed major issues from the organized sector somehow, we forget to focus on the unorganized sectors like tattooing, religious rituals (mundans, ear and nose piercing), reuse of syringes (recently 30-40 school children in Madhya Pradesh were administered COVID vaccine using a single syringe4), barbers using common blades for beard grooming of customers etc because the risk of transmission in such areas could be really high. Charles Darwin had once stated that there was no country in the world that did not practice tattooing or some other form of permanent body decoration5. According to the history and culture, tattoos were used as symbols of shame and distinction (given for success or the passage into maturity). Tribals used tattoos to distinguish between friends and enemies and to signify age, marital status, authority, and class. Women’s tattoos were status markers in several tribes, ensuring that they were of no value to other tribes. But in recent years tattooing is becoming a fashion. Stating here some of the problems arising from these unorganized sectors such as they don’t have sufficient money to change blades for every customer or fear that their customers would stop coming to them if they charge more for the hair or beard grooming or have no sufficient time to look into the sterilization of instruments etc go unnoticed many a times. Initiatives need to be directed towards creating awareness about hepatitis and its transmission, training them on using cost effective ways of sterilizing instruments (using boiling water, disinfectants), providing them with instruments that can help them sterilize their blades/ instruments. If the set targets need to be achieved, we need to have some guidelines and checklist for the unorganized sectors like those for organized sectors because clearly the burden of hepatitis in the unorganized sectors is going unnoticed.
1Hepatitis [Internet]. [cited 2023 Jan 23]. Available from: https:/ /www.who.int/health-topics/hepatitis
2Hepatitis C [Internet]. [cited 2023 Jan 23]. Available from: https:/ /www.who.int/news-room/fact-sheets/detail/hepatitis-c
3Khan J, Shil A, Mohanty SK — Hepatitis B vaccination coverage across India: exploring the spatial heterogeneity and contextual determinants. BMC Public Health 2019; 19(1): 1263.
4Dwary A — He Vaccinated 40 Students With 1 Syringe, Then Asked ‘How Is It My Fault’. 2022 Jul 28; Available from: https:/ /www.ndtv.com/india-news/he-vaccinated-30-students-with-1syringe-then-said-how-is-it-my-fault-3200287
5A brief history of tattoos [Internet]. Wellcome Collection. [cited 2023 Jan 23]. Available from: https://wellcomecollection.org/ articles/W9m2QxcAAF8AFvE5.
1MBBS, Resident, Department of Prerna Verma1 Community Medicine, Dr DY Patil Medical College, Johnson S1 Hospital and Research Centre, Pune 411018 Deepu Palal1 2MBBS, Resident, Department of Microbiology Sahjid Mukhida2


